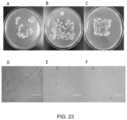
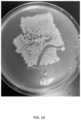

US11672265B2 - Egg replacement containing euglena-derived components - Google Patents
Egg replacement containing euglena-derived componentsDownload PDFInfo
- Publication number
- US11672265B2 US11672265B2US17/783,990US202017783990AUS11672265B2US 11672265 B2US11672265 B2US 11672265B2US 202017783990 AUS202017783990 AUS 202017783990AUS 11672265 B2US11672265 B2US 11672265B2
- Authority
- US
- United States
- Prior art keywords
- egg
- protein
- oil
- euglena
- amount
- Prior art date
- Legal status (The legal status is an assumption and is not a legal conclusion. Google has not performed a legal analysis and makes no representation as to the accuracy of the status listed.)
- Active
Links
- 241000195620EuglenaSpecies0.000titleclaimsdescription211
- 235000013601eggsNutrition0.000claimsabstractdescription986
- 239000000203mixtureSubstances0.000claimsabstractdescription626
- 235000013305foodNutrition0.000claimsabstractdescription98
- 235000018102proteinsNutrition0.000claimsdescription377
- 102000004169proteins and genesHuman genes0.000claimsdescription377
- 108090000623proteins and genesProteins0.000claimsdescription377
- 239000003921oilSubstances0.000claimsdescription172
- 239000002028BiomassSubstances0.000claimsdescription126
- XLYOFNOQVPJJNP-UHFFFAOYSA-NwaterSubstancesOXLYOFNOQVPJJNP-UHFFFAOYSA-N0.000claimsdescription117
- 239000004615ingredientSubstances0.000claimsdescription88
- 239000000843powderSubstances0.000claimsdescription76
- 239000000796flavoring agentSubstances0.000claimsdescription74
- 235000013312flourNutrition0.000claimsdescription73
- 108010084695Pea ProteinsProteins0.000claimsdescription70
- 235000019702pea proteinNutrition0.000claimsdescription70
- 235000019634flavorsNutrition0.000claimsdescription68
- 235000002639sodium chlorideNutrition0.000claimsdescription67
- 239000012141concentrateSubstances0.000claimsdescription66
- 239000000463materialSubstances0.000claimsdescription66
- 229920002148Gellan gumPolymers0.000claimsdescription65
- 235000010492gellan gumNutrition0.000claimsdescription64
- 239000000216gellan gumSubstances0.000claimsdescription64
- 150000003839saltsChemical class0.000claimsdescription56
- 229920000609methyl cellulosePolymers0.000claimsdescription54
- 235000010981methylcelluloseNutrition0.000claimsdescription54
- 239000001923methylcelluloseSubstances0.000claimsdescription54
- 235000002732Allium cepa var. cepaNutrition0.000claimsdescription48
- 241000234282AlliumSpecies0.000claimsdescription47
- 229940041514candida albicans extractDrugs0.000claimsdescription41
- 239000012138yeast extractSubstances0.000claimsdescription41
- 239000000416hydrocolloidSubstances0.000claimsdescription37
- 229920002498Beta-glucanPolymers0.000claimsdescription27
- FYGDTMLNYKFZSV-URKRLVJHSA-N(2s,3r,4s,5s,6r)-2-[(2r,4r,5r,6s)-4,5-dihydroxy-2-(hydroxymethyl)-6-[(2r,4r,5r,6s)-4,5,6-trihydroxy-2-(hydroxymethyl)oxan-3-yl]oxyoxan-3-yl]oxy-6-(hydroxymethyl)oxane-3,4,5-triolChemical compoundO[C@@H]1[C@@H](O)[C@H](O)[C@@H](CO)O[C@H]1OC1[C@@H](CO)O[C@@H](OC2[C@H](O[C@H](O)[C@H](O)[C@H]2O)CO)[C@H](O)[C@H]1OFYGDTMLNYKFZSV-URKRLVJHSA-N0.000claimsdescription24
- UIIMBOGNXHQVGW-UHFFFAOYSA-MSodium bicarbonateChemical compound[Na+].OC([O-])=OUIIMBOGNXHQVGW-UHFFFAOYSA-M0.000claimsdescription22
- 235000016709nutritionNutrition0.000claimsdescription17
- 235000001674Agaricus brunnescensNutrition0.000claimsdescription16
- 238000005273aerationMethods0.000claimsdescription16
- 238000005345coagulationMethods0.000claimsdescription16
- 230000015271coagulationEffects0.000claimsdescription16
- 108060008539TransglutaminaseProteins0.000claimsdescription15
- 102000003601transglutaminaseHuman genes0.000claimsdescription15
- 230000027455bindingEffects0.000claimsdescription14
- 239000000679carrageenanSubstances0.000claimsdescription14
- 229920001525carrageenanPolymers0.000claimsdescription14
- 229940113118carrageenanDrugs0.000claimsdescription14
- 240000002234Allium sativumSpecies0.000claimsdescription13
- 235000010418carrageenanNutrition0.000claimsdescription13
- 235000004611garlicNutrition0.000claimsdescription13
- UHVMMEOXYDMDKI-JKYCWFKZSA-Lzinc;1-(5-cyanopyridin-2-yl)-3-[(1s,2s)-2-(6-fluoro-2-hydroxy-3-propanoylphenyl)cyclopropyl]urea;diacetateChemical compound[Zn+2].CC([O-])=O.CC([O-])=O.CCC(=O)C1=CC=C(F)C([C@H]2[C@H](C2)NC(=O)NC=2N=CC(=CC=2)C#N)=C1OUHVMMEOXYDMDKI-JKYCWFKZSA-L0.000claimsdescription13
- 238000005187foamingMethods0.000claimsdescription12
- 235000010855food raising agentNutrition0.000claimsdescription12
- 238000001879gelationMethods0.000claimsdescription12
- 240000007594Oryza sativaSpecies0.000claimsdescription11
- 235000007164Oryza sativaNutrition0.000claimsdescription11
- FAPWRFPIFSIZLT-UHFFFAOYSA-MSodium chlorideChemical compound[Na+].[Cl-]FAPWRFPIFSIZLT-UHFFFAOYSA-M0.000claimsdescription11
- 150000001413amino acidsChemical class0.000claimsdescription11
- WQZGKKKJIJFFOK-VFUOTHLCSA-Nbeta-D-glucoseChemical compoundOC[C@H]1O[C@@H](O)[C@H](O)[C@@H](O)[C@@H]1OWQZGKKKJIJFFOK-VFUOTHLCSA-N0.000claimsdescription11
- 235000009566riceNutrition0.000claimsdescription11
- 235000017557sodium bicarbonateNutrition0.000claimsdescription11
- 229910000030sodium bicarbonateInorganic materials0.000claimsdescription11
- 239000011780sodium chlorideSubstances0.000claimsdescription11
- PYMYPHUHKUWMLA-UHFFFAOYSA-N2,3,4,5-tetrahydroxypentanalChemical compoundOCC(O)C(O)C(O)C=OPYMYPHUHKUWMLA-UHFFFAOYSA-N0.000claimsdescription10
- 229920002752KonjacPolymers0.000claimsdescription10
- 239000011230binding agentSubstances0.000claimsdescription10
- 238000004945emulsificationMethods0.000claimsdescription10
- 235000004426flaxseedNutrition0.000claimsdescription10
- 239000000252konjacSubstances0.000claimsdescription10
- 229920001285xanthan gumPolymers0.000claimsdescription10
- 235000010493xanthan gumNutrition0.000claimsdescription10
- 239000000230xanthan gumSubstances0.000claimsdescription10
- 229940082509xanthan gumDrugs0.000claimsdescription10
- 244000203593Piper nigrumSpecies0.000claimsdescription9
- 235000008184Piper nigrumNutrition0.000claimsdescription9
- 239000003963antioxidant agentSubstances0.000claimsdescription8
- 230000003078antioxidant effectEffects0.000claimsdescription8
- IIZPXYDJLKNOIY-JXPKJXOSSA-N1-palmitoyl-2-arachidonoyl-sn-glycero-3-phosphocholineChemical compoundCCCCCCCCCCCCCCCC(=O)OC[C@H](COP([O-])(=O)OCC[N+](C)(C)C)OC(=O)CCC\C=C/C\C=C/C\C=C/C\C=C/CCCCCIIZPXYDJLKNOIY-JXPKJXOSSA-N0.000claimsdescription7
- 235000003222Helianthus annuusNutrition0.000claimsdescription7
- ZNOZWUKQPJXOIG-XSBHQQIPSA-L[(2r,3s,4r,5r,6s)-6-[[(1r,3s,4r,5r,8s)-3,4-dihydroxy-2,6-dioxabicyclo[3.2.1]octan-8-yl]oxy]-4-[[(1r,3r,4r,5r,8s)-8-[(2s,3r,4r,5r,6r)-3,4-dihydroxy-6-(hydroxymethyl)-5-sulfonatooxyoxan-2-yl]oxy-4-hydroxy-2,6-dioxabicyclo[3.2.1]octan-3-yl]oxy]-5-hydroxy-2-(Chemical compoundO[C@@H]1[C@@H](O)[C@@H](OS([O-])(=O)=O)[C@@H](CO)O[C@H]1O[C@@H]1[C@@H]2OC[C@H]1O[C@H](O[C@H]1[C@H]([C@@H](CO)O[C@@H](O[C@@H]3[C@@H]4OC[C@H]3O[C@H](O)[C@@H]4O)[C@@H]1O)OS([O-])(=O)=O)[C@@H]2OZNOZWUKQPJXOIG-XSBHQQIPSA-L0.000claimsdescription7
- 239000003995emulsifying agentSubstances0.000claimsdescription7
- 235000010445lecithinNutrition0.000claimsdescription7
- 239000000787lecithinSubstances0.000claimsdescription7
- 229940067606lecithinDrugs0.000claimsdescription7
- 230000035764nutritionEffects0.000claimsdescription7
- 235000014698Brassica juncea var multisectaNutrition0.000claimsdescription6
- 235000006008Brassica napus var napusNutrition0.000claimsdescription6
- 235000006618Brassica rapa subsp oleiferaNutrition0.000claimsdescription6
- 235000004977Brassica sinapistrumNutrition0.000claimsdescription6
- 102000004190EnzymesHuman genes0.000claimsdescription6
- 108090000790EnzymesProteins0.000claimsdescription6
- 108010003571Nut ProteinsProteins0.000claimsdescription6
- 235000010627Phaseolus vulgarisNutrition0.000claimsdescription6
- 244000046052Phaseolus vulgarisSpecies0.000claimsdescription6
- 235000021307TriticumNutrition0.000claimsdescription6
- 235000013614black pepperNutrition0.000claimsdescription6
- -1flavoringSubstances0.000claimsdescription6
- MJYQFWSXKFLTAY-OVEQLNGDSA-N(2r,3r)-2,3-bis[(4-hydroxy-3-methoxyphenyl)methyl]butane-1,4-diol;(2r,3r,4s,5s,6r)-6-(hydroxymethyl)oxane-2,3,4,5-tetrolChemical compoundOC[C@H]1O[C@@H](O)[C@H](O)[C@@H](O)[C@@H]1O.C1=C(O)C(OC)=CC(C[C@@H](CO)[C@H](CO)CC=2C=C(OC)C(O)=CC=2)=C1MJYQFWSXKFLTAY-OVEQLNGDSA-N0.000claimsdescription5
- FHVDTGUDJYJELY-UHFFFAOYSA-N6-{[2-carboxy-4,5-dihydroxy-6-(phosphanyloxy)oxan-3-yl]oxy}-4,5-dihydroxy-3-phosphanyloxane-2-carboxylic acidChemical compoundO1C(C(O)=O)C(P)C(O)C(O)C1OC1C(C(O)=O)OC(OP)C(O)C1OFHVDTGUDJYJELY-UHFFFAOYSA-N0.000claimsdescription5
- 244000215068Acacia senegalSpecies0.000claimsdescription5
- 229920001817AgarPolymers0.000claimsdescription5
- 244000144725Amygdalus communisSpecies0.000claimsdescription5
- 235000011437Amygdalus communisNutrition0.000claimsdescription5
- 235000017060Arachis glabrataNutrition0.000claimsdescription5
- 244000105624Arachis hypogaeaSpecies0.000claimsdescription5
- 235000010777Arachis hypogaeaNutrition0.000claimsdescription5
- 235000018262Arachis monticolaNutrition0.000claimsdescription5
- 244000025254Cannabis sativaSpecies0.000claimsdescription5
- 235000012766Cannabis sativa ssp. sativa var. sativaNutrition0.000claimsdescription5
- 235000012765Cannabis sativa ssp. sativa var. spontaneaNutrition0.000claimsdescription5
- 229920002134Carboxymethyl cellulosePolymers0.000claimsdescription5
- 240000006162Chenopodium quinoaSpecies0.000claimsdescription5
- 239000001879CurdlanSubstances0.000claimsdescription5
- 229920002558CurdlanPolymers0.000claimsdescription5
- 102100028717Cytosolic 5'-nucleotidase 3AHuman genes0.000claimsdescription5
- 244000000626Daucus carotaSpecies0.000claimsdescription5
- 235000002767Daucus carotaNutrition0.000claimsdescription5
- 235000009419Fagopyrum esculentumNutrition0.000claimsdescription5
- 240000008620Fagopyrum esculentumSpecies0.000claimsdescription5
- 229920002907Guar gumPolymers0.000claimsdescription5
- 229920000084Gum arabicPolymers0.000claimsdescription5
- 241000219730Lathyrus aphacaSpecies0.000claimsdescription5
- 235000004431Linum usitatissimumNutrition0.000claimsdescription5
- 240000006240Linum usitatissimumSpecies0.000claimsdescription5
- 229920000161Locust bean gumPolymers0.000claimsdescription5
- 235000002595Solanum tuberosumNutrition0.000claimsdescription5
- 244000061456Solanum tuberosumSpecies0.000claimsdescription5
- 244000062793Sorghum vulgareSpecies0.000claimsdescription5
- 108010073771Soybean ProteinsProteins0.000claimsdescription5
- 235000010749Vicia fabaNutrition0.000claimsdescription5
- 240000006677Vicia fabaSpecies0.000claimsdescription5
- 235000002098Vicia faba var. majorNutrition0.000claimsdescription5
- 240000008042Zea maysSpecies0.000claimsdescription5
- 235000005824Zea mays ssp. parviglumisNutrition0.000claimsdescription5
- 235000002017Zea mays subsp maysNutrition0.000claimsdescription5
- 241000746966ZizaniaSpecies0.000claimsdescription5
- 235000002636Zizania aquaticaNutrition0.000claimsdescription5
- 235000010489acacia gumNutrition0.000claimsdescription5
- 239000000205acacia gumSubstances0.000claimsdescription5
- 239000008272agarSubstances0.000claimsdescription5
- 229940072056alginateDrugs0.000claimsdescription5
- 235000010443alginic acidNutrition0.000claimsdescription5
- 229920000615alginic acidPolymers0.000claimsdescription5
- 235000020224almondNutrition0.000claimsdescription5
- 235000009120camoNutrition0.000claimsdescription5
- 235000005607chanvre indienNutrition0.000claimsdescription5
- 235000020235chia seedNutrition0.000claimsdescription5
- 235000019705chickpea proteinNutrition0.000claimsdescription5
- 235000005822cornNutrition0.000claimsdescription5
- 235000019316curdlanNutrition0.000claimsdescription5
- 229940078035curdlanDrugs0.000claimsdescription5
- 239000000835fiberSubstances0.000claimsdescription5
- 235000010417guar gumNutrition0.000claimsdescription5
- 239000000665guar gumSubstances0.000claimsdescription5
- 229960002154guar gumDrugs0.000claimsdescription5
- 239000011487hempSubstances0.000claimsdescription5
- 235000019823konjac gumNutrition0.000claimsdescription5
- 235000021374legumesNutrition0.000claimsdescription5
- 235000019704lentil proteinNutrition0.000claimsdescription5
- 235000010420locust bean gumNutrition0.000claimsdescription5
- 239000000711locust bean gumSubstances0.000claimsdescription5
- 235000019713milletNutrition0.000claimsdescription5
- 235000019707mung bean proteinNutrition0.000claimsdescription5
- 235000020232peanutNutrition0.000claimsdescription5
- 229940001941soy proteinDrugs0.000claimsdescription5
- 230000003020moisturizing effectEffects0.000claimsdescription2
- 240000000385Brassica napus var. napusSpecies0.000claims1
- 244000020551Helianthus annuusSpecies0.000claims1
- 244000098338Triticum aestivumSpecies0.000claims1
- 239000007788liquidSubstances0.000abstractdescription380
- 238000009472formulationMethods0.000abstractdescription309
- 239000000839emulsionSubstances0.000abstractdescription96
- 235000019198oilsNutrition0.000description171
- 235000012970cakesNutrition0.000description70
- 235000008504concentrateNutrition0.000description65
- 239000000047productSubstances0.000description50
- 238000010411cookingMethods0.000description31
- 239000000499gelSubstances0.000description31
- 239000007787solidSubstances0.000description30
- NVNLLIYOARQCIX-MSHCCFNRSA-NNisinChemical compoundN1C(=O)[C@@H](CC(C)C)NC(=O)C(=C)NC(=O)[C@@H]([C@H](C)CC)NC(=O)[C@@H](NC(=O)C(=C/C)/NC(=O)[C@H](N)[C@H](C)CC)CSC[C@@H]1C(=O)N[C@@H]1C(=O)N2CCC[C@@H]2C(=O)NCC(=O)N[C@@H](C(=O)N[C@H](CCCCN)C(=O)N[C@@H]2C(NCC(=O)N[C@H](C)C(=O)N[C@H](CC(C)C)C(=O)N[C@H](CCSC)C(=O)NCC(=O)N[C@H](CS[C@@H]2C)C(=O)N[C@H](CC(N)=O)C(=O)N[C@H](CCSC)C(=O)N[C@H](CCCCN)C(=O)N[C@@H]2C(N[C@H](C)C(=O)N[C@@H]3C(=O)N[C@@H](C(N[C@H](CC=4NC=NC=4)C(=O)N[C@H](CS[C@@H]3C)C(=O)N[C@H](CO)C(=O)N[C@H]([C@H](C)CC)C(=O)N[C@H](CC=3NC=NC=3)C(=O)N[C@H](C(C)C)C(=O)NC(=C)C(=O)N[C@H](CCCCN)C(O)=O)=O)CS[C@@H]2C)=O)=O)CS[C@@H]1CNVNLLIYOARQCIX-MSHCCFNRSA-N0.000description29
- 108010053775NisinProteins0.000description29
- 239000004309nisinSubstances0.000description29
- 235000010297nisinNutrition0.000description29
- 238000000034methodMethods0.000description28
- 239000006071creamSubstances0.000description23
- 238000003860storageMethods0.000description23
- 244000299461Theobroma cacaoSpecies0.000description21
- 235000013351cheeseNutrition0.000description19
- 235000015243ice creamNutrition0.000description19
- 239000000523sampleSubstances0.000description19
- 235000000346sugarNutrition0.000description18
- 235000019640tasteNutrition0.000description18
- 239000003925fatSubstances0.000description16
- 235000019197fatsNutrition0.000description16
- 235000015927pastaNutrition0.000description16
- 239000004599antimicrobialSubstances0.000description15
- 150000001720carbohydratesChemical class0.000description15
- 235000014633carbohydratesNutrition0.000description15
- 235000013336milkNutrition0.000description14
- 239000008267milkSubstances0.000description14
- 210000004080milkAnatomy0.000description14
- 238000003756stirringMethods0.000description14
- 235000009337Spinacia oleraceaNutrition0.000description13
- 235000019219chocolateNutrition0.000description13
- 238000010438heat treatmentMethods0.000description13
- 239000000126substanceSubstances0.000description13
- 235000021388linseed oilNutrition0.000description12
- 239000000944linseed oilSubstances0.000description12
- 230000000813microbial effectEffects0.000description12
- 239000010466nut oilSubstances0.000description12
- 235000005713safflower oilNutrition0.000description12
- 239000003813safflower oilSubstances0.000description12
- 238000012360testing methodMethods0.000description12
- 235000007688Lycopersicon esculentumNutrition0.000description11
- 235000014680Saccharomyces cerevisiaeNutrition0.000description11
- 240000003768Solanum lycopersicumSpecies0.000description11
- 235000019486Sunflower oilNutrition0.000description11
- 239000002600sunflower oilSubstances0.000description11
- 229940024606amino acidDrugs0.000description10
- 235000001014amino acidNutrition0.000description10
- 235000011950custardNutrition0.000description10
- ZAASRHQPRFFWCS-UHFFFAOYSA-Pdiazanium;oxygen(2-);uraniumChemical compound[NH4+].[NH4+].[O-2].[O-2].[O-2].[O-2].[O-2].[O-2].[O-2].[U].[U]ZAASRHQPRFFWCS-UHFFFAOYSA-P0.000description10
- 150000002632lipidsChemical class0.000description10
- 235000012771pancakesNutrition0.000description10
- 238000009928pasteurizationMethods0.000description10
- 229940005741sunflower lecithinDrugs0.000description10
- 235000007319Avena orientalisNutrition0.000description9
- 244000075850Avena orientalisSpecies0.000description9
- 241000894006BacteriaSpecies0.000description9
- 235000013162Cocos nuciferaNutrition0.000description9
- 244000060011Cocos nuciferaSpecies0.000description9
- HEMHJVSKTPXQMS-UHFFFAOYSA-MSodium hydroxideChemical compound[OH-].[Na+]HEMHJVSKTPXQMS-UHFFFAOYSA-M0.000description9
- 235000008429breadNutrition0.000description9
- 235000013311vegetablesNutrition0.000description9
- 235000009470Theobroma cacaoNutrition0.000description8
- 235000021152breakfastNutrition0.000description8
- 230000000694effectsEffects0.000description8
- 230000001804emulsifying effectEffects0.000description8
- 238000004519manufacturing processMethods0.000description8
- 244000005700microbiomeSpecies0.000description8
- 235000015112vegetable and seed oilNutrition0.000description8
- 239000008158vegetable oilSubstances0.000description8
- 235000019482Palm oilNutrition0.000description7
- 240000004808Saccharomyces cerevisiaeSpecies0.000description7
- 241000219315SpinaciaSpecies0.000description7
- 244000300264Spinacia oleraceaSpecies0.000description7
- 238000004458analytical methodMethods0.000description7
- 235000006708antioxidantsNutrition0.000description7
- 235000021028berryNutrition0.000description7
- 239000002540palm oilSubstances0.000description7
- 230000001953sensory effectEffects0.000description7
- 239000003381stabilizerSubstances0.000description7
- AJBZENLMTKDAEK-UHFFFAOYSA-N3a,5a,5b,8,8,11a-hexamethyl-1-prop-1-en-2-yl-1,2,3,4,5,6,7,7a,9,10,11,11b,12,13,13a,13b-hexadecahydrocyclopenta[a]chrysene-4,9-diolChemical compoundCC12CCC(O)C(C)(C)C1CCC(C1(C)CC3O)(C)C2CCC1C1C3(C)CCC1C(=C)CAJBZENLMTKDAEK-UHFFFAOYSA-N0.000description6
- 244000226021Anacardium occidentaleSpecies0.000description6
- 235000007558Avena spNutrition0.000description6
- 235000012284Bertholletia excelsaNutrition0.000description6
- 244000205479Bertholletia excelsaSpecies0.000description6
- 235000003880CalendulaNutrition0.000description6
- 240000001432Calendula officinalisSpecies0.000description6
- 244000197813Camelina sativaSpecies0.000description6
- 235000014595Camelina sativaNutrition0.000description6
- 241000195493CryptophytaSpecies0.000description6
- 241000219992CupheaSpecies0.000description6
- 241000196324EmbryophytaSpecies0.000description6
- 241000221079Euphorbia <genus>Species0.000description6
- WQZGKKKJIJFFOK-GASJEMHNSA-NGlucoseNatural productsOC[C@H]1OC(O)[C@H](O)[C@@H](O)[C@@H]1OWQZGKKKJIJFFOK-GASJEMHNSA-N0.000description6
- 235000019487Hazelnut oilNutrition0.000description6
- 241000208818HelianthusSpecies0.000description6
- 240000000797Hibiscus cannabinusSpecies0.000description6
- 241000221089JatrophaSpecies0.000description6
- 241000219745LupinusSpecies0.000description6
- 235000019493Macadamia oilNutrition0.000description6
- 240000001090Papaver somniferumSpecies0.000description6
- 235000019483Peanut oilNutrition0.000description6
- 235000019495Pecan oilNutrition0.000description6
- XBDQKXXYIPTUBI-UHFFFAOYSA-MPropionateChemical compoundCCC([O-])=OXBDQKXXYIPTUBI-UHFFFAOYSA-M0.000description6
- 235000019484Rapeseed oilNutrition0.000description6
- 235000019774Rice Bran oilNutrition0.000description6
- 240000000528Ricinus communisSpecies0.000description6
- 235000004443Ricinus communisNutrition0.000description6
- 235000019485Safflower oilNutrition0.000description6
- 235000009499Vanilla fragransNutrition0.000description6
- 235000012036Vanilla tahitensisNutrition0.000description6
- 240000001866Vernicia fordiiSpecies0.000description6
- 238000010521absorption reactionMethods0.000description6
- ZOJBYZNEUISWFT-UHFFFAOYSA-Nallyl isothiocyanateChemical compoundC=CCN=C=SZOJBYZNEUISWFT-UHFFFAOYSA-N0.000description6
- 235000021302avocado oilNutrition0.000description6
- 239000008163avocado oilSubstances0.000description6
- 235000014121butterNutrition0.000description6
- 239000010495camellia oilSubstances0.000description6
- 235000019519canola oilNutrition0.000description6
- 239000000828canola oilSubstances0.000description6
- 235000020226cashew nutNutrition0.000description6
- 210000000991chicken eggAnatomy0.000description6
- 235000019864coconut oilNutrition0.000description6
- 239000003240coconut oilSubstances0.000description6
- 239000010635coffee oilSubstances0.000description6
- 239000010636coriander oilSubstances0.000description6
- 235000005687corn oilNutrition0.000description6
- 239000002285corn oilSubstances0.000description6
- 235000012343cottonseed oilNutrition0.000description6
- 239000002385cottonseed oilSubstances0.000description6
- 239000008121dextroseSubstances0.000description6
- 235000021323fish oilNutrition0.000description6
- 238000011194good manufacturing practiceMethods0.000description6
- 239000008169grapeseed oilSubstances0.000description6
- 239000010468hazelnut oilSubstances0.000description6
- 239000010460hemp oilSubstances0.000description6
- 229940119170jojoba waxDrugs0.000description6
- 239000010469macadamia oilSubstances0.000description6
- 235000019508mustard seedNutrition0.000description6
- 235000008390olive oilNutrition0.000description6
- 239000004006olive oilSubstances0.000description6
- 239000003346palm kernel oilSubstances0.000description6
- 235000019865palm kernel oilNutrition0.000description6
- 235000006502papoulaNutrition0.000description6
- 239000000312peanut oilSubstances0.000description6
- 239000010470pecan oilSubstances0.000description6
- 239000008171pumpkin seed oilSubstances0.000description6
- 239000008165rice bran oilSubstances0.000description6
- 235000011803sesame oilNutrition0.000description6
- 239000008159sesame oilSubstances0.000description6
- WXMKPNITSTVMEF-UHFFFAOYSA-Msodium benzoateChemical compound[Na+].[O-]C(=O)C1=CC=CC=C1WXMKPNITSTVMEF-UHFFFAOYSA-M0.000description6
- 239000000243solutionSubstances0.000description6
- 235000012424soybean oilNutrition0.000description6
- 239000003549soybean oilSubstances0.000description6
- 229940088594vitaminDrugs0.000description6
- 229930003231vitaminNatural products0.000description6
- 235000013343vitaminNutrition0.000description6
- 239000011782vitaminSubstances0.000description6
- CHHHXKFHOYLYRE-UHFFFAOYSA-M2,4-Hexadienoic acid, potassium salt (1:1), (2E,4E)-Chemical compound[K+].CC=CC=CC([O-])=OCHHHXKFHOYLYRE-UHFFFAOYSA-M0.000description5
- 244000247812Amorphophallus rivieriSpecies0.000description5
- 235000001206Amorphophallus rivieriNutrition0.000description5
- 244000188595Brassica sinapistrumSpecies0.000description5
- 241000287828Gallus gallusSpecies0.000description5
- 241000209140TriticumSpecies0.000description5
- 244000263375Vanilla tahitensisSpecies0.000description5
- 230000033228biological regulationEffects0.000description5
- 235000021450burritoNutrition0.000description5
- 235000009508confectioneryNutrition0.000description5
- 238000011161developmentMethods0.000description5
- 235000013355food flavoring agentNutrition0.000description5
- 235000010485konjacNutrition0.000description5
- 235000013372meatNutrition0.000description5
- 238000001000micrographMethods0.000description5
- 238000002156mixingMethods0.000description5
- 239000004302potassium sorbateSubstances0.000description5
- 235000010241potassium sorbateNutrition0.000description5
- 229940069338potassium sorbateDrugs0.000description5
- 230000008569processEffects0.000description5
- 230000002829reductive effectEffects0.000description5
- 239000004299sodium benzoateSubstances0.000description5
- 235000010234sodium benzoateNutrition0.000description5
- 235000013599spicesNutrition0.000description5
- GHOKWGTUZJEAQD-ZETCQYMHSA-N(D)-(+)-Pantothenic acidChemical compoundOCC(C)(C)[C@@H](O)C(=O)NCCC(O)=OGHOKWGTUZJEAQD-ZETCQYMHSA-N0.000description4
- 241000208140AcerSpecies0.000description4
- 244000223760Cinnamomum zeylanicumSpecies0.000description4
- 241000195619Euglena gracilisSpecies0.000description4
- 241000233866FungiSpecies0.000description4
- XEEYBQQBJWHFJM-UHFFFAOYSA-NIronChemical compound[Fe]XEEYBQQBJWHFJM-UHFFFAOYSA-N0.000description4
- 235000008673Persea americanaNutrition0.000description4
- 244000025272Persea americanaSpecies0.000description4
- 241000657513Senna surattensisSpecies0.000description4
- 244000223014Syzygium aromaticumSpecies0.000description4
- 235000016639Syzygium aromaticumNutrition0.000description4
- 229930003316Vitamin DNatural products0.000description4
- QYSXJUFSXHHAJI-XFEUOLMDSA-NVitamin D3Natural productsC1(/[C@@H]2CC[C@@H]([C@]2(CCC1)C)[C@H](C)CCCC(C)C)=C/C=C1\C[C@@H](O)CCC1=CQYSXJUFSXHHAJI-XFEUOLMDSA-N0.000description4
- 230000000845anti-microbial effectEffects0.000description4
- 235000015173baked goods and baking mixesNutrition0.000description4
- 230000008901benefitEffects0.000description4
- 235000017803cinnamonNutrition0.000description4
- 235000013365dairy productNutrition0.000description4
- 238000011049fillingMethods0.000description4
- 239000004519greaseSubstances0.000description4
- 230000006872improvementEffects0.000description4
- 229910052500inorganic mineralInorganic materials0.000description4
- 235000010755mineralNutrition0.000description4
- 239000011707mineralSubstances0.000description4
- 230000007935neutral effectEffects0.000description4
- LXNHXLLTXMVWPM-UHFFFAOYSA-NpyridoxineChemical compoundCC1=NC=C(CO)C(CO)=C1OLXNHXLLTXMVWPM-UHFFFAOYSA-N0.000description4
- 230000009467reductionEffects0.000description4
- 238000012546transferMethods0.000description4
- 235000019583umami tasteNutrition0.000description4
- 235000019166vitamin DNutrition0.000description4
- 239000011710vitamin DSubstances0.000description4
- 150000003710vitamin D derivativesChemical class0.000description4
- 229940046008vitamin dDrugs0.000description4
- GVJHHUAWPYXKBD-UHFFFAOYSA-N(±)-α-TocopherolChemical compoundOC1=C(C)C(C)=C2OC(CCCC(C)CCCC(C)CCCC(C)C)(C)CCC2=C1CGVJHHUAWPYXKBD-UHFFFAOYSA-N0.000description3
- FPIPGXGPPPQFEQ-UHFFFAOYSA-N13-cis retinolNatural productsOCC=C(C)C=CC=C(C)C=CC1=C(C)CCCC1(C)CFPIPGXGPPPQFEQ-UHFFFAOYSA-N0.000description3
- 241000538571BrachydeuterusSpecies0.000description3
- BCZXFFBUYPCTSJ-UHFFFAOYSA-LCalcium propionateChemical compound[Ca+2].CCC([O-])=O.CCC([O-])=OBCZXFFBUYPCTSJ-UHFFFAOYSA-L0.000description3
- 235000002566CapsicumNutrition0.000description3
- GHOKWGTUZJEAQD-UHFFFAOYSA-NChick antidermatitis factorNatural productsOCC(C)(C)C(O)C(=O)NCCC(O)=OGHOKWGTUZJEAQD-UHFFFAOYSA-N0.000description3
- 102000002322Egg ProteinsHuman genes0.000description3
- 108010000912Egg ProteinsProteins0.000description3
- LFQSCWFLJHTTHZ-UHFFFAOYSA-NEthanolChemical compoundCCOLFQSCWFLJHTTHZ-UHFFFAOYSA-N0.000description3
- 244000285963Kluyveromyces fragilisSpecies0.000description3
- 235000014663Kluyveromyces fragilisNutrition0.000description3
- 241001465754MetazoaSpecies0.000description3
- 239000006002PepperSubstances0.000description3
- 235000016761Piper aduncumNutrition0.000description3
- 235000017804Piper guineenseNutrition0.000description3
- 108010064851Plant ProteinsProteins0.000description3
- AUNGANRZJHBGPY-SCRDCRAPSA-NRiboflavinChemical compoundOC[C@@H](O)[C@@H](O)[C@@H](O)CN1C=2C=C(C)C(C)=CC=2N=C2C1=NC(=O)NC2=OAUNGANRZJHBGPY-SCRDCRAPSA-N0.000description3
- FPIPGXGPPPQFEQ-BOOMUCAASA-NVitamin ANatural productsOC/C=C(/C)\C=C\C=C(\C)/C=C/C1=C(C)CCCC1(C)CFPIPGXGPPPQFEQ-BOOMUCAASA-N0.000description3
- 230000009471actionEffects0.000description3
- FPIPGXGPPPQFEQ-OVSJKPMPSA-Nall-trans-retinolChemical compoundOC\C=C(/C)\C=C\C=C(/C)\C=C\C1=C(C)CCCC1(C)CFPIPGXGPPPQFEQ-OVSJKPMPSA-N0.000description3
- 238000013459approachMethods0.000description3
- 239000004330calcium propionateSubstances0.000description3
- 235000010331calcium propionateNutrition0.000description3
- 229920002678cellulosePolymers0.000description3
- 239000001913celluloseSubstances0.000description3
- KRKNYBCHXYNGOX-UHFFFAOYSA-Ncitric acidChemical compoundOC(=O)CC(O)(C(O)=O)CC(O)=OKRKNYBCHXYNGOX-UHFFFAOYSA-N0.000description3
- FDJOLVPMNUYSCM-WZHZPDAFSA-Lcobalt(3+);[(2r,3s,4r,5s)-5-(5,6-dimethylbenzimidazol-1-yl)-4-hydroxy-2-(hydroxymethyl)oxolan-3-yl] [(2r)-1-[3-[(1r,2r,3r,4z,7s,9z,12s,13s,14z,17s,18s,19r)-2,13,18-tris(2-amino-2-oxoethyl)-7,12,17-tris(3-amino-3-oxopropyl)-3,5,8,8,13,15,18,19-octamethyl-2Chemical compound[Co+3].N#[C-].N([C@@H]([C@]1(C)[N-]\C([C@H]([C@@]1(CC(N)=O)C)CCC(N)=O)=C(\C)/C1=N/C([C@H]([C@@]1(CC(N)=O)C)CCC(N)=O)=C\C1=N\C([C@H](C1(C)C)CCC(N)=O)=C/1C)[C@@H]2CC(N)=O)=C\1[C@]2(C)CCC(=O)NC[C@@H](C)OP([O-])(=O)O[C@H]1[C@@H](O)[C@@H](N2C3=CC(C)=C(C)C=C3N=C2)O[C@@H]1COFDJOLVPMNUYSCM-WZHZPDAFSA-L0.000description3
- 239000003086colorantSubstances0.000description3
- 235000014510cookyNutrition0.000description3
- 230000000875corresponding effectEffects0.000description3
- 235000014113dietary fatty acidsNutrition0.000description3
- BNIILDVGGAEEIG-UHFFFAOYSA-Ldisodium hydrogen phosphateChemical compound[Na+].[Na+].OP([O-])([O-])=OBNIILDVGGAEEIG-UHFFFAOYSA-L0.000description3
- 229910000397disodium phosphateInorganic materials0.000description3
- 235000019800disodium phosphateNutrition0.000description3
- 238000002474experimental methodMethods0.000description3
- 239000000194fatty acidSubstances0.000description3
- 229930195729fatty acidNatural products0.000description3
- 150000004665fatty acidsChemical class0.000description3
- 239000012530fluidSubstances0.000description3
- 230000036571hydrationEffects0.000description3
- 238000006703hydration reactionMethods0.000description3
- 230000003993interactionEffects0.000description3
- 230000033001locomotionEffects0.000description3
- 230000000873masking effectEffects0.000description3
- 235000010746mayonnaiseNutrition0.000description3
- 239000008268mayonnaiseSubstances0.000description3
- 235000012459muffinsNutrition0.000description3
- 235000019645odorNutrition0.000description3
- 239000002245particleSubstances0.000description3
- 235000021118plant-derived proteinNutrition0.000description3
- 238000002360preparation methodMethods0.000description3
- 239000001488sodium phosphateSubstances0.000description3
- 241000894007speciesSpecies0.000description3
- 238000006467substitution reactionMethods0.000description3
- 235000020357syrupNutrition0.000description3
- 239000006188syrupSubstances0.000description3
- 235000019155vitamin ANutrition0.000description3
- 239000011719vitamin ASubstances0.000description3
- 229940045997vitamin aDrugs0.000description3
- 235000012773wafflesNutrition0.000description3
- IXPNQXFRVYWDDI-UHFFFAOYSA-N1-methyl-2,4-dioxo-1,3-diazinane-5-carboximidamideChemical compoundCN1CC(C(N)=N)C(=O)NC1=OIXPNQXFRVYWDDI-UHFFFAOYSA-N0.000description2
- 241000251468ActinopterygiiSpecies0.000description2
- 241001499808Allium atrorubensSpecies0.000description2
- CIWBSHSKHKDKBQ-JLAZNSOCSA-NAscorbic acidChemical compoundOC[C@H](O)[C@H]1OC(=O)C(O)=C1OCIWBSHSKHKDKBQ-JLAZNSOCSA-N0.000description2
- 241000538568Brachydeuterus auritusSpecies0.000description2
- 241000219198BrassicaSpecies0.000description2
- 235000003351Brassica creticaNutrition0.000description2
- 235000003343Brassica rupestrisNutrition0.000description2
- OYPRJOBELJOOCE-UHFFFAOYSA-NCalciumChemical compound[Ca]OYPRJOBELJOOCE-UHFFFAOYSA-N0.000description2
- 235000008534Capsicum annuum var annuumNutrition0.000description2
- CURLTUGMZLYLDI-UHFFFAOYSA-NCarbon dioxideChemical compoundO=C=OCURLTUGMZLYLDI-UHFFFAOYSA-N0.000description2
- 235000005979Citrus limonNutrition0.000description2
- 244000131522Citrus pyriformisSpecies0.000description2
- 241000282412HomoSpecies0.000description2
- DGAQECJNVWCQMB-PUAWFVPOSA-MIlexoside XXIXChemical compoundC[C@@H]1CC[C@@]2(CC[C@@]3(C(=CC[C@H]4[C@]3(CC[C@@H]5[C@@]4(CC[C@@H](C5(C)C)OS(=O)(=O)[O-])C)C)[C@@H]2[C@]1(C)O)C)C(=O)O[C@H]6[C@@H]([C@H]([C@@H]([C@H](O6)CO)O)O)O.[Na+]DGAQECJNVWCQMB-PUAWFVPOSA-M0.000description2
- 240000008415Lactuca sativaSpecies0.000description2
- FYYHWMGAXLPEAU-UHFFFAOYSA-NMagnesiumChemical compound[Mg]FYYHWMGAXLPEAU-UHFFFAOYSA-N0.000description2
- 208000002720MalnutritionDiseases0.000description2
- PVNIIMVLHYAWGP-UHFFFAOYSA-NNiacinChemical compoundOC(=O)C1=CC=CN=C1PVNIIMVLHYAWGP-UHFFFAOYSA-N0.000description2
- OAICVXFJPJFONN-UHFFFAOYSA-NPhosphorusChemical compound[P]OAICVXFJPJFONN-UHFFFAOYSA-N0.000description2
- ZLMJMSJWJFRBEC-UHFFFAOYSA-NPotassiumChemical compound[K]ZLMJMSJWJFRBEC-UHFFFAOYSA-N0.000description2
- 244000178231Rosmarinus officinalisSpecies0.000description2
- NINIDFKCEFEMDL-UHFFFAOYSA-NSulfurChemical compound[S]NINIDFKCEFEMDL-UHFFFAOYSA-N0.000description2
- 240000002657Thymus vulgarisSpecies0.000description2
- 235000007303Thymus vulgarisNutrition0.000description2
- ATJFFYVFTNAWJD-UHFFFAOYSA-NTinChemical compound[Sn]ATJFFYVFTNAWJD-UHFFFAOYSA-N0.000description2
- HCHKCACWOHOZIP-UHFFFAOYSA-NZincChemical compound[Zn]HCHKCACWOHOZIP-UHFFFAOYSA-N0.000description2
- 235000021120animal proteinNutrition0.000description2
- QKSKPIVNLNLAAV-UHFFFAOYSA-Nbis(2-chloroethyl) sulfideChemical compoundClCCSCCClQKSKPIVNLNLAAV-UHFFFAOYSA-N0.000description2
- 239000011575calciumSubstances0.000description2
- 229910052791calciumInorganic materials0.000description2
- 238000009924canningMethods0.000description2
- 210000004027cellAnatomy0.000description2
- 235000013339cerealsNutrition0.000description2
- HVYWMOMLDIMFJA-DPAQBDIFSA-NcholesterolChemical compoundC1C=C2C[C@@H](O)CC[C@]2(C)[C@@H]2[C@@H]1[C@@H]1CC[C@H]([C@H](C)CCCC(C)C)[C@@]1(C)CC2HVYWMOMLDIMFJA-DPAQBDIFSA-N0.000description2
- 230000003749cleanlinessEffects0.000description2
- 239000011248coating agentSubstances0.000description2
- 238000000576coating methodMethods0.000description2
- 238000011109contaminationMethods0.000description2
- 238000001816coolingMethods0.000description2
- 239000013256coordination polymerSubstances0.000description2
- 230000002596correlated effectEffects0.000description2
- 239000002537cosmeticSubstances0.000description2
- 230000001351cycling effectEffects0.000description2
- 230000034994deathEffects0.000description2
- 231100000517deathToxicity0.000description2
- GHVNFZFCNZKVNT-UHFFFAOYSA-Ndecanoic acidChemical compoundCCCCCCCCCC(O)=OGHVNFZFCNZKVNT-UHFFFAOYSA-N0.000description2
- 238000004925denaturationMethods0.000description2
- 230000036425denaturationEffects0.000description2
- 235000021185dessertNutrition0.000description2
- 235000021245dietary proteinNutrition0.000description2
- 235000015872dietary supplementNutrition0.000description2
- 201000010099diseaseDiseases0.000description2
- 208000037265diseases, disorders, signs and symptomsDiseases0.000description2
- 239000006185dispersionSubstances0.000description2
- POULHZVOKOAJMA-UHFFFAOYSA-Ndodecanoic acidChemical compoundCCCCCCCCCCCC(O)=OPOULHZVOKOAJMA-UHFFFAOYSA-N0.000description2
- 239000003814drugSubstances0.000description2
- 229940079593drugDrugs0.000description2
- 235000013399edible fruitsNutrition0.000description2
- 238000005516engineering processMethods0.000description2
- 235000020776essential amino acidNutrition0.000description2
- 239000003797essential amino acidSubstances0.000description2
- 235000020774essential nutrientsNutrition0.000description2
- 239000000284extractSubstances0.000description2
- 239000012467final productSubstances0.000description2
- 239000006260foamSubstances0.000description2
- 239000011888foilSubstances0.000description2
- OVBPIULPVIDEAO-LBPRGKRZSA-Nfolic acidChemical compoundC=1N=C2NC(N)=NC(=O)C2=NC=1CNC1=CC=C(C(=O)N[C@@H](CCC(O)=O)C(O)=O)C=C1OVBPIULPVIDEAO-LBPRGKRZSA-N0.000description2
- 235000012041food componentNutrition0.000description2
- 239000005417food ingredientSubstances0.000description2
- 235000011389fruit/vegetable juiceNutrition0.000description2
- 230000005484gravityEffects0.000description2
- 238000003306harvestingMethods0.000description2
- FUZZWVXGSFPDMH-UHFFFAOYSA-Nhexanoic acidChemical compoundCCCCCC(O)=OFUZZWVXGSFPDMH-UHFFFAOYSA-N0.000description2
- 238000010348incorporationMethods0.000description2
- 229910052742ironInorganic materials0.000description2
- 239000011777magnesiumSubstances0.000description2
- 229910052749magnesiumInorganic materials0.000description2
- 239000002075main ingredientSubstances0.000description2
- 238000012423maintenanceMethods0.000description2
- 230000001071malnutritionEffects0.000description2
- 235000000824malnutritionNutrition0.000description2
- 230000018984masticationEffects0.000description2
- 238000010077masticationMethods0.000description2
- 238000005259measurementMethods0.000description2
- 229940057917medium chain triglyceridesDrugs0.000description2
- 238000002844meltingMethods0.000description2
- 230000008018meltingEffects0.000description2
- 125000002496methyl groupChemical group[H]C([H])([H])*0.000description2
- 238000007431microscopic evaluationMethods0.000description2
- 230000003278mimic effectEffects0.000description2
- 235000016337monopotassium tartrateNutrition0.000description2
- 235000010460mustardNutrition0.000description2
- 239000013642negative controlSubstances0.000description2
- 229960003512nicotinic acidDrugs0.000description2
- 235000012149noodlesNutrition0.000description2
- 208000015380nutritional deficiency diseaseDiseases0.000description2
- 230000000050nutritive effectEffects0.000description2
- 235000014571nutsNutrition0.000description2
- 235000020660omega-3 fatty acidNutrition0.000description2
- 150000007524organic acidsChemical class0.000description2
- 235000005985organic acidsNutrition0.000description2
- 238000004806packaging method and processMethods0.000description2
- 235000019161pantothenic acidNutrition0.000description2
- 239000011713pantothenic acidSubstances0.000description2
- 229940055726pantothenic acidDrugs0.000description2
- 239000000123paperSubstances0.000description2
- 235000010987pectinNutrition0.000description2
- 239000001814pectinSubstances0.000description2
- 229920001277pectinPolymers0.000description2
- 229960000292pectinDrugs0.000description2
- 239000011574phosphorusSubstances0.000description2
- 229910052698phosphorusInorganic materials0.000description2
- 230000000704physical effectEffects0.000description2
- 238000007747platingMethods0.000description2
- 239000011591potassiumSubstances0.000description2
- 229910052700potassiumInorganic materials0.000description2
- KYKNRZGSIGMXFH-ZVGUSBNCSA-Mpotassium bitartrateChemical compound[K+].OC(=O)[C@H](O)[C@@H](O)C([O-])=OKYKNRZGSIGMXFH-ZVGUSBNCSA-M0.000description2
- 238000003825pressingMethods0.000description2
- 230000002265preventionEffects0.000description2
- 235000011835quichesNutrition0.000description2
- 230000001105regulatory effectEffects0.000description2
- 238000011160researchMethods0.000description2
- 230000004044responseEffects0.000description2
- 235000012045saladNutrition0.000description2
- 235000015067saucesNutrition0.000description2
- 238000004904shorteningMethods0.000description2
- 239000011734sodiumSubstances0.000description2
- 229910052708sodiumInorganic materials0.000description2
- 235000010413sodium alginateNutrition0.000description2
- 239000000661sodium alginateSubstances0.000description2
- 229940005550sodium alginateDrugs0.000description2
- 239000002904solventSubstances0.000description2
- 235000014347soupsNutrition0.000description2
- 238000001694spray dryingMethods0.000description2
- 239000011593sulfurSubstances0.000description2
- 229910052717sulfurInorganic materials0.000description2
- 239000006228supernatantSubstances0.000description2
- 229960003495thiamineDrugs0.000description2
- 239000001585thymus vulgarisSubstances0.000description2
- 235000012184tortillaNutrition0.000description2
- 229940011671vitamin b6Drugs0.000description2
- 238000005406washingMethods0.000description2
- 239000002699waste materialSubstances0.000description2
- 235000008939whole milkNutrition0.000description2
- 239000011701zincSubstances0.000description2
- 229910052725zincInorganic materials0.000description2
- GJJVAFUKOBZPCB-ZGRPYONQSA-N(r)-3,4-dihydro-2-methyl-2-(4,8,12-trimethyl-3,7,11-tridecatrienyl)-2h-1-benzopyran-6-olChemical classOC1=CC=C2OC(CC/C=C(C)/CC/C=C(C)/CCC=C(C)C)(C)CCC2=C1GJJVAFUKOBZPCB-ZGRPYONQSA-N0.000description1
- QCVGEOXPDFCNHA-UHFFFAOYSA-N5,5-dimethyl-2,4-dioxo-1,3-oxazolidine-3-carboxamideChemical compoundCC1(C)OC(=O)N(C(N)=O)C1=OQCVGEOXPDFCNHA-UHFFFAOYSA-N0.000description1
- UHPMCKVQTMMPCG-UHFFFAOYSA-N5,8-dihydroxy-2-methoxy-6-methyl-7-(2-oxopropyl)naphthalene-1,4-dioneChemical compoundCC1=C(CC(C)=O)C(O)=C2C(=O)C(OC)=CC(=O)C2=C1OUHPMCKVQTMMPCG-UHFFFAOYSA-N0.000description1
- YBJHBAHKTGYVGT-OOZYFLPDSA-N5-[(3as,4r,6ar)-2-oxohexahydro-1h-thieno[3,4-d]imidazol-4-yl]pentanoic acidChemical compoundN1C(=O)N[C@@H]2[C@@H](CCCCC(=O)O)SC[C@@H]21YBJHBAHKTGYVGT-OOZYFLPDSA-N0.000description1
- 241001133794Acoelorraphe wrightiiSpecies0.000description1
- 108010001949Algal ProteinsProteins0.000description1
- 235000001270Allium sibiricumNutrition0.000description1
- 235000010585Ammi visnagaNutrition0.000description1
- 244000153158Ammi visnagaSpecies0.000description1
- 241000272525Anas platyrhynchosSpecies0.000description1
- 241000272814Anser sp.Species0.000description1
- 241000205585Aquilegia canadensisSpecies0.000description1
- 235000005340Asparagus officinalisNutrition0.000description1
- 241000228212AspergillusSpecies0.000description1
- 241000003595Aurantiochytrium limacinumSpecies0.000description1
- 241000271566AvesSpecies0.000description1
- 235000011299Brassica oleracea var botrytisNutrition0.000description1
- 235000017647Brassica oleracea var italicaNutrition0.000description1
- 244000308180Brassica oleracea var. italicaSpecies0.000description1
- UXVMQQNJUSDDNG-UHFFFAOYSA-LCalcium chlorideChemical compound[Cl-].[Cl-].[Ca+2]UXVMQQNJUSDDNG-UHFFFAOYSA-L0.000description1
- 239000005632Capric acid (CAS 334-48-5)Substances0.000description1
- 240000004160Capsicum annuumSpecies0.000description1
- 241001107116Castanospermum australeSpecies0.000description1
- 241000195649Chlorella <Chlorellales>Species0.000description1
- 241000497235Chlorella lewiniiSpecies0.000description1
- 241000075116Chlorella pituitaSpecies0.000description1
- 241000497276Chlorella pulchelloidesSpecies0.000description1
- 244000249214Chlorella pyrenoidosaSpecies0.000description1
- 235000007091Chlorella pyrenoidosaNutrition0.000description1
- 241000404551Chlorella rotundaSpecies0.000description1
- 241000404554Chlorella singularisSpecies0.000description1
- 241000195654Chlorella sorokinianaSpecies0.000description1
- 241000497271Chlorella variabilisSpecies0.000description1
- 241000404556Chlorella volutisSpecies0.000description1
- 240000009108Chlorella vulgarisSpecies0.000description1
- 235000007089Chlorella vulgarisNutrition0.000description1
- 235000010652Chlorella vulgaris var autotrophicaNutrition0.000description1
- 240000000862Chlorella vulgaris var. autotrophicaSpecies0.000description1
- VEXZGXHMUGYJMC-UHFFFAOYSA-MChloride anionChemical compound[Cl-]VEXZGXHMUGYJMC-UHFFFAOYSA-M0.000description1
- VYZAMTAEIAYCRO-UHFFFAOYSA-NChromiumChemical compound[Cr]VYZAMTAEIAYCRO-UHFFFAOYSA-N0.000description1
- 235000010523Cicer arietinumNutrition0.000description1
- 244000045195Cicer arietinumSpecies0.000description1
- 235000008733Citrus aurantifoliaNutrition0.000description1
- RYGMFSIKBFXOCR-UHFFFAOYSA-NCopperChemical compound[Cu]RYGMFSIKBFXOCR-UHFFFAOYSA-N0.000description1
- 244000018436Coriandrum sativumSpecies0.000description1
- 241001137251CorvidaeSpecies0.000description1
- AUNGANRZJHBGPY-UHFFFAOYSA-ND-LyxoflavinNatural productsOCC(O)C(O)C(O)CN1C=2C=C(C)C(C)=CC=2N=C2C1=NC(=O)NC2=OAUNGANRZJHBGPY-UHFFFAOYSA-N0.000description1
- ZZZCUOFIHGPKAK-UHFFFAOYSA-ND-erythro-ascorbic acidNatural productsOCC1OC(=O)C(O)=C1OZZZCUOFIHGPKAK-UHFFFAOYSA-N0.000description1
- 108010010256Dietary ProteinsProteins0.000description1
- 102000015781Dietary ProteinsHuman genes0.000description1
- 240000002943Elettaria cardamomumSpecies0.000description1
- 241000873463Euglena adhaerensSpecies0.000description1
- 241000412808Euglena cantabricaSpecies0.000description1
- 241000040870Euglena chlamydophoraSpecies0.000description1
- 241001595355Euglena claraSpecies0.000description1
- 241001595359Euglena communisSpecies0.000description1
- 241000936932Euglena desesSpecies0.000description1
- 241001595357Euglena deses var. intermediaSpecies0.000description1
- 241001517206Euglena geniculataSpecies0.000description1
- 241000982757Euglena granulataSpecies0.000description1
- 241000845748Euglena magnificaSpecies0.000description1
- 241001517208Euglena mutabilisSpecies0.000description1
- 241001517063Euglena pisciformisSpecies0.000description1
- 241000340521Euglena polymorphaSpecies0.000description1
- 241000886681Euglena sanguineaSpecies0.000description1
- 241000859797Euglena splendensSpecies0.000description1
- 241000412807Euglena terricolaSpecies0.000description1
- 241000239917Euglena velataSpecies0.000description1
- 241001223004Euglenaformis proximaSpecies0.000description1
- 241001517212Euglenaria anabaenaSpecies0.000description1
- 241000845734Euglenaria caudataSpecies0.000description1
- 241000722016Euglenaria clavataSpecies0.000description1
- 239000004606Fillers/ExtendersSubstances0.000description1
- KRHYYFGTRYWZRS-UHFFFAOYSA-MFluoride anionChemical compound[F-]KRHYYFGTRYWZRS-UHFFFAOYSA-M0.000description1
- 241000223218FusariumSpecies0.000description1
- 108010068370GlutensProteins0.000description1
- 206010020751HypersensitivityDiseases0.000description1
- HNDVDQJCIGZPNO-YFKPBYRVSA-NL-histidineChemical compoundOC(=O)[C@@H](N)CC1=CN=CN1HNDVDQJCIGZPNO-YFKPBYRVSA-N0.000description1
- AGPKZVBTJJNPAG-WHFBIAKZSA-NL-isoleucineChemical compoundCC[C@H](C)[C@H](N)C(O)=OAGPKZVBTJJNPAG-WHFBIAKZSA-N0.000description1
- ROHFNLRQFUQHCH-YFKPBYRVSA-NL-leucineChemical compoundCC(C)C[C@H](N)C(O)=OROHFNLRQFUQHCH-YFKPBYRVSA-N0.000description1
- KDXKERNSBIXSRK-YFKPBYRVSA-NL-lysineChemical compoundNCCCC[C@H](N)C(O)=OKDXKERNSBIXSRK-YFKPBYRVSA-N0.000description1
- FFEARJCKVFRZRR-BYPYZUCNSA-NL-methionineChemical compoundCSCC[C@H](N)C(O)=OFFEARJCKVFRZRR-BYPYZUCNSA-N0.000description1
- COLNVLDHVKWLRT-QMMMGPOBSA-NL-phenylalanineChemical compoundOC(=O)[C@@H](N)CC1=CC=CC=C1COLNVLDHVKWLRT-QMMMGPOBSA-N0.000description1
- AYFVYJQAPQTCCC-GBXIJSLDSA-NL-threonineChemical compoundC[C@@H](O)[C@H](N)C(O)=OAYFVYJQAPQTCCC-GBXIJSLDSA-N0.000description1
- QIVBCDIJIAJPQS-VIFPVBQESA-NL-tryptophaneChemical compoundC1=CC=C2C(C[C@H](N)C(O)=O)=CNC2=C1QIVBCDIJIAJPQS-VIFPVBQESA-N0.000description1
- KZSNJWFQEVHDMF-BYPYZUCNSA-NL-valineChemical compoundCC(C)[C@H](N)C(O)=OKZSNJWFQEVHDMF-BYPYZUCNSA-N0.000description1
- 239000005639Lauric acidSubstances0.000description1
- 241001208438Lepocinclis acusSpecies0.000description1
- 241001543773Lepocinclis oxyurisSpecies0.000description1
- 241000948815Lepocinclis tripterisSpecies0.000description1
- ROHFNLRQFUQHCH-UHFFFAOYSA-NLeucineNatural productsCC(C)CC(N)C(O)=OROHFNLRQFUQHCH-UHFFFAOYSA-N0.000description1
- KDXKERNSBIXSRK-UHFFFAOYSA-NLysineNatural productsNCCCCC(N)C(O)=OKDXKERNSBIXSRK-UHFFFAOYSA-N0.000description1
- 239000004472LysineSubstances0.000description1
- 101710137760Malonyl-CoA-acyl carrier protein transacylase, mitochondrialProteins0.000description1
- 241000288147Meleagris gallopavoSpecies0.000description1
- 235000006679Mentha X verticillataNutrition0.000description1
- 235000002899Mentha suaveolensNutrition0.000description1
- 235000001636Mentha x rotundifoliaNutrition0.000description1
- 235000005135Micromeria julianaNutrition0.000description1
- ZOKXTWBITQBERF-UHFFFAOYSA-NMolybdenumChemical compound[Mo]ZOKXTWBITQBERF-UHFFFAOYSA-N0.000description1
- 240000005561Musa balbisianaSpecies0.000description1
- 241000195659Neodesmus pupukensisSpecies0.000description1
- 235000000380Nyssa aquaticaNutrition0.000description1
- 240000005295Nyssa aquaticaSpecies0.000description1
- 235000008098Oxalis acetosellaNutrition0.000description1
- 240000007930Oxalis acetosellaSpecies0.000description1
- 229920002984ParamylonPolymers0.000description1
- 235000010240Paullinia pinnataNutrition0.000description1
- 244000264897Persea americana var. americanaSpecies0.000description1
- 241001595203Phacus limnophilaSpecies0.000description1
- 241000286209PhasianidaeSpecies0.000description1
- 102100030944Protein-glutamine gamma-glutamyltransferase KHuman genes0.000description1
- 241000607142SalmonellaSpecies0.000description1
- 235000007315Satureja hortensisNutrition0.000description1
- 240000002114Satureja hortensisSpecies0.000description1
- 241000233673Schizochytrium aggregatumSpecies0.000description1
- 241000003597Schizochytrium minutumSpecies0.000description1
- 241000245026Scoliopus bigeloviiSpecies0.000description1
- BUGBHKTXTAQXES-UHFFFAOYSA-NSeleniumChemical compound[Se]BUGBHKTXTAQXES-UHFFFAOYSA-N0.000description1
- 229920002472StarchPolymers0.000description1
- 241000272534Struthio camelusSpecies0.000description1
- JZRWCGZRTZMZEH-UHFFFAOYSA-NThiamineNatural productsCC1=C(CCO)SC=[N+]1CC1=CN=C(C)N=C1NJZRWCGZRTZMZEH-UHFFFAOYSA-N0.000description1
- AYFVYJQAPQTCCC-UHFFFAOYSA-NThreonineNatural productsCC(O)C(N)C(O)=OAYFVYJQAPQTCCC-UHFFFAOYSA-N0.000description1
- 239000004473ThreonineSubstances0.000description1
- 235000011941Tilia x europaeaNutrition0.000description1
- QIVBCDIJIAJPQS-UHFFFAOYSA-NTryptophanNatural productsC1=CC=C2C(CC(N)C(O)=O)=CNC2=C1QIVBCDIJIAJPQS-UHFFFAOYSA-N0.000description1
- KZSNJWFQEVHDMF-UHFFFAOYSA-NValineNatural productsCC(C)C(N)C(O)=OKZSNJWFQEVHDMF-UHFFFAOYSA-N0.000description1
- 244000290333Vanilla fragransSpecies0.000description1
- 229930003451Vitamin B1Natural products0.000description1
- 229930003779Vitamin B12Natural products0.000description1
- 229930003537Vitamin B3Natural products0.000description1
- 229930003571Vitamin B5Natural products0.000description1
- 229930003761Vitamin B9Natural products0.000description1
- 229930003268Vitamin CNatural products0.000description1
- 229930003427Vitamin ENatural products0.000description1
- 229930003448Vitamin KNatural products0.000description1
- 108010046377Whey ProteinsProteins0.000description1
- 244000273928Zingiber officinaleSpecies0.000description1
- 235000006886Zingiber officinaleNutrition0.000description1
- 230000004308accommodationEffects0.000description1
- 239000002253acidSubstances0.000description1
- 230000002378acidificating effectEffects0.000description1
- 230000004913activationEffects0.000description1
- 239000000853adhesiveSubstances0.000description1
- 230000001070adhesive effectEffects0.000description1
- 244000193174agaveSpecies0.000description1
- 125000001931aliphatic groupChemical group0.000description1
- 208000026935allergic diseaseDiseases0.000description1
- 230000007815allergyEffects0.000description1
- 229910052782aluminiumInorganic materials0.000description1
- XAGFODPZIPBFFR-UHFFFAOYSA-NaluminiumChemical compound[Al]XAGFODPZIPBFFR-UHFFFAOYSA-N0.000description1
- 230000003178anti-diabetic effectEffects0.000description1
- 239000007864aqueous solutionSubstances0.000description1
- 235000019568aromasNutrition0.000description1
- 238000003556assayMethods0.000description1
- 230000001651autotrophic effectEffects0.000description1
- 235000021015bananasNutrition0.000description1
- 235000015278beefNutrition0.000description1
- 235000013361beverageNutrition0.000description1
- 230000015572biosynthetic processEffects0.000description1
- 235000021279black beanNutrition0.000description1
- 238000009835boilingMethods0.000description1
- 235000012467browniesNutrition0.000description1
- 230000005587bubblingEffects0.000description1
- 239000006227byproductSubstances0.000description1
- 235000012839cake mixesNutrition0.000description1
- FAPWYRCQGJNNSJ-UBKPKTQASA-Lcalcium D-pantothenic acidChemical compound[Ca+2].OCC(C)(C)[C@@H](O)C(=O)NCCC([O-])=O.OCC(C)(C)[C@@H](O)C(=O)NCCC([O-])=OFAPWYRCQGJNNSJ-UBKPKTQASA-L0.000description1
- 239000001110calcium chlorideSubstances0.000description1
- 229910001628calcium chlorideInorganic materials0.000description1
- 229960002079calcium pantothenateDrugs0.000description1
- 235000019577caloric intakeNutrition0.000description1
- 125000004432carbon atomChemical groupC*0.000description1
- 239000001569carbon dioxideSubstances0.000description1
- 229910002092carbon dioxideInorganic materials0.000description1
- 235000005300cardamomoNutrition0.000description1
- 238000005119centrifugationMethods0.000description1
- 238000006243chemical reactionMethods0.000description1
- 239000003795chemical substances by applicationSubstances0.000description1
- 230000001055chewing effectEffects0.000description1
- 239000008370chocolate flavorSubstances0.000description1
- 235000012000cholesterolNutrition0.000description1
- OEYIOHPDSNJKLS-UHFFFAOYSA-NcholineChemical compoundC[N+](C)(C)CCOOEYIOHPDSNJKLS-UHFFFAOYSA-N0.000description1
- 229960001231cholineDrugs0.000description1
- 238000004587chromatography analysisMethods0.000description1
- 229910052804chromiumInorganic materials0.000description1
- 239000011651chromiumSubstances0.000description1
- 229940095714cider vinegarDrugs0.000description1
- 229910017052cobaltInorganic materials0.000description1
- 239000010941cobaltSubstances0.000description1
- GUTLYIVDDKVIGB-UHFFFAOYSA-Ncobalt atomChemical compound[Co]GUTLYIVDDKVIGB-UHFFFAOYSA-N0.000description1
- 150000001875compoundsChemical class0.000description1
- 238000007906compressionMethods0.000description1
- 230000006835compressionEffects0.000description1
- 235000013409condimentsNutrition0.000description1
- 238000010276constructionMethods0.000description1
- 229910052802copperInorganic materials0.000description1
- 239000010949copperSubstances0.000description1
- 235000019221dark chocolateNutrition0.000description1
- 230000003247decreasing effectEffects0.000description1
- 230000007547defectEffects0.000description1
- 238000013461designMethods0.000description1
- 230000006866deteriorationEffects0.000description1
- 238000011981development testMethods0.000description1
- 235000005911dietNutrition0.000description1
- 230000037213dietEffects0.000description1
- 235000020805dietary restrictionsNutrition0.000description1
- 238000009826distributionMethods0.000description1
- 235000012489doughnutsNutrition0.000description1
- 210000000969egg whiteAnatomy0.000description1
- 235000014103egg whiteNutrition0.000description1
- 210000002969egg yolkAnatomy0.000description1
- 235000013345egg yolkNutrition0.000description1
- 230000007613environmental effectEffects0.000description1
- 235000004626essential fatty acidsNutrition0.000description1
- 210000003527eukaryotic cellAnatomy0.000description1
- 230000006355external stressEffects0.000description1
- 230000002349favourable effectEffects0.000description1
- 238000000855fermentationMethods0.000description1
- 230000004151fermentationEffects0.000description1
- 210000003495flagellaAnatomy0.000description1
- 229940014144folateDrugs0.000description1
- 235000019152folic acidNutrition0.000description1
- 239000011724folic acidSubstances0.000description1
- 235000002864food coloring agentNutrition0.000description1
- 235000011194food seasoning agentNutrition0.000description1
- 235000021393food securityNutrition0.000description1
- 235000003599food sweetenerNutrition0.000description1
- 238000005755formation reactionMethods0.000description1
- 235000021022fresh fruitsNutrition0.000description1
- 235000011494fruit snacksNutrition0.000description1
- 235000013376functional foodNutrition0.000description1
- 230000002538fungal effectEffects0.000description1
- WIGCFUFOHFEKBI-UHFFFAOYSA-Ngamma-tocopherolNatural productsCC(C)CCCC(C)CCCC(C)CCCC1CCC2C(C)C(O)C(C)C(C)C2O1WIGCFUFOHFEKBI-UHFFFAOYSA-N0.000description1
- 229940029982garlic powderDrugs0.000description1
- 235000021189garnishesNutrition0.000description1
- 235000008397gingerNutrition0.000description1
- 239000011521glassSubstances0.000description1
- 235000021312glutenNutrition0.000description1
- 235000015220hamburgersNutrition0.000description1
- 230000036541healthEffects0.000description1
- 230000007407health benefitEffects0.000description1
- 229910001385heavy metalInorganic materials0.000description1
- 230000002443hepatoprotective effectEffects0.000description1
- 235000008216herbsNutrition0.000description1
- HNDVDQJCIGZPNO-UHFFFAOYSA-NhistidineNatural productsOC(=O)C(N)CC1=CN=CN1HNDVDQJCIGZPNO-UHFFFAOYSA-N0.000description1
- 239000008240homogeneous mixtureSubstances0.000description1
- 230000000887hydrating effectEffects0.000description1
- 238000013095identification testingMethods0.000description1
- 230000036039immunityEffects0.000description1
- 210000004283incisorAnatomy0.000description1
- 230000000266injurious effectEffects0.000description1
- 230000009878intermolecular interactionEffects0.000description1
- PNDPGZBMCMUPRI-UHFFFAOYSA-NiodineChemical compoundIIPNDPGZBMCMUPRI-UHFFFAOYSA-N0.000description1
- AGPKZVBTJJNPAG-UHFFFAOYSA-NisoleucineNatural productsCCC(C)C(N)C(O)=OAGPKZVBTJJNPAG-UHFFFAOYSA-N0.000description1
- 229960000310isoleucineDrugs0.000description1
- 235000015110jelliesNutrition0.000description1
- 239000008274jellySubstances0.000description1
- 239000006193liquid solutionSubstances0.000description1
- 235000020978long-chain polyunsaturated fatty acidsNutrition0.000description1
- 210000003712lysosomeAnatomy0.000description1
- 230000001868lysosomic effectEffects0.000description1
- WPBNNNQJVZRUHP-UHFFFAOYSA-Lmanganese(2+);methyl n-[[2-(methoxycarbonylcarbamothioylamino)phenyl]carbamothioyl]carbamate;n-[2-(sulfidocarbothioylamino)ethyl]carbamodithioateChemical compound[Mn+2].[S-]C(=S)NCCNC([S-])=S.COC(=O)NC(=S)NC1=CC=CC=C1NC(=S)NC(=O)OCWPBNNNQJVZRUHP-UHFFFAOYSA-L0.000description1
- 239000011159matrix materialSubstances0.000description1
- 235000015255meat loafNutrition0.000description1
- 230000007246mechanismEffects0.000description1
- 239000000155meltSubstances0.000description1
- 229930182817methionineNatural products0.000description1
- 210000003470mitochondriaAnatomy0.000description1
- 229910052750molybdenumInorganic materials0.000description1
- 239000011733molybdenumSubstances0.000description1
- 235000001968nicotinic acidNutrition0.000description1
- 239000011664nicotinic acidSubstances0.000description1
- DFPAKSUCGFBDDF-UHFFFAOYSA-Nnicotinic acid amideNatural productsNC(=O)C1=CC=CN=C1DFPAKSUCGFBDDF-UHFFFAOYSA-N0.000description1
- 210000004940nucleusAnatomy0.000description1
- 239000002417nutraceuticalSubstances0.000description1
- 235000021436nutraceutical agentNutrition0.000description1
- 235000015097nutrientsNutrition0.000description1
- WWZKQHOCKIZLMA-UHFFFAOYSA-Noctanoic acidChemical compoundCCCCCCCC(O)=OWWZKQHOCKIZLMA-UHFFFAOYSA-N0.000description1
- 244000080466oignonSpecies0.000description1
- 235000021315omega 9 monounsaturated fatty acidsNutrition0.000description1
- 229940012843omega-3 fatty acidDrugs0.000description1
- 239000006014omega-3 oilSubstances0.000description1
- 235000020665omega-6 fatty acidNutrition0.000description1
- 229940033080omega-6 fatty acidDrugs0.000description1
- 238000012856packingMethods0.000description1
- 210000003254palateAnatomy0.000description1
- 239000011088parchment paperSubstances0.000description1
- 235000014594pastriesNutrition0.000description1
- COLNVLDHVKWLRT-UHFFFAOYSA-NphenylalanineNatural productsOC(=O)C(N)CC1=CC=CC=C1COLNVLDHVKWLRT-UHFFFAOYSA-N0.000description1
- SHUZOJHMOBOZST-UHFFFAOYSA-NphylloquinoneNatural productsCC(C)CCCCC(C)CCC(C)CCCC(=CCC1=C(C)C(=O)c2ccccc2C1=O)CSHUZOJHMOBOZST-UHFFFAOYSA-N0.000description1
- 235000015108piesNutrition0.000description1
- 235000013550pizzaNutrition0.000description1
- 239000004033plasticSubstances0.000description1
- 235000020777polyunsaturated fatty acidsNutrition0.000description1
- 244000144977poultrySpecies0.000description1
- 238000001556precipitationMethods0.000description1
- 239000003755preservative agentSubstances0.000description1
- 239000006041probioticSubstances0.000description1
- 230000000529probiotic effectEffects0.000description1
- 235000018291probioticsNutrition0.000description1
- 235000021251pulsesNutrition0.000description1
- RADKZDMFGJYCBB-UHFFFAOYSA-Npyridoxal hydrochlorideNatural productsCC1=NC=C(CO)C(C=O)=C1ORADKZDMFGJYCBB-UHFFFAOYSA-N0.000description1
- 235000008160pyridoxineNutrition0.000description1
- 239000011677pyridoxineSubstances0.000description1
- 238000003908quality control methodMethods0.000description1
- 230000005855radiationEffects0.000description1
- 239000013074reference sampleSubstances0.000description1
- 230000000717retained effectEffects0.000description1
- 239000002151riboflavinSubstances0.000description1
- 229960002477riboflavinDrugs0.000description1
- 235000019192riboflavinNutrition0.000description1
- 235000014438salad dressingsNutrition0.000description1
- 210000003296salivaAnatomy0.000description1
- 238000005070samplingMethods0.000description1
- 238000011012sanitizationMethods0.000description1
- 238000007790scrapingMethods0.000description1
- 229910052711seleniumInorganic materials0.000description1
- 239000011669seleniumSubstances0.000description1
- 238000000926separation methodMethods0.000description1
- 230000009919sequestrationEffects0.000description1
- 239000002453shampooSubstances0.000description1
- 235000012025side saladNutrition0.000description1
- 235000019698starchNutrition0.000description1
- 230000001954sterilising effectEffects0.000description1
- 238000004659sterilization and disinfectionMethods0.000description1
- 239000000725suspensionSubstances0.000description1
- 230000009747swallowingEffects0.000description1
- 239000003765sweetening agentSubstances0.000description1
- 239000011721thiamineSubstances0.000description1
- 235000019157thiamineNutrition0.000description1
- KYMBYSLLVAOCFI-UHFFFAOYSA-NthiamineChemical compoundCC1=C(CCO)SCN1CC1=CN=C(C)N=C1NKYMBYSLLVAOCFI-UHFFFAOYSA-N0.000description1
- DPJRMOMPQZCRJU-UHFFFAOYSA-Mthiamine hydrochlorideChemical compoundCl.[Cl-].CC1=C(CCO)SC=[N+]1CC1=CN=C(C)N=C1NDPJRMOMPQZCRJU-UHFFFAOYSA-M0.000description1
- 230000008719thickeningEffects0.000description1
- 239000011732tocopherolSubstances0.000description1
- 229930003799tocopherolNatural products0.000description1
- 229960001295tocopherolDrugs0.000description1
- 235000010384tocopherolNutrition0.000description1
- 239000011731tocotrienolSubstances0.000description1
- 229930003802tocotrienolNatural products0.000description1
- 235000019148tocotrienolsNutrition0.000description1
- 229940068778tocotrienolsDrugs0.000description1
- 238000012549trainingMethods0.000description1
- 108010058734transglutaminase 1Proteins0.000description1
- 230000007704transitionEffects0.000description1
- 150000003626triacylglycerolsChemical class0.000description1
- 239000004474valineSubstances0.000description1
- 235000019723vegetarian productNutrition0.000description1
- 239000000052vinegarSubstances0.000description1
- 235000021419vinegarNutrition0.000description1
- 235000010374vitamin B1Nutrition0.000description1
- 239000011691vitamin B1Substances0.000description1
- 235000019163vitamin B12Nutrition0.000description1
- 239000011715vitamin B12Substances0.000description1
- 235000019160vitamin B3Nutrition0.000description1
- 239000011708vitamin B3Substances0.000description1
- 235000009492vitamin B5Nutrition0.000description1
- 239000011675vitamin B5Substances0.000description1
- 235000019158vitamin B6Nutrition0.000description1
- 239000011726vitamin B6Substances0.000description1
- 235000019159vitamin B9Nutrition0.000description1
- 239000011727vitamin B9Substances0.000description1
- 235000019154vitamin CNutrition0.000description1
- 239000011718vitamin CSubstances0.000description1
- 235000019165vitamin ENutrition0.000description1
- 239000011709vitamin ESubstances0.000description1
- 229940046009vitamin EDrugs0.000description1
- 235000019168vitamin KNutrition0.000description1
- 239000011712vitamin KSubstances0.000description1
- 150000003721vitamin K derivativesChemical class0.000description1
- 150000003722vitamin derivativesChemical class0.000description1
- 229940046010vitamin kDrugs0.000description1
- 235000021119whey proteinNutrition0.000description1
- 230000002087whitening effectEffects0.000description1
- 235000013618yogurtNutrition0.000description1
- GVJHHUAWPYXKBD-IEOSBIPESA-Nα-tocopherolChemical compoundOC1=C(C)C(C)=C2O[C@@](CCC[C@H](C)CCC[C@H](C)CCCC(C)C)(C)CCC2=C1CGVJHHUAWPYXKBD-IEOSBIPESA-N0.000description1
Images
Classifications
- A—HUMAN NECESSITIES
- A23—FOODS OR FOODSTUFFS; TREATMENT THEREOF, NOT COVERED BY OTHER CLASSES
- A23L—FOODS, FOODSTUFFS OR NON-ALCOHOLIC BEVERAGES, NOT OTHERWISE PROVIDED FOR; PREPARATION OR TREATMENT THEREOF
- A23L15/00—Egg products; Preparation or treatment thereof
- A23L15/35—Egg substitutes
- A—HUMAN NECESSITIES
- A23—FOODS OR FOODSTUFFS; TREATMENT THEREOF, NOT COVERED BY OTHER CLASSES
- A23J—PROTEIN COMPOSITIONS FOR FOODSTUFFS; WORKING-UP PROTEINS FOR FOODSTUFFS; PHOSPHATIDE COMPOSITIONS FOR FOODSTUFFS
- A23J1/00—Obtaining protein compositions for foodstuffs; Bulk opening of eggs and separation of yolks from whites
- A23J1/12—Obtaining protein compositions for foodstuffs; Bulk opening of eggs and separation of yolks from whites from cereals, wheat, bran, or molasses
- A—HUMAN NECESSITIES
- A23—FOODS OR FOODSTUFFS; TREATMENT THEREOF, NOT COVERED BY OTHER CLASSES
- A23J—PROTEIN COMPOSITIONS FOR FOODSTUFFS; WORKING-UP PROTEINS FOR FOODSTUFFS; PHOSPHATIDE COMPOSITIONS FOR FOODSTUFFS
- A23J1/00—Obtaining protein compositions for foodstuffs; Bulk opening of eggs and separation of yolks from whites
- A23J1/14—Obtaining protein compositions for foodstuffs; Bulk opening of eggs and separation of yolks from whites from leguminous or other vegetable seeds; from press-cake or oil-bearing seeds
- A—HUMAN NECESSITIES
- A23—FOODS OR FOODSTUFFS; TREATMENT THEREOF, NOT COVERED BY OTHER CLASSES
- A23J—PROTEIN COMPOSITIONS FOR FOODSTUFFS; WORKING-UP PROTEINS FOR FOODSTUFFS; PHOSPHATIDE COMPOSITIONS FOR FOODSTUFFS
- A23J3/00—Working-up of proteins for foodstuffs
- A23J3/14—Vegetable proteins
- A—HUMAN NECESSITIES
- A23—FOODS OR FOODSTUFFS; TREATMENT THEREOF, NOT COVERED BY OTHER CLASSES
- A23J—PROTEIN COMPOSITIONS FOR FOODSTUFFS; WORKING-UP PROTEINS FOR FOODSTUFFS; PHOSPHATIDE COMPOSITIONS FOR FOODSTUFFS
- A23J3/00—Working-up of proteins for foodstuffs
- A23J3/20—Proteins from microorganisms or unicellular algae
- A—HUMAN NECESSITIES
- A23—FOODS OR FOODSTUFFS; TREATMENT THEREOF, NOT COVERED BY OTHER CLASSES
- A23L—FOODS, FOODSTUFFS OR NON-ALCOHOLIC BEVERAGES, NOT OTHERWISE PROVIDED FOR; PREPARATION OR TREATMENT THEREOF
- A23L33/00—Modifying nutritive qualities of foods; Dietetic products; Preparation or treatment thereof
- A23L33/10—Modifying nutritive qualities of foods; Dietetic products; Preparation or treatment thereof using additives
- A—HUMAN NECESSITIES
- A23—FOODS OR FOODSTUFFS; TREATMENT THEREOF, NOT COVERED BY OTHER CLASSES
- A23L—FOODS, FOODSTUFFS OR NON-ALCOHOLIC BEVERAGES, NOT OTHERWISE PROVIDED FOR; PREPARATION OR TREATMENT THEREOF
- A23L33/00—Modifying nutritive qualities of foods; Dietetic products; Preparation or treatment thereof
- A23L33/10—Modifying nutritive qualities of foods; Dietetic products; Preparation or treatment thereof using additives
- A23L33/17—Amino acids, peptides or proteins
- A23L33/185—Vegetable proteins
- A—HUMAN NECESSITIES
- A23—FOODS OR FOODSTUFFS; TREATMENT THEREOF, NOT COVERED BY OTHER CLASSES
- A23L—FOODS, FOODSTUFFS OR NON-ALCOHOLIC BEVERAGES, NOT OTHERWISE PROVIDED FOR; PREPARATION OR TREATMENT THEREOF
- A23L33/00—Modifying nutritive qualities of foods; Dietetic products; Preparation or treatment thereof
- A23L33/10—Modifying nutritive qualities of foods; Dietetic products; Preparation or treatment thereof using additives
- A23L33/17—Amino acids, peptides or proteins
- A23L33/195—Proteins from microorganisms
- C—CHEMISTRY; METALLURGY
- C12—BIOCHEMISTRY; BEER; SPIRITS; WINE; VINEGAR; MICROBIOLOGY; ENZYMOLOGY; MUTATION OR GENETIC ENGINEERING
- C12N—MICROORGANISMS OR ENZYMES; COMPOSITIONS THEREOF; PROPAGATING, PRESERVING, OR MAINTAINING MICROORGANISMS; MUTATION OR GENETIC ENGINEERING; CULTURE MEDIA
- C12N1/00—Microorganisms, e.g. protozoa; Compositions thereof; Processes of propagating, maintaining or preserving microorganisms or compositions thereof; Processes of preparing or isolating a composition containing a microorganism; Culture media therefor
- C12N1/12—Unicellular algae; Culture media therefor
Definitions
- Embodiments described hereinare directed to a dry egg replacement composition comprising about 10% to about 98% Euglena -derived material, about 10% to about 85% pea protein, and one or more additional ingredient, wherein the dry egg replacement composition comprises one or more functional property of a natural egg.
- Embodiments described hereinare directed to an egg replacement emulsion comprising a dry egg replacement composition, an oil, and water.
- Embodiments described hereinare directed to a liquid egg comprising a dry egg replacement composition, an oil, and water.
- Embodiments described hereinare directed to methods of preparing an egg scramble comprising combining a dry egg replacement mix, an oil, and water.
- Embodiments described hereinare directed to a liquid egg formulation comprising about 50% to about 85% fresh Euglena -derived material, about 5% to about 10% pea protein, and one or more additional ingredient, wherein the liquid egg formulation comprises one or more functional property of a natural egg.
- Embodiments described hereinare directed to a liquid egg formulation comprising about 12% to about 95% Euglena -derived wet protein concentrate, about 1% to about 20% solid content, and one or more additional ingredient, wherein the liquid egg formulation comprises one or more functional property of a natural egg.
- Embodiments described hereinare directed to various food applications wherein the dry egg replacement composition, the egg replacement emulsion, liquid egg, or liquid egg formulation has been incorporated into edible egg-free scrambled eggs, egg-free patty, egg-free frittata, egg-free chocolate cake, egg-free pound cake, egg-free angel food cake, egg-free yellow cake, egg- and dairy-free cream cheese, egg-free pasta dough, egg-free custard, egg-free ice cream, and dairy-free milk.
- FIG. 1shows an early prototype of the development of the egg replacement.
- FIG. 2represents an intermediate prototype of the development of the egg replacement.
- FIG. 3shows the egg replacement described herein prepared as an egg scramble having the consistency, color, taste and nutritional profile of a natural egg.
- FIG. 4shows an image of scrambled egg cooked using liquid egg prepared with formula 1 shown in Table 13.
- FIG. 5shows an image of scrambled egg cooked using liquid egg formulated using formula shown in Table 14.
- FIG. 6shows an image of scrambled egg cooked using liquid egg formulated using formula shown in Table 15
- FIG. 7shows an egg cooked using liquid egg formulated using protein concentrate with 5 w/w % solid content
- FIG. 8shows a cooked liquid egg prepared using Euglena protein concentrate with 15 w/w % solid content.
- FIG. 9shows TSA plates of fresh biomass at pH 7 stored at 30° C. for 2 days.
- the sampleswere plated: A) before at 0 hours, B) 3 hours of storage in the refrigerator C) 6 hours of storage in the refrigerator and D) 18 hours of storage in the refrigerator.
- FIG. 10shows TSA plate of wet protein concentrate at pH 4.5 after two days of storage at 30° C.
- FIG. 11shows TSA Plates of A) non-treated and B) 15 minutes at 75° C. heat treated biomass after 6 days of storage of the TSA plates.
- FIG. 12shows A) Bacteria B) Fungus observed in non-treated biomass and C) bacteria in heat-treated biomass observed after 6 days of storage of TSA plates.
- FIG. 13shows TSA plates of biomass treated: A) without nisin (left) and with B) 70 ppm nisin (right), stored at room temperature.
- FIG. 14shows TSA plates of treated biomass for 3 hours: A) without nisin (left, top) stored at room temperature, B) with 70 ppm nisin (right, top), stored at room temperature, C) without nisin (left, bottom) stored at 4° C. temperature and D) with 70 ppm nisin (right, bottom), stored at 4° C. temperature.
- FIG. 15shows TSA plates of treated biomass for 6 hours: A) without nisin (left, top) stored at room temperature, B) with 70 ppm nisin (right, top), stored at room temperature, C) without nisin (left, bottom) stored at 4° C. temperature and D) with 70 ppm nisin (right, bottom), stored at 4° C. temperature.
- FIG. 16shows TSA plates of treated biomass for 18 hours: A) without nisin (left, top) stored at room temperature, B) with 70 ppm nisin (right, top), stored at room temperature, C) without nisin (left, bottom) stored at 4° C. temperature and D) with 70 ppm nisin (right, bottom), stored at 4° C. temperature.
- FIG. 17shows TSA plates of treated biomass for 24 hours: A) without nisin (left, top) stored at room temperature, B) with 70 ppm nisin (right, top), stored at room temperature, C) without nisin (left, bottom) stored at 4° C. temperature and D) with 70 ppm nisin (right, bottom), stored at 4° C. temperature.
- FIG. 18shows TSA plates of A) non-heat treated and B) heat treated (75° C. for 30 minutes) biomass on the beginning of the study.
- FIG. 19shows microscopy image of what was growing on the TSA plate of non-treated biomass on day 0.
- FIG. 20shows images of TSA plates of non-heat treated biomass stored at 4° C., for 5 days at different pH with and without antimicrobial agents.
- Column A)represents pH 3
- Column B)represents pH 4.5
- Column C)represents pH 5
- Column Drepresents 7.
- Row 1represents the control, non-treated biomass at the different pH conditions.
- Row 2represents Calcium propionate (CP, 1000 ppm) treated biomass at the different pH conditions.
- Row 3represents Sodium benzoate and potassium sorbate (SB+PS, 1000 ppm each) treated biomass at the different pH conditions.
- Row 4represents Cultured dextrose (BV, 0.25 w/w %) treated biomass at the different pH conditions.
- FIG. 21shows images of TSA plates of heat treated biomass stored at 4° C., for 5 days at different pH with and without antimicrobial agents.
- Column A)represents pH 3
- Column B)represents pH 4.5
- Column C)represents pH 5.
- Row 1represents the control, non-treated biomass at the different pH conditions.
- Row 2represents Sodium benzoate and potassium sorbate (SB+PS, 1000 ppm each) treated biomass at the different pH conditions.
- Row 3represents Cultured dextrose (BV, 0.25 w/w %) treated biomass at the different pH conditions.
- FIG. 22shows images of TSA plates of various treated biomass stored at 4° C., for 16 days at different pH with and without antimicrobial agents.
- Column A)represents pH 3
- Column B)represents pH 4.5
- Column C)represents pH 5.
- Row 1represents non heat treated biomass with Sodium benzoate and potassium sorbate (SB+PS, 1000 ppm each) at the different pH conditions.
- Row 2represents the heat treated biomass control, at the different pH conditions.
- Row 3represents heat treated biomass with Cultured dextrose (BV, 0.25 w/w %) at the different pH conditions.
- Row 4represents the heat treated biomass with Sodium benzoate and potassium sorbate (SB+PS, 1000 ppm each) at the different pH conditions.
- FIG. 23shows images of the TSA plates (A-C) and microscopy images (D-F) of liquid egg prepared using protein concentrate powder.
- FMicroscopy image on day 3 with 0.35 w/w % Cultured dextrose and 500 ppm of Nisin added to the liquid egg preparation.
- Microalgaeare a rich source of protein, essential fatty acids, vitamins, and minerals. After lipid removal, the residual biomass contains even higher concentrations of protein and other nutrients. Microalgae are good sources of long chain polyunsaturated fatty acids (“PUFA”) and have been used to enrich diets with omega-3 PUFA. Described herein are, inter alia, novel techniques for extracting a variety of components from heterotrophically cultivated microalgae, e.g., Euglena , without the use of harsh chemicals or solvents.
- PUFAlong chain polyunsaturated fatty acids
- EuglenaA specific species of algae named Euglena gracilis (hereinafter Euglena ) belongs to a group of single-celled microscopic algae, that is often used as a candidate species for laboratory studies and technological applications.
- Euglenapossess the representative features typical of eukaryotic cells such as a mitochondria, nucleus, and lysosome.
- Euglenacan further be characterized for its long flagellum and large red eyespot. They are distinctive as they can produce their own nourishment (autotrophic) similar to plants, as well as eat and digest external food sources (heterotrophic) like animals.
- Euglenais a demonstrated, multifaceted model organism for study.
- Euglenacan be directed to produce target compounds by adjusting key parameters in the production process. These critical adjustments can be used to enhance the natural mechanisms of the microorganism, to encourage rapid growth and the efficient conversion of valuable products with little waste production.
- Eggsare a staple ingredient, found in most homes worldwide. As the population continues to lean towards a healthier and more sustainable lifestyle, this has led to a need in the marketplace for a sustainable, healthy egg alternative.
- the eggis a versatile affordable complete nutritive solution.
- Currently available vegan and plant based egg substituteslack full nutritional benefits as well as essential amino acids, creating an incomplete protein product.
- the commercially available egg substitute solutionslack the texture, flavor, and color of the commonly used chicken egg. Manufacturers of these products must add artificial colors or additional ingredients to mimic the natural yellow color of a chicken egg yolk.
- the egg replacement described hereinincludes many advantages over previous egg replacement: 1) no risk of any avian-related disease contaminating the product, 2) can be used as scrambled egg analog providing a complete nutritive egg replacement, 3) can be used to replace eggs in the manufacture of various types of foods, such as bakery products, condiments, noodles, etc., and 4) can be used to replace eggs in the manufacture of specialty items such as shampoo, pet foods and adhesive products.
- the egg replacement described hereinis suitable for various food applications for example, edible egg-free emulsion, egg analog, egg-free scrambled eggs, egg-free patty, egg-free bakery items, egg-free cream cheese, egg-free pasta dough, egg-free custard, and egg-free ice cream.
- Baked goodmeans a food item, typically found in a bakery, that is prepared by using an oven and usually contain a leavening agent. Baked goods include, but are not limited to breads, brownies, cookies, pies, cakes and pastries.
- “Bread”means a food item that contains flour, liquid, and usually a leavening agent. Breads are usually prepared by baking in an oven, although other methods of cooking are also acceptable.
- the leavening agentcan be chemical or organic/biological in nature. Typically, the organic leavening agent is yeast. In the case where the leavening agent is chemical in nature (such as baking powder and/or baking soda), these food products are referred to as “quick breads.” Crackers and other cracker-like products are examples of breads that do not contain a leavening agent.
- transitional term “comprising,” which is synonymous with “including,” “containing,” or “characterized by,”is inclusive or open-ended and does not exclude additional, un-recited elements or method steps.
- the transitional phrase “consisting of”excludes any element, step, or ingredient not specified in the claim.
- the transitional phrase “consisting essentially of”limits the scope of a claim to the specified materials or steps “and those that do not materially affect the basic and novel characteristic(s)” of the claimed invention.
- the term comprisingis used as the transition phrase, such embodiments can also be envisioned with replacement of the term “comprising” with the terms “consisting of” or “consisting essentially of.”
- Dispersionrefers to a distribution of particles more or less evenly throughout a medium, including a liquid or gas.
- One common form of dispersionis an emulsion made up of a mixture of two or more immiscible liquids such as oil and water.
- Dry weightmeans weight determined in the relative absence of water. For example, reference to a dry mixture refers to a specified percentage of a particular component(s) by dry weight as a percentage and is calculated based on the weight of the composition before any liquid has been added.
- the term “eggs”includes but is not limited to chicken eggs, other bird eggs (such as quail eggs, duck eggs, ostrich eggs, turkey eggs, bantam eggs, goose eggs), and fish eggs such as fish roe. Typical food application comparison is made with respect to chicken eggs.
- emulsifyingrefers to where a substance is present in a food composition or food product as a single-phase mixture where a two-phase system of oil and water would normally have existed.
- An emulsionthus refers to a kinetically stable mixture of two normally immiscible liquids, i.e. oil and water. In some other foods, the water is dispersed in oil.
- Edible ingredientmeans any substance or composition which is fit to be eaten. “Edible ingredients” include, without limitation, grains, fruits, vegetables, proteins, herbs, spices, carbohydrates, and fats.
- the term “enriched”refers to an increase in a percent amount of a molecule, for example, a protein, in one sample relative to the percent amount of the molecule in a reference sample. In some embodiments, the enrichment is on a weight to weight basis. In some embodiments, the enrichment refers to an increase of about 5%, 10%, 15%, 20%, 25%, 30%, 35%, 40%, 45%, or 50% relative to the reference value or amount. In some embodiments, the enrichment refers to an increase of at least about 5%, 10%, 15%, 20%, 25%, 30%, 35%, 40%, 45%, or 50% relative to the reference value or amount.
- Finished food product and “finished food ingredient”mean a food composition that is ready for packaging, use, or consumption.
- a “finished food product”may have been cooked or the ingredients comprising the “finished food product” may have been mixed or otherwise integrated with one another.
- a “finished food ingredient”is typically used in combination with other ingredients to form a food product.
- the term “functional food product” as used hereinrefers to a food product given an additional function by adding new ingredients or more of existing ingredients. For example, where protein is added to a food product to provide texture, water holding capacity or nutritional support to a food product.
- Foodmeans any composition intended to be or expected to be ingested by humans or other animals as a source of nutrition and/or calories.
- Food compositionsare composed primarily of carbohydrates, fats, water and/or proteins and make up substantially all of an individual's daily caloric intake.
- gellingrefers to a food composition or a food product in a gelatinous form.
- a gelatinous formis created by incorporating solids and liquids into a uniform three dimensional, semi-solid structure.
- a gelatinous food productis considered a soft gel when its tensile strength is in the range of 500-1000 g/cm 2 , as seen in, for example, jelly and jams, nut butters (e.g. just nuts versions), jelly-like products, and fondant.
- a gelatinous food productis considered a hard gel when its tensile strength is in the range of 1000-3000 g/cm 2 , as seen in, for example, gummy candy, confectionary gels (i.e. cookie filling), fruit gel bars, and fruit snacks.
- “Foamability” as used herein,refers to the ability of a material to rapidly adsorb on the air-liquid interface during whipping or bubbling, and to form a cohesive viscoelastic film by way of intermolecular interactions.
- fresh biomassor “fresh Euglena biomass” as used herein refers to biomass or Euglena biomass that is not frozen or dried after harvesting and is kept at 4° C. until use.
- GMPGood manufacturing practice
- 21 C.F.R. 110for human food
- 111for dietary supplements
- the U.S. regulationsare promulgated by the U.S. Food and Drug Administration under the authority of the Federal Food, Drug, and Cosmetic Act to regulate manufacturers, processors, and packagers of food products and dietary supplements for human consumption. All of the processes described herein can be performed in accordance with GMP or equivalent regulations. In the United States, GMP regulations for manufacturing, packing, or holding human food are codified at 21 C.F.R. 110.
- GMP conditions in the Unites States, and equivalent conditions in other jurisdictions,apply in determining whether a food is adulterated (the food has been manufactured under such conditions that it is unfit for food) or has been prepared, packed, or held under unsanitary conditions such that it may have become contaminated or otherwise may have been rendered injurious to health.
- GMP conditionscan include adhering to regulations governing: disease control; cleanliness and training of personnel; maintenance and sanitary operation of buildings and facilities; provision of adequate sanitary facilities and accommodations; design, construction, maintenance, and cleanliness of equipment and utensils; provision of appropriate quality control procedures to ensure all reasonable precautions are taken in receiving, inspecting, transporting, segregating, preparing, manufacturing, packaging, and storing food products according to adequate sanitation principles to prevent contamination from any source; and storage and transportation of finished food under conditions that will protect food against physical, chemical, or undesirable microbial contamination, as well as against deterioration of the food and the container.
- “Increased lipid yield”means an increase in the lipid/oil productivity of a microalgal culture that can achieved by, for example, increasing the dry weight of cells per liter of culture, increasing the percentage of cells that contain lipid, and/or increasing the overall amount of lipid per liter of culture volume per unit time.
- hakingrefers to the movement of a sample, in an up and down or side to side, rapid, forceful or jerky movement. This may be done manually, or mechanically.
- solutionrefers to a homogeneous mixture of a substance (solute) dispersed through a liquid medium (solvent) that cannot be separated by the forces of gravity alone.
- solid contentrefers to how much mass (i.e. biomass or protein concentrate) is in a liquid by weight of each.
- substantially freerefers to the complete or near complete lack of light or a component.
- a composition that is “substantially free” of waterwould either completely lack water, or so nearly completely lack water that the effect would be the same as if it completely lacked water.
- the term “stability” and derivatives thereofrefer to heat stability, freeze-thaw stability, light stability, emulsion stability, or storage stability.
- Heat stabilityis the ability of a product or material to retain the same properties after exposure to a high heat for a single set period of time or a cycling of exposure times.
- Freeze-thaw stabilityis the ability of a product or material to retain the same properties after being frozen and subsequently thawed, which can be cycled through a number of freeze thaw cycles.
- Light stabilityis the ability of a product or material to retain the same properties after exposure to a light, such as sunlight or indoor light for a single set period of time or a cycling of exposure times.
- Emulsion stabilityis the ability of a product or material to retain an emulsion and to prevent separating, over time.
- the term “stabilizer”relates to a material that provides stability described herein when added to a product or another material.
- a stabilizermay be an ingredient incorporated into a final food formulation which preserves the structure and sensory characteristics of a food product over time, which would not otherwise be maintained in the absence of the stabilizer.
- solubilityrefers to the maximum amount of a substance that is able to be completely dissolved in a solution, usually in a specific amount.
- Uncooked productmeans a composition that has not been subjected to heating but may include one or more components previously subjected to heating.
- viscosityrefers to the resistance of a fluid when attempting to flow, may also be thought of as a measure of fluid friction.
- W/W or “w/w,” in reference to proportions by weightmeans the ratio of the weight of one substance in a composition to the weight of the composition.
- reference to a composition that comprises 5% w/w microalgal biomassmeans that 5% of the composition's weight is composed of microalgal biomass (e.g., such a composition having a weight of 100 mg would contain 5 mg of microalgal biomass) and the remainder of the weight of the composition (e.g., 95 mg in the example) is composed of other ingredients.
- W/Vor “w/v” means the ratio of the weight of one substance in a composition to total volume of the composition.
- reference to a composition that comprises 5% w/v microalgal biomassmeans that 5 g of microalgal biomass is dissolved in a final volume of 100 mL aqueous solution.
- whippingrefers to the action of using a whisk, or a mixer to beat a sample in order to rapidly incorporate air and produce expansion.
- water holding capacityor WHC or a derivative thereof as used herein relating to food composition or product refers to the ability to hold the food's own and added water during the application of forces, pressing, centrifugation, or heating. WHC may also be described as a physical property, for example, the ability of a food structure to prevent water from being released from the three-dimensional structure of, for example, a gel.
- the Euglenamay be selected from the group of species selected from Euglena gracilis, Euglena sanguinea, Euglena deses, Euglena mutabilis, Euglena acus, Euglena virdis, Euglena anabaena, Euglena geniculata, Euglena oxyuris, Euglena proxima, Euglena tripteris, Euglena chlamydophora, Euglena splendens, Euglena texta, Euglena intermedia, Euglena polymorpha, Euglena ehrenbergii, Euglena adhaerens, Euglena clara, Euglena elongata, Euglena elastica, Euglena oblonga, Euglena pisciformis, Euglena cantabrica, Euglena granulata, Euglena obtusa, Eu
- Embodiments described hereinare directed to a dry egg replacement composition comprising about 10% to about 98% Euglena -derived material, about 10% to about 85% pea protein, and one or more additional ingredient, wherein the dry egg replacement composition comprises one or more functional property of a natural egg.
- the one or more additional ingredientis selected from the group consisting of gellan gum, methylcellulose, yeast extract, flavoring, antioxidant blend, and combinations thereof.
- the flavoringis selected from the group consisting of black salt, sea salt, onion powder, and combinations thereof.
- Embodiments described hereinare directed to a dry egg replacement composition comprising about 1% to about 100% Euglena -derived material, about 0.05% to about 70% additional protein source, and one or more additional ingredient, wherein the dry egg replacement composition comprises one or more functional property of a natural egg.
- the additional protein sourceis selected from the group consisting of pea protein, soy protein, corn protein, wheat protein, rice protein, beans protein, seed protein, nut protein, almond protein, peanut protein, instantan protein, lentil protein, chickpea protein, flaxseed protein, wild rice protein, quorn protein, chia seed protein, quinoa protein, oat protein, fava bean protein, buckwheat protein, bulgar protein, millet protein, microalgae protein, yellow pea protein, mung bean protein, hemp protein, sunflower protein, canola protein, lupin protein, legumes protein, potato protein, and combinations thereof.
- the additional protein sourceis in an amount of about 0.05% to about 70%, about 0.5% to about 70%, about 1% to about 70%, about 5% to about 70%, about 10% to about 70%, about 15% to about 70%, about 0.05% to about 60%, about 0.05% to about 50%, about 0.05% to about 40%, about 0.05% to about 30%, or about 0.05% to about 20%.
- the additional protein sourceis in an amount of about 0.05% to about 15%. In certain embodiments of the dry egg replacement composition described herein, the additional protein source is in an amount of about 20% to about 60%.
- the one or more additional ingredientis selected from the group consisting of gellan gum, methylcellulose, yeast extract, flavoring, antioxidant blend, maskers, leavening agents, baking powder, baking soda, enzymes, transglutaminase, emulsifiers, lecithin, mono- and diglycerides, binders, carrot fiber, defatted linseed flour, and combinations thereof.
- each of the one or more additional ingredientis in an amount of about 0.05% to about 5%, about 0.05% to about 4%, or about 0.05% to about 3%, or about 0.05% to about 2%. In certain embodiments of the dry egg replacement composition described herein, each of the one or more additional ingredient is in an amount of about 0.1% to about 1%.
- the flavoringis selected from the group consisting of black salt, black pepper, Himalayan sea salt, salt, onion powder, minced onion, roasted garlic, mushroom powder, yeast extract, and combinations thereof.
- the Euglena -derived materialis selected from the group consisting of a Euglena biomass, a Euglena -derived protein, a protein-rich flour derived from Euglena , a protein concentrate derived from Euglena , a protein isolate derived from Euglena , a Euglena -derived beta-glucan isolate, a Euglena -derived oil, and combinations thereof.
- the dry egg replacement compositionfurther comprises one or more hydrocolloids.
- the one or more hydrocolloidsmay be selected from the group consisting of locust bean gum, a guar gum, a konjac gum, a gellan gum, a high methoxy pectin, a low methoxy pectin, an Agar, a kappa carrageenan, an iota carrageenan, a lambda carrageenan, an alginate, a curdlan, a methyl cellulose, a carboxymethyl cellulose (CMC), a xanthan gum, a gum Arabic, a Euglena derived beta-glucan and combinations thereof.
- CMCcarboxymethyl cellulose
- each of the one or more hydrocolloidsis in an amount of about 0.05% to about 8%, about 0.1% to about 8%, about 0.05% to about 7%, about 0.05% to about 6%, about 0.05% to about 5%, about 0.05% to about 4%, or about 0.05% to about 3%. In certain embodiments of the dry egg replacement composition described herein, each of the one or more hydrocolloids is in an amount of about 0.1% to about 2%.
- the dry egg replacement described hereinhas a similar nutritional content as a natural egg, which previous attempts to create an egg substitute have failed to attain.
- egg replacement compositionTo be equivalent to a natural egg, egg replacement composition must have a protein content of 6 g per serving. Previous attempts and commercially available egg substitutes are only able to achieve 5 g per serving.
- the dry egg replacement composition described hereincontains the same amount of protein as a chicken egg. In embodiments described herein, the dry egg replacement composition contains at least 6 g of complete protein per serving size. In certain embodiments, the dry egg replacement composition contains about 6 g to about 10 g, about 6 g to about 9 g, about 6 g to about 8 g, about 6 g to about 7 g, or about 6 g to about 6.5 g of complete protein per serving size.
- the serving size of the dry egg replacement compositionis about 9 g to about 15 g, about 10 g to about 14 g, about 11 g to about 13 g, or about 12 g to about 12.5 g. In embodiments described herein, the serving size of the dry egg replacement composition is about 12.5 g. In certain embodiments, the dry egg replacement composition is mixed with an oil and water to create an emulsion wherein the liquid serving size is from about 50 g to about 100 g, about 60 g to about 90 g, about 70 g to about 80 g, or about 80 g to about 90 g. In certain embodiments, the dry egg replacement composition is mixed with an oil and water to create an emulsion wherein the liquid serving size is about 80 g to about 90 g.
- the combination of Euglena -derived material and pea proteinestablished the nutritional profile similar to a natural egg, including at least 6 g of protein, about 5 g of fat, about 180 mg cholesterol, about 60 mg of sodium, about 60 mg potassium, about 0.6 g carbohydrates, and vitamins and minerals, including vitamin A, vitamin D, vitamin B-6, calcium, cobalamin, iron and magnesium.
- the egg replacementprovides about 75 calories.
- the dry egg replacement compositionhas a ratio of Euglena -derived material to pea protein of about 20:80 to about 50:50. In certain embodiments, the dry egg replacement composition has a ratio of Euglena -derived material to pea protein of about 25:75 to about 50:50. In certain embodiments, the dry egg replacement composition has a ratio of Euglena -derived material to pea protein of about 40:60.
- the Euglena -derived materialis in an amount of about 10% to about 98%, about 10% to about 95%, about 10% to about 85%, about 15% to about 75%, about 20% to about 65%, or about 25% to about 55% in the dry mixture. In certain embodiments, the Euglena -derived material is in an amount of about 5% to about 90% in the dry mixture. In certain embodiments, the Euglena -derived material is in an amount of about 40% to about 87% in the dry mixture. In certain embodiments, the Euglena -derived material is in an amount of about 40% to about 90% in the dry mixture. In certain embodiments, the Euglena -derived material is in an amount of about 35% in the dry mixture.
- the Euglena -derived materialis in an amount of about 7% in the dry mixture. In certain embodiments, the Euglena -derived material is in an amount of about 35 g to about 70 g, about 40 g to about 65 g, about 45 g to about 60 g, or about 50 g to about 55 g in the dry mixture. In certain embodiments, the Euglena -derived material is in an amount of about 56 g in the dry mixture.
- the pea proteinis in an amount of about 5% to about 10%, about 5% to about 20%, about 10% to about 85%, about 15% to about 75%, about 20% to about 65%, or about 25% to about 55% in the dry mixture. In certain embodiments, the pea protein is in an amount of about 52% in the dry mixture. In certain embodiments, the pea protein is in an amount of about 55 g to about 95 g, about 60 g to about 90 g, about 55 g to about 85 g, or about 60 g to about 80 g in the dry mixture. In certain embodiments, the pea protein is in an amount of about 84 g in the dry mixture.
- the total amount of protein blend in the dry egg replacement compositionis about 60% to about 90% of the dry mixture.
- the protein blendincludes the combination of Euglena -derived material and pea protein.
- the total amount of protein blend in the dry egg replacement compositionis about 60%, about 65%, about 70%, about 75%, about 80%, about 85%, or about 90% of the dry mixture.
- the total amount of protein blend in the dry egg replacement compositionis about 87% of the dry mixture.
- the yeast extractis in an amount of about 0.2 g to about 5 g, about 0.5 g to about 4 g, about 1 g to about 3 g, or about 1.5 g to about 2 g in the dry mixture. In certain embodiments, the yeast extract is in an amount of about 1.4 g in the dry mixture. In certain embodiments, the amount of yeast extract in the dry egg replacement composition is from about 0.1% to about 5%, about 0.5% to about 4.5%, about 1% to about 4%, about 1.5% to about 3.5%, or about 2% to about 3% of the dry mixture.
- the amount of yeast extract in the dry egg replacement compositionis about 0.1%, about 0.5%, about 1%, about 1.5%, about 2%, about 2.5%, about 3% about 3.5%, about 4%, about 4.5%, or about 5%, of the dry mixture. In certain embodiments, the amount of yeast extract in the dry egg replacement composition is about 1% of the dry composition.
- the yeast extractcontributes to the overall nutritional content of the dry egg replacement composition necessary to match a natural egg.
- the yeast extractalso provides an umami flavor to the final product.
- the dry egg replacement compositionis rich in beta-1,3-glucan.
- Beta-1,3-glucanprovides health benefits including, but not limited to, immunity, antidiabetic properties, antihypoglycemic properties, and hepatoprotective properties.
- the dry egg replacement compositioncontains essential nutrients.
- the essential nutrientsare selected from the group consisting of amino acids, fatty acids, vitamins, minerals, and combinations thereof.
- the amino acidsare selected from the group consisting of phenylalanine, valine, threonine, tryptophan, methionine, leucine, isoleucine, lysine, histidine, and combinations thereof.
- the fatty acidsare selected from the group consisting of omega-3 fatty acids, omega-6 fatty acids, omega-9 fatty acids, or combinations thereof.
- the vitaminsare selected from the group consisting of vitamin E, tocopherol, tocotrienols, vitamin A, vitamin C, vitamin D, vitamin K, thiamine (vitamin B1), riboflavin (vitamin B2), niacin (vitamin B3), pantothenic acid (vitamin B5), pyridoxine (vitamin B6), biotin (vitamin B7), folate (vitamin B9), cyanocobalamin (vitamin B12), vitamin D, and combinations thereof.
- the mineralsare selected from the group consisting of potassium, chloride, sodium, calcium, phosphorus, sulfur, fluoride, magnesium, iron, zinc, manganese, copper, iodine, chromium, molybdenum, selenium, cobalt, and combinations thereof.
- the dry egg replacement compositioncontains vitamin A, riboflavin, pantothenic acid, vitamin B12, choline, phosphorus, zinc, and vitamin D.
- the dry egg replacement compositioncontains medium-chain triglycerides (MCT), i.e. triglycerides with two or three fatty acids having an aliphatic tail of 6-12 carbon atoms.
- MCTsare selected from the group consisting of caproic acid, caprylic, acid, capric acid, lauric acid, and combinations thereof
- the dry egg replacement composition described hereinhas been developed to provide the same functional benefits as a natural egg.
- the functional propertiesare measured and evaluated using the dry egg replacement composition, the egg replacement emulsion, liquid egg, or liquid egg formulation described herein.
- the dry egg replacement compositionhas one or more functional property of a natural egg.
- the dry egg replacement compositionhas at least 2 functional properties of a natural egg.
- the one or more functional property of a natural eggis selected from the group consisting of complete nutrition, protein digestibility-corrected amino acid score (PDCAAS), gelation, foaming, viscosity, emulsification, water binding capacity, texture, elasticity, springiness, solubility, flavor, coagulation, aeration, creaminess, film forming property, sheen addition, shine addition, freeze stability, thaw stability, color, and combinations thereof.
- PDCAASprotein digestibility-corrected amino acid score
- the gellan gumis in an amount of about 1 g to about 10 g, about 1.5 g to about 9 g, about 2 g to about 8 g, or about 4 g to about 6 g in the dry mixture. In certain embodiments, the gellan gum is in an amount of about 5.6 g in the dry mixture. In certain embodiments, the amount of gellan gum in the dry egg replacement composition is from about 0.5% to about 5%, about 1% to about 4%, or about 2% to about 3% of the dry mixture. In certain embodiments, the amount of gellan gum in the dry egg replacement composition is about 0.5%, about 1%, about 2%, about 3%, about 4%, or about 5% of the dry mixture. In certain embodiments, the amount of gellan gum in the dry egg replacement composition is about 3.5% of the dry mixture. Gellan gum is heat-activated and helps to retain the texture of the final egg product despite cooling after being cooked.
- the methylcelluloseis in an amount of about 1 g to about 12 g, about 2 g to about 10 g, about 3 g to about 9 g, or about 4 g to about 8 g in the dry mixture. In certain embodiments, the methylcellulose is in an amount of about 8.75 g in the dry mixture. In certain embodiments, the amount of methylcellulose in the dry egg replacement composition is from about 1% to about 10%, about 1% to about 9%, about 2% to about 8%, about 2% to about 7%, about 2% to about 6%, about 2% to about 9%, about 3% to about 8%, about 4% to about 7%, or about 5% to about 6% of the dry mixture.
- the amount of methylcellulose in the dry egg replacement compositionis about 1%, about 1.5%, about 2%, about 2.5%, about 3%, about 3.5%, about 4%, about 4.5%, about 5%, about 5.5%, or about 6% of the dry mixture. In certain embodiments, the amount of methylcellulose in the dry egg replacement composition is about 5.5% of the dry mixture.
- Methylcellulosesupports the structure of the food product at high temperatures and helps retain the texture and moisture of the food product.
- the protein digestibility-corrected amino acid scoreis a method of evaluating the quality of a protein based on both the amino acid requirements of humans and their ability to digest it. Using the PDCAAS method, the protein quality rankings are determined by comparing the amino acid profile of the specific food protein against a standard amino acid profile with the highest possible score being a 1.0. In some embodiments, the protein digestibility-corrected amino acid score (PDCAAS) of the dry egg replacement composition and/or the egg replacement emulsion and/or liquid egg and/or liquid egg formulation and/or egg replacement formulation described herein is 1.0.
- the functional property of gelationis measured by the temperature at which gelling occurs.
- the dry egg replacement composition and/or the egg replacement emulsion and/or liquid egg and/or liquid egg formulation and/or egg replacement formulation described hereinhas a gelation onset below 90° C.
- gel strengthcan be tested using a torsion test. An appropriately sized, and shaped gel is twisted in a rheometer until the gel either breaks, or it is ruptured. The amount of the force that caused the cross-section to rupture is then calculated and can be measured against other sensory results. The strength of a gel is affected by temperature, pH, and the amount of the protein derivative in the food product.
- the gel strength of the food product comprising protein flour, protein concentrate and/or protein isolatecan be measured by a tensiometer.
- the gel strengthcan also be measured by a texture analyzer, such as TA.XT Express or TA.XTPlus (Texture Technologies), FTC Texture Analyzer (Food Technology Corporation), and LFRA texture analyzer (Brookfield Engineering), which through compression and tensile data, can measure a number of physical properties, including tensile strength, i.e. a measurement of the force required to pull the gelatinous or “gelled” food product to the point where it breaks. Texture analyzers also test the crunchiness, gumminess, adhesiveness, chewiness, and general texture of many smaller things from crackers to candy.
- Texture analyzersmeasure tensile strength (i.e. in lb/in 2 or psi) and compressive strength (i.e. psi or MPa) of materials.
- the principle of a texture measurement systemis to physically deform a test sample in a controlled manner and measure its response. The characteristics of the force response are as a result of the sample's mechanical properties, which correlate to specific sensory texture attributes.
- a texture analyzerapplies this principle by performing the procedure automatically and indicating the results visually on a digital numerical display, or screen.
- the functional property of foamingis measured by the ability of the composition to retain air in suspension.
- the dry egg replacement composition and/or the egg replacement emulsion and/or liquid egg and/or liquid egg formulation and/or egg replacement formulation described hereincan be sufficiently foamed.
- the dry egg replacement composition and/or the egg replacement emulsion described hereincan be used as an emulsifier.
- the dry egg replacement composition and/or the egg replacement emulsion and/or liquid egg and/or liquid egg formulation and/or egg replacement formulation described hereinhas water binding capacity.
- Water binding capacitycan be measured using water absorption or water holding capacity. Water Absorption is tested by adding 10 mLs of water to 0.5 g of mixture in a 13-ml graduated plastic test tube. The mixture is sonicated for 30 s at an output setting of 5 to disperse the sample. The mixture is held at 24° C. for 30 min, and then centrifuged at 2000 rpm for 25 min. The volume of free water is measured and the retained water is computed and reported as ml of water (+/ ⁇ 0.1 ml) absorbed per g of mixture.
- Testing Water Holding Capacitycan be measured using the following methods: 1) Centrifuge: rapidly rotating device applies centrifugal force to the components in order to force separation. As such, fluids of different densities become separated, as do liquids from solids. 2) Press Method: the water holding capacity of the composition is calculated based off of the weight of the substance after it has been pressed.
- the dry egg replacement composition and/or the egg replacement emulsion and/or liquid egg and/or liquid egg formulation and/or egg replacement formulation described hereinhas the texture or consistency of a natural egg.
- the dry egg replacement composition and/or the egg replacement emulsion and/or liquid egg and/or liquid egg formulation and/or egg replacement formulation described hereinhas the viscosity of a natural egg. Consistency is the relative ability of a sample to flow. Viscosity is the measure of how hard it is to force a substance into motion, or flow. The texture or consistency can be measured using a texture or consistency analyzer.
- the dry egg replacement composition and/or the egg replacement emulsion and/or liquid egg and/or liquid egg formulation and/or egg replacement formulation described hereinhas the flavor of a natural egg.
- the development of the dry egg replacement compositionhas overcome the fishy, algae taste typically found when utilizing algal protein in egg substitutes or other food products.
- the dry egg replacement composition and/or the egg replacement emulsion and/or liquid egg and/or liquid egg formulation and/or egg replacement formulation described hereinhas a neutral, slight sulfury taste which corresponds to a natural egg unlike previous versions or commercially available products and/or a reduction of undesirable characteristics typically found with algal compositions, for example fishy smell, unpleasant smell, fishy taste, or unpleasant taste.
- the tastecan be measured using chromatographic analysis and consumer testing.
- the dry egg replacement composition and/or the egg replacement emulsion and/or liquid egg and/or liquid egg formulation and/or egg replacement formulation described hereinhas a unique combination of black salt and onion powder.
- the ratio of black salt to onion powderis about 30:70 to about 50:50.
- the flavoringis in an amount of about 0.5 g to about 10 g, about 1 g to about 8 g, about 2 g to about 6 g, or about 3 g to about 5 g in the dry mixture. In certain embodiments, the flavoring is in an amount of about 4 g in the dry mixture. In certain embodiments, the amount of flavoring in the dry egg replacement composition is from about 0.05% to about 5%, about 0.1% to about 5%, about 0.5% to about 4.5%, about 1% to about 4%, about 1.5% to about 3.5%, or about 2% to about 3% of the dry mixture.
- the amount of flavoring in the dry egg replacement compositionis about 0.05%, about 0.1%, about 0.5%, about 1%, about 1.5%, about 2%, about 2.5%, about 3% about 3.5%, about 4%, about 4.5%, or about 5%, of the dry mixture. In certain embodiments, the amount of flavoring in the dry egg replacement composition is about 4% of the dry mixture. In certain embodiments, the amount of flavoring in the egg replacement composition is about 1% of the dry mixture. In certain embodiments, the amount of flavoring in the dry egg replacement composition is about 0.1% to about 1% of the dry mixture.
- the flavoringis selected from the group consisting of black salt, black pepper, Himalayan sea salt, salt, onion powder, minced onion, roasted garlic, mushroom powder, yeast extract, and combinations thereof.
- the black saltis in an amount of about 0.5 g to about 10 g, about 1 g to about 8 g, about 2 g to about 6 g, or about 3 g to about 5 g in the dry mixture. In certain embodiments, the black salt is in an amount of about 2.45 g in the dry mixture. In certain embodiments, the amount of black salt in the dry egg replacement composition is about 1.5% of the dry mixture.
- the onion powderis in an amount of about 0.5 g to about 10 g, about 1 g to about 8 g, about 2 g to about 6 g, or about 3 g to about 5 g in the dry mixture. In certain embodiments, the onion powder is in an amount of about 1.40 g in the dry mixture. In certain embodiments, the amount of onion powder in the dry egg replacement composition is about 1% of the dry mixture.
- the dry egg replacement composition and/or the egg replacement emulsion and/or liquid egg and/or liquid egg formulation and/or egg replacement formulation described hereinis a similar color to the yolk of a natural egg. Accordingly, the dry egg replacement composition and/or the egg replacement emulsion and/or liquid egg and/or liquid egg formulation and/or egg replacement formulation described herein contains no added colors.
- the dry egg replacement composition and/or the egg replacement emulsion and/or liquid egg and/or liquid egg formulation and/or egg replacement formulation described hereinhas reduction or absence of undesirable characteristics typically found with algal compositions, for example green-color. Previous versions or commercially available products must utilize artificial coloring to achieve the natural yellow color. Color can be measured using colorimetric analyzer.
- the dry egg replacement composition described hereinhas a shelf life which is longer than a natural egg at either room temperature, refrigerator temperature (about 2° C.), or freezer temperature (about ⁇ 4° C.). In certain embodiments, the dry egg replacement composition contains no added preservatives.
- the dry egg replacement composition described hereinhas an enhanced shelf life at room temperature. In some embodiments, the shelf life at room temperature is greater than 3 months, greater than 4 months, greater than 5 months, greater than 6 months, greater than 7 months, greater than 8 months, greater than 9 months, greater than 10 months, greater than 11 months, or greater than 12 months. In some embodiments, the shelf life at room temperature is at least 6 months.
- the dry egg replacement composition described hereinhas an enhanced shelf life when stored in a refrigerator or freezer.
- the shelf life when stored in a refrigerator or freezeris greater than 3 months, greater than 4 months, greater than 5 months, greater than 6 months, greater than 7 months, greater than 8 months, greater than 9 months, greater than 10 months, greater than 11 months, or greater than 12 months. In some embodiments, the shelf life when stored in a refrigerator or freezer is at least 6 months. In some embodiments, the dry egg replacement composition and/or the egg replacement emulsion and/or liquid egg and/or liquid egg formulation and/or egg replacement formulation described herein has the freeze stability and thaw stability of a natural egg.
- the egg replacement emulsion described hereinhas the consistency necessary to replace a natural egg in any food application.
- the egg replacement emulsion described hereinhas a property similar to a natural egg selected from the group consisting of emulsifying properties, viscosity, consistency, elasticity, springiness, solubility, coagulation, aeration, creaminess, film forming property, sheen addition, shine addition, and combinations thereof. Accordingly, the egg replacement emulsion described herein cooks in about the same time as a natural egg.
- Embodiments described hereinare directed to an egg replacement emulsion comprising a dry egg replacement composition, an oil, and water.
- the dry egg replacement compositionis about 5% to about 50%, about 10% to about 40%, about 15% to about 30%, or about 20% to about 25% of the egg replacement emulsion.
- the Euglena -derived material of the dry egg replacement compositioncan be selected from the group consisting of a Euglena biomass, a protein-rich flour derived from Euglena , a protein concentrate derived from Euglena , or a protein isolate derived from Euglena.
- the dry egg replacement compositionis in an amount of about 9 g to about 15 g, about 10 g to about 14 g, about 11 g to about 13 g, or about 12 g to about 12.5 g per serving size of the egg replacement emulsion. In certain embodiments, the dry egg replacement composition is in an amount of about 12.5 g per serving size of the egg replacement emulsion. In certain embodiments, the serving size of the egg replacement emulsion is from about 50 g to about 100 g, about 60 g to about 90 g, about 70 g to about 80 g, or about 80 g to about 90 g. In certain embodiments, the serving size of the egg replacement emulsion is from about 80 g to about 90 g.
- the oilis about 5% to about 20%, about 8% to about 18%, about 10% to about 16%, or about 14% to about 14% of the egg replacement emulsion.
- the amount of oil in the egg replacement emulsionis about 1 tablespoon to about 3 tablespoons. In some embodiments, the amount of oil used is about 1 tablespoon, about 2 tablespoons, or about 3 tablespoons.
- the oilcan be selected from the group consisting of vegetable oil, soybean oil, coconut oil, olive oil, peanut oil, fish oil, avocado oil, palm oil, flax oil, corn oil, cottonseed oil, canola oil, rapeseed oil, sunflower oil, safflower oil, sesame oil, grapeseed oil, safflower oil, rice bran oil, propionate, palm kernel oil, cuphea oil, camelina sativa oil, mustard seed oil, cashew nut oil, oat oil, lupine oil, kenaf oil, calendula oil, hemp oil, coffee oil, linseed oil, hazelnut oil, euphorbia oil, pumpkin seed oil, coriander oil, camellia oil, rice oil, tung oil tree oil, cocoa oil
- the wateris about 0.05% to about 80%, about 60% to about 85%, about 65% to about 80%, or about 70% to about 75% of the egg replacement emulsion. In certain embodiments, the water is about 10% to about 50% of the egg replacement emulsion. In certain embodiments, the water is about 50% to about 80% of the egg replacement emulsion.
- the amount of water in the egg replacement emulsionis about 1 ⁇ 4 cup to about 1 cup of water. In some embodiments, the amount of water used is about 1 ⁇ 4 cup, about 1 ⁇ 4 cup, about 1 ⁇ 4 cup, 2 ⁇ 3 cup, 3 ⁇ 4 cup, or 1 cup.
- the egg replacement emulsion described hereinhas the emulsifying properties of a natural egg.
- the egg replacement emulsion described hereinhas the viscosity of a natural egg.
- Apparent Viscosityis measured using a digital viscometer, which would effectively deliver results related to mouth feel, how a product will react to temperature changes, as well as the spread ability of the product.
- the egg replacement emulsion described hereinhas the consistency of a natural egg.
- the egg replacement emulsion described hereinhas the elasticity of a natural egg. In some embodiments, the egg replacement emulsion described herein exhibits an elasticity of greater than 300 Pa.
- the egg replacement emulsion described hereinhas the springiness of a natural egg.
- the egg replacement emulsion described hereinhas the solubility of a natural egg. Solubility can be measured by protein analysis (using colorimetric or Kjeldahl) of the supernatant after the emulsion is centrifuged to remove insoluble components.
- the egg replacement emulsion described hereinhas the coagulation of a natural egg.
- the egg replacement emulsion described hereinhas the aeration of a natural egg.
- the egg replacement emulsion described hereinhas the creaminess of a natural egg.
- the egg replacement emulsion described hereinhas the film forming property of a natural egg.
- the egg replacement emulsion described hereinhas the sheen addition and shine addition of a natural egg.
- the liquid egg described hereinhas the consistency necessary to replace a natural egg in any food application.
- the liquid egg described hereinhas a property similar to a natural egg selected from the group consisting of emulsifying properties, viscosity, consistency, elasticity, springiness, solubility, coagulation, aeration, creaminess, film forming property, sheen addition, shine addition, and combinations thereof. Accordingly, the liquid egg described herein cooks in about the same time as a natural egg.
- Embodiments described hereinare directed to a liquid egg comprising a dry egg replacement composition, an oil, and water.
- the dry egg replacement compositionis about 5% to about 50%, about 10% to about 40%, about 15% to about 30%, or about 20% to about 25% of the liquid egg.
- the Euglena -derived materialis selected from the group consisting of a Euglena biomass, a Euglena -derived protein, a protein-rich flour derived from Euglena , a protein concentrate derived from Euglena , a protein isolate derived from Euglena , a Euglena -derived beta-glucan isolate, a Euglena -derived oil, and combinations thereof.
- the dry egg replacement compositionis in an amount of about 9 g to about 15 g, about 10 g to about 14 g, about 11 g to about 13 g, or about 12 g to about 12.5 g per serving size of the liquid egg. In certain embodiments, the dry egg replacement composition is in an amount of about 12.5 g per serving size of the liquid egg. In certain embodiments, the serving size of the liquid egg is from about 50 g to about 100 g, about 60 g to about 90 g, about 70 g to about 80 g, or about 80 g to about 90 g. In certain embodiments, the serving size of the liquid egg is from about 80 g to about 90 g.
- the oilis about 5% to about 20%, about 8% to about 18%, about 10% to about 16%, or about 14% to about 14% of the liquid egg.
- the amount of oil in the liquid eggis about 1 tablespoon to about 3 tablespoons. In some embodiments, the amount of oil used is about 1 tablespoon, about 2 tablespoons, or about 3 tablespoons.
- the oilcan be selected from the group consisting of vegetable oil, soybean oil, coconut oil, olive oil, peanut oil, fish oil, avocado oil, palm oil, flax oil, corn oil, cottonseed oil, canola oil, rapeseed oil, sunflower oil, safflower oil, sesame oil, grapeseed oil, safflower oil, rice bran oil, propionate, palm kernel oil, cuphea oil, camelina sativa oil, mustard seed oil, cashew nut oil, oat oil, lupine oil, kenaf oil, calendula oil, hemp oil, coffee oil, linseed oil, hazelnut oil, euphorbia oil, pumpkin seed oil, coriander oil, camellia oil, rice oil, tung oil tree oil, cocoa oil, copra oil
- the wateris about 0.05% to about 80%, about 60% to about 85%, about 65% to about 80%, or about 70% to about 75% of the liquid egg. In certain embodiments, the water is about 10% to about 50% of the liquid egg. In certain embodiments, the water is about 50% to about 80% of the liquid egg.
- the amount of water in the liquid eggis about 1 ⁇ 4 cup to about 1 cup of water. In some embodiments, the amount of water used is about 1 ⁇ 4 cup, about 1 ⁇ 4 cup, about 1 ⁇ 2 cup, 2 ⁇ 3 cup, 3 ⁇ 4 cup, or 1 cup.
- the liquid egg described hereinhas the emulsifying properties of a natural egg.
- the liquid egg described hereinhas the viscosity of a natural egg.
- Apparent Viscosityis measured using a digital viscometer, which would effectively deliver results related to mouth feel, how a product will react to temperature changes, as well as the spread ability of the product.
- the liquid egg described hereinhas the consistency of a natural egg.
- the liquid egg described hereinhas the elasticity of a natural egg. In some embodiments, the liquid egg herein exhibits an elasticity of greater than 300 Pa.
- the liquid egg described hereinhas the springiness of a natural egg.
- the liquid egg described hereinhas the solubility of a natural egg. Solubility can be measured by protein analysis (using colorimetric or Kjeldahl) of the supernatant after the emulsion is centrifuged to remove insoluble components.
- the liquid egg described hereinhas the coagulation of a natural egg.
- the liquid egg described hereinhas the aeration of a natural egg.
- the liquid egg described hereinhas the creaminess of a natural egg.
- the liquid egg described hereinhas the film forming property of a natural egg.
- the liquid egg described hereinhas the sheen addition and shine addition of a natural egg.
- the liquid egg described hereinhas the consistency necessary to replace a natural egg in any food application.
- the liquid egg described hereinhas a property similar to a natural egg selected from the group consisting of emulsifying properties, viscosity, consistency, elasticity, springiness, solubility, coagulation, aeration, creaminess, film forming property, sheen addition, shine addition, and combinations thereof. Accordingly, the liquid egg described herein cooks in about the same time as a natural egg.
- Embodiments described hereinare directed to a liquid egg formulation comprising about 50% to about 85% fresh Euglena -derived material, about 5% to about 10% pea protein, water, and one or more additional ingredient, wherein the liquid egg formulation comprises one or more functional property of a natural egg.
- Embodiments described hereinare directed to a liquid egg formulation comprising about 1% to about 100% fresh Euglena -derived material, about 0.05% to about 70% additional protein source, water, and one or more additional ingredient, wherein the liquid egg formulation comprises one or more functional property of a natural egg.
- the additional protein sourceis selected from the group consisting of pea protein, soy protein, corn protein, wheat protein, rice protein, beans protein, seed protein, nut protein, almond protein, peanut protein, instantan protein, lentil protein, chickpea protein, flaxseed protein, wild rice protein, quorn protein, chia seed protein, quinoa protein, oat protein, fava bean protein, buckwheat protein, bulgar protein, millet protein, microalgae protein, yellow pea protein, mung bean protein, hemp protein, sunflower protein, canola protein, lupin protein, legumes protein, potato protein, and combinations thereof.
- the additional protein sourceis in an amount of about 0.05% to about 70%, about 0.5% to about 70%, about 1% to about 70%, about 5% to about 70%, about 10% to about 70%, about 15% to about 70%, about 0.05% to about 60%, about 0.05% to about 50%, about 0.05% to about 40%, about 0.05% to about 30%, or about 0.05% to about 20%.
- the additional protein sourceis in an amount of about 0.05% to about 15%. In certain embodiments of the liquid egg formulation described herein, the additional protein source is in an amount of about 20% to about 60%.
- the fresh Euglena -derived materialis in an amount of about 5% to about 90%, about 50% to about 85%, about 50% to about 75%, about 50% to about 65%, about 60% to about 85%, or about 70% to about 85% in the liquid mixture. In certain embodiments, the fresh Euglena -derived material is in an amount of about 55% in the liquid mixture. In certain embodiments, the fresh Euglena -derived material is in an amount of about 62% in the liquid mixture. In certain embodiments, the fresh Euglena -derived material is in an amount of about 7% in the liquid mixture. In certain embodiments, the fresh Euglena -derived material is in an amount of about 40% to about 87% in the liquid mixture. In certain embodiments, the fresh Euglena -derived material is in an amount of about 40% to about 90% in the liquid mixture.
- the pea proteinis in an amount of about 5% to about 10%, about 5% to about 15%, about 5% to about 20%, about 5% to about 25%, or about 7.5% to about 10% in the liquid mixture. In certain embodiments, the pea protein is in an amount of about 5.5% in the dry mixture. In certain embodiments, the pea protein is in an amount of about 6% in the dry mixture.
- the fresh Euglena -derived materialis selected from the group consisting of a fresh Euglena biomass, Euglena -derived protein, a protein-rich flour derived from Euglena , a protein concentrate derived from Euglena , a protein isolate derived from Euglena, Euglena -derived beta-glucan isolate, Euglena -derived oils, and combinations thereof.
- the one or more additional ingredientis selected from the group consisting of gellan gum, methylcellulose, yeast extract, baking powder, sunflower lecithin, tranglutaminase, flavoring, and combinations thereof.
- the one or more additional ingredientis selected from the group consisting of water, gellan gum, methylcellulose, yeast extract, flavoring, antioxidant blend, maskers, leavening agents, baking powder, baking soda, enzymes, transglutaminase, emulsifiers, lecithin, mono- and diglycerides, binders, carrot fiber, defatted linseed flour, and combinations thereof.
- each of the one or more additional ingredientis in an amount of about 0.05% to about 5%, about 0.05% to about 4%, or about 0.05% to about 3%, or about 0.05% to about 2%. In certain embodiments of the liquid egg formulation described herein, each of the one or more additional ingredient is in an amount of about 0.1% to about 1%.
- the liquid egg formulationfurther comprises an oil.
- the oilcan be selected from the group consisting of vegetable oil, soybean oil, coconut oil, olive oil, peanut oil, fish oil, avocado oil, palm oil, flax oil, corn oil, cottonseed oil, canola oil, rapeseed oil, sunflower oil, safflower oil, sesame oil, grapeseed oil, safflower oil, rice bran oil, propionate, palm kernel oil, cuphea oil, camelina sativa oil, mustard seed oil, cashew nut oil, oat oil, lupine oil, kenaf oil, calendula oil, hemp oil, coffee oil, linseed oil, hazelnut oil, euphorbia oil, pumpkin seed oil, coriander oil, camellia oil, rice oil, tung oil tree oil, cocoa oil, copra oil, opium poppy oil, castor bean oil, pecan oil, jojoba oil, jatropha oil
- the flavoringis selected from the group consisting of black salt, black pepper, Himalayan sea salt, salt, onion powder, minced onion, roasted garlic, mushroom powder, yeast extract, or a combination thereof. In some embodiments, the liquid egg formulation described herein the flavoring is black salt and onion powder.
- the liquid egg formulationfurther comprises one or more hydrocolloids.
- each of the one or more hydrocolloidsmay be selected from the group consisting of locust bean gum, a guar gum, a konjac gum, a gellan gum, a high methoxy pectin, a low methoxy pectin, an Agar, a kappa carrageenan, an iota carrageenan, a lambda carrageenan, an alginate, a curdlan, a methyl cellulose, a carboxymethyl cellulose (CMC), a xanthan gum, a gum Arabic, a Euglena derived beta-glucan and combinations thereof.
- CMCcarboxymethyl cellulose
- each of the one or more hydrocolloidsis in an amount of about 0.05% to about 8%, about 0.1% to about 8%, about 0.05% to about 7%, about 0.05% to about 6%, about 0.05% to about 5%, about 0.05% to about 4%, or about 0.05% to about 3%. In certain embodiments of the liquid egg formulation described herein, each of the one or more hydrocolloids is in an amount of about 0.1% to about 2%.
- the liquid egg formulationcontains at least 3.0 g of protein, at least 3.5 g of protein, at least 4.0 g of protein, at least 4.5 g of protein, at least 5.0 g of protein, at least 5.5 g of protein, at least 6.0 g of protein, at least 6.5 g of protein, at least 7.0 g of protein, at least 7.5 g of protein, at least 8.0 g of protein, at least 8.5 g of protein, or at least 9.0 g of protein.
- the liquid egg formulationcontains at least 5 g of protein.
- the liquid egg formulationcontains at least 7.5 g of protein.
- the liquid egg formulationhas a ratio of fresh Euglena -derived material to pea protein of about 15:1 to about 5:1. In some embodiments, the liquid egg formulation has a ratio of fresh Euglena -derived material to pea protein of about 7.5:1 to about 5:1. In some embodiments the liquid egg formulation has a ratio of fresh Euglena -derived material to pea protein of about 15:1 to about 7.5:1. In certain embodiments the liquid egg formulation has a ratio of fresh Euglena -derived material to pea protein of about 10:1.
- the wateris in an amount of about 10% to about 35%, about 15% to about 35%, about 20% to about 35%, about 25% to about 35%, about 10% to about 30%, about 10% to about 25%, about 0.05% to about 80%, about 60% to about 85%, about 65% to about 80%, or about 70% to about 75% of the liquid egg formulation.
- the wateris in an amount of about 33% of the liquid egg formulation.
- the wateris in an amount of about 24% of the liquid egg formulation.
- the wateris about 10% to about 50% of the liquid egg formulation.
- the wateris about 50% to about 80% of the liquid egg formulation.
- the oilis in an amount of about 2.5% to about 7.5%, about 3.0% to about 7.5%, about 3.5% to about 7.5%, about 4.0% to about 7.5%, about 4.5% to about 7.5%, about 2.5% to about 7.0%, about 2.5% to about 6.5%, about 2.5% to about 6.0%, or about 2.5% to about 5.5%.
- the oilis in an amount of about 4.5%.
- the oilis in an amount of about 5%.
- the oilis in an amount of about 0.05% to about 10%.
- the oilis in an amount of about 0.05% to about 20%.
- the gellan gumis in an amount of 0.2% to about 1%, amount of 0.3% to about 1%, amount of 0.4% to about 1%, amount of 0.2% to about 0.9%, amount of 0.2% to about 0.8%, amount of 0.2% to about 0.7%, or amount of 0.2% to about 0.6%. In certain embodiments of the liquid egg formulation described herein, the gellan gum is in an amount of about 0.44%. In certain embodiments of the liquid egg formulation described herein, the gellan gum is in an amount of about 0.50%.
- the methylcelluloseis in an amount of about 0.5% to about 1%, about 0.6% to about 1%, about 0.5% to about 0.9%, or about 0.5% to about 0.8%. In certain embodiments of the liquid egg formulation described herein, the methylcellulose is in an amount of about 0.66%. In certain embodiments of the liquid egg formulation described herein, the methylcellulose is in an amount of about 0.77%.
- the ratio of gellan gum to methyl celluloseis about 1:5, about 2:5, about 1:4, or about 1:3. In certain embodiments of the liquid egg formulation described herein, the ratio of gellan gum to methyl cellulose is about 2:3.
- the yeast extractis in an amount of about 0.2% to about 0.5%, about 0.3% to about 0.5%, or about 0.2% to about 0.4%. In certain embodiments of the liquid egg formulation described herein, the yeast extract is in an amount of about 0.33%. In certain embodiments of the liquid egg formulation described herein, the yeast extract is in an amount of about 0.37%.
- the baking powderis in an amount of about 0.1% to about 0.5%, about 0.2% to about 0.5%, about 0.1% to about 0.4%, or about 0.1% to about 0.3%. In certain embodiments of the liquid egg formulation described herein, the baking powder is in an amount of about 0.22%. In certain embodiments of the liquid egg formulation described herein, the baking powder is in an amount of about 0.25%.
- the sunflower lecithinis in an amount of about 0.1% to about 0.5%, about 0.2% to about 0.5%, about 0.1% to about 0.4%, or about 0.1% to about 0.3%. In certain embodiments of the liquid egg formulation described herein, the sunflower lecithin is in an amount of about 0.29%.
- the transglutaminaseis in an amount of about 0.1% to about 0.5%, about 0.2% to about 0.5%, about 0.1% to about 0.4%, or about 0.1% to about 0.3%. In certain embodiments of the liquid egg formulation described herein, the transglutaminase is in an amount of about 0.25%.
- the flavoringis in an amount of about 0.05% to about 0.5%, about 0.1% to about 0.5%, about 0.1% to about 0.4%, or about 0.1% to about 0.3%. In certain embodiments of the liquid egg formulation described herein, the flavoring is in an amount of about 0.3%. In certain embodiments of the liquid egg formulation described herein, the flavoring is in an amount of about 0.1% to about 1%.
- the liquid egg formulationhas one or more functional property of a natural egg.
- the liquid egg formulationhas at least 2 functional properties of a natural egg.
- the one or more functional property of a natural eggis selected from the group consisting of complete nutrition, protein digestibility-corrected amino acid score (PDCAAS), gelation, foaming, viscosity, emulsification, water binding capacity, texture, elasticity, springiness, solubility, flavor, coagulation, aeration, creaminess, film forming property, sheen addition, shine addition, freeze stability, thaw stability, color, and combinations thereof
- the liquid egg described hereinhas the consistency necessary to replace a natural egg in any food application.
- the liquid egg described hereinhas a property similar to a natural egg selected from the group consisting of emulsifying properties, viscosity, consistency, elasticity, springiness, solubility, coagulation, aeration, creaminess, film forming property, sheen addition, shine addition, and combinations thereof. Accordingly, the liquid egg described herein cooks in about the same time as a natural egg.
- Embodiments described hereinare directed to a liquid egg formulation comprising about 12% to about 95% Euglena -derived wet protein concentrate, about 1% to about 20% solid content, water, and one or more additional ingredient, wherein the liquid egg formulation comprises one or more functional property of a natural egg.
- Embodiments described hereinare directed to a liquid egg formulation comprising about 1% to about 100% Euglena -derived wet protein concentrate, about 1% to about 20% solid content, an additional protein source, water, and one or more additional ingredient, wherein the liquid egg formulation comprises one or more functional property of a natural egg.
- the additional protein sourceis selected from the group consisting of pea protein, soy protein, corn protein, wheat protein, rice protein, beans protein, seed protein, nut protein, almond protein, peanut protein, instantan protein, lentil protein, chickpea protein, flaxseed protein, wild rice protein, quorn protein, chia seed protein, quinoa protein, oat protein, fava bean protein, buckwheat protein, bulgar protein, millet protein, microalgae protein, yellow pea protein, mung bean protein, hemp protein, sunflower protein, canola protein, lupin protein, legumes protein, potato protein, and combinations thereof.
- the additional protein sourceis in an amount of about 0.05% to about 70%, about 0.5% to about 70%, about 1% to about 70%, about 5% to about 70%, about 10% to about 70%, about 15% to about 70%, about 0.05% to about 60%, about 0.05% to about 50%, about 0.05% to about 40%, about 0.05% to about 30%, or about 0.05% to about 20%.
- the additional protein sourceis in an amount of about 0.05% to about 15%. In certain embodiments of the liquid egg formulation described herein, the additional protein source is in an amount of about 20% to about 60%.
- the Euglena -derived wet protein concentrateis in an amount of about 5% to about 90%, about 15% to about 95%, about 20% to about 95%, about 25% to about 95%, about 30% to about 95%, about 30% to about 95%, about 35% to about 95%, about 40% to about 95%, about 45% to about 95%, about 50% to about 95%, about 55% to about 95%, in the liquid mixture.
- the Euglena -derived wet protein concentrateis in an amount of about 94% in the liquid mixture.
- the Euglena -derived wet protein concentrateis in an amount of about 56% in the liquid mixture.
- the Euglena -derived wet protein concentrateis in an amount of about 7% in the liquid mixture. In certain embodiments, the Euglena -derived wet protein concentrate is in an amount of about 40% to about 87% in the liquid mixture. In certain embodiments, the Euglena -derived wet protein concentrate is in an amount of about 40% to about 90% in the liquid mixture.
- the solid contentis in an amount of about 1% to about 20%, about 2% to about 20%, about 3% to about 20%, about 4% to about 20%, about 5% to about 20%, about 1% to about 19%, about 1% to about 18%, about 1% to about 17%, about 1% to about 16%, or about 1% to about 15%. In certain embodiments of the liquid egg formulation described herein, the solid content is in an amount of about 5%. In certain embodiments of the liquid egg formulation described herein, the solid content is in an amount of about 15%.
- the Euglena -derived wet protein concentrateis an Euglena -derived protein isolate.
- the Euglena -derived wet protein concentrateis about 25% to about 80% protein, about 30% to about 80% protein, about 35% to about 80% protein, about 40% to about 80% protein, about 45% to about 80% protein, about 50% to about 80% protein, about 55% to about 80% protein, about 60% to about 80% protein, about 65% to about 80% protein, or about 25% to about 75% protein. In certain embodiments, the Euglena -derived wet protein concentrate is about 70% protein.
- the one or more additional ingredientis selected from the group consisting of an oil, water, gellan gum, methylcellulose, yeast extract, baking powder, sunflower lecithin, flavoring, and combinations thereof.
- the one or more additional ingredientis selected from the group consisting of gellan gum, methylcellulose, yeast extract, flavoring, antioxidant blend, maskers, leavening agents, baking powder, baking soda, enzymes, transglutaminase, emulsifiers, lecithin, mono- and diglycerides, binders, carrot fiber, defatted linseed flour, and combinations thereof.
- each of the one or more additional ingredientis in an amount of about 0.05% to about 5%, about 0.05% to about 4%, or about 0.05% to about 3%, or about 0.05% to about 2%. In certain embodiments of the liquid egg formulation described herein, each of the one or more additional ingredient is in an amount of about 0.1% to about 1%.
- the liquid egg formulationfurther comprises an oil.
- the oilcan be selected from the group consisting of vegetable oil, soybean oil, coconut oil, olive oil, peanut oil, fish oil, avocado oil, palm oil, flax oil, corn oil, cottonseed oil, canola oil, rapeseed oil, sunflower oil, safflower oil, sesame oil, grapeseed oil, safflower oil, rice bran oil, propionate, palm kernel oil, cuphea oil, camelina sativa oil, mustard seed oil, cashew nut oil, oat oil, lupine oil, kenaf oil, calendula oil, hemp oil, coffee oil, linseed oil, hazelnut oil, euphorbia oil, pumpkin seed oil, coriander oil, camellia oil, rice oil, tung oil tree oil, cocoa oil, copra oil, opium poppy oil, castor bean oil, pecan oil, jojoba oil, jatropha oil
- the flavoringis selected from the group consisting of black salt, black pepper, Himalayan sea salt, salt, onion powder, minced onion, roasted garlic, mushroom powder, yeast extract, or a combination thereof. In some embodiments, the liquid egg formulation described herein the flavoring is black salt and onion powder.
- the liquid egg formulationfurther comprises one or more hydrocolloids.
- the one or more hydrocolloidsmay be selected from the group consisting of locust bean gum, a guar gum, a konjac gum, a gellan gum, a high methoxy pectin, a low methoxy pectin, an Agar, a kappa carrageenan, an iota carrageenan, a lambda carrageenan, an alginate, a curdlan, a methyl cellulose, a carboxymethyl cellulose (CMC), a xanthan gum, a gum Arabic, a Euglena derived beta-glucan and combinations thereof.
- CMCcarboxymethyl cellulose
- each of the one or more hydrocolloidsis in an amount of about 0.05% to about 8%, about 0.1% to about 8%, about 0.05% to about 7%, about 0.05% to about 6%, about 0.05% to about 5%, about 0.05% to about 4%, or about 0.05% to about 3%. In certain embodiments of the liquid egg formulation described herein, each of the one or more hydrocolloids is in an amount of about 0.1% to about 2%.
- the liquid egg formulationcontains at least 3.0 g of protein, at least 3.5 g of protein, at least 4.0 g of protein, at least 4.5 g of protein, at least 5.0 g of protein, at least 5.5 g of protein, at least 6.0 g of protein, at least 6.5 g of protein, at least 7.0 g of protein, at least 7.5 g of protein, at least 8.0 g of protein, at least 8.5 g of protein, or at least 9.0 g of protein.
- the liquid egg formulationcontains at least 5.6 g of protein.
- the liquid egg formulationcontains at least 5 g of protein.
- the ratio of Euglena -derived wet protein concentrate to solid contentis about 95:1 to about 1.6:1, about 70:1 to about 1.6:1, about 45:1 to about 1.6:1, about 20:1 to about 1.6:1, about 10:1 to about 1.6:1, or about 5:1 to about 1.6:1. In certain embodiments of the liquid egg formulation described herein, the ratio of Euglena -derived wet protein concentrate to solid content is about 3.7:1.
- the oilis in an amount of about 0.05% to about 20%, about 2.5% to about 7.5%, about 3.0% to about 7.5%, about 3.5% to about 7.5%, about 4.0% to about 7.5%, about 4.5% to about 7.5%, about 2.5% to about 7.0%, about 2.5% to about 6.5%, about 2.5% to about 6.0%, or about 2.5% to about 5.5%.
- the oilis in an amount of about 5%.
- the oilis in an amount of about 4.5%.
- the oilis in an amount of about 0.05% to about 10%.
- the wateris in an amount of about 10% to about 50%, about 15% to about 50%, about 20% to about 50%, about 25% to about 50%, about 30% to about 50%, about 35% to about 50%, about 10% to about 45%, about 10% to about 40%, about 0.05% to about 80%, about 60% to about 85%, about 65% to about 80%, or about 70% to about 75% of the liquid egg formulation. In certain embodiments of the liquid egg formulation described herein, the water is in an amount of about 37% of the liquid egg formulation of the liquid egg formulation. In certain embodiments, the water is about 10% to about 50% of the liquid egg formulation. In certain embodiments, the water is about 50% to about 80% of the liquid egg formulation. In certain embodiments, the water is about 0.05% to about 80% of the liquid egg formulation.
- the gellan gumis in an amount of 0.1% to about 1%, amount of 0.2% to about 1%, amount of 0.1% to about 0.9%, amount of 1% to about 0.8%, amount of 0.1% to about 0.7%, amount of 0.1% to about 0.6%, or amount of 0.1% to about 0.5%. In certain embodiments of the liquid egg formulation described herein, the gellan gum is in an amount of about 0.23%. In certain embodiments of the liquid egg formulation described herein, the gellan gum is in an amount of about 0.46%.
- the methylcelluloseis in an amount of about 0.1% to about 1.25%, about 0.2% to about 1.25%, about 0.3% to about 1.25%, about 0.1% to about 1%, about 0.1% to about 0.8%, or about 0.1% to about 0.8%. In certain embodiments of the liquid egg formulation described herein, the methylcellulose is in an amount of about 0.35%. In certain embodiments of the liquid egg formulation described herein, the methylcellulose is in an amount of about 0.83%.
- the ratio of gellan gum to methyl celluloseis about 1:10, about 2:10, about 1:9, or about 2:9. In certain embodiments of the liquid egg formulation described herein, the ratio of gellan gum to methyl cellulose is about 2:3. In certain embodiments of the liquid egg formulation described herein, the ratio of gellan gum to methyl cellulose is about 5:9.
- the yeast extractis in an amount of about 0.1% to about 0.5%, about 0.2% to about 0.5%, about 0.1% to about 0.4%, or about 0.1% to about 0.3%. In certain embodiments of the liquid egg formulation described herein, the yeast extract is in an amount of about 0.23%. In certain embodiments of the liquid egg formulation described herein, the yeast extract is in an amount of about 0.28%.
- the baking powderis in an amount of about 0.1% to about 0.75%, about 0.2% to about 0.75%, about 0.1% to about 0.7%, 0.1% to about 0.6%, 0.1% to about 0.5%, or about 0.1% to about 0.4%. In certain embodiments of the liquid egg formulation described herein, the baking powder is in an amount of about 0.23%. In certain embodiments of the liquid egg formulation described herein, the baking powder is in an amount of about 0.46%.
- the sunflower lecithinis in an amount of about 0.1% to about 0.5%, about 0.2% to about 0.5%, about 0.1% to about 0.4%, or about 0.1% to about 0.3%. In certain embodiments of the liquid egg formulation described herein, the sunflower lecithin is in an amount of about 0.23%. In certain embodiments of the liquid egg formulation described herein, the sunflower lecithin is in an amount of about 0.28%.
- the flavoringis in an amount of about 0.05% to about 0.5%, about 0.05% to about 0.4%, about 0.1% to about 0.5%, about 0.15% to about 0.5%, or about 0.2% to about 0.5%. In certain embodiments of the liquid egg formulation described herein, the flavoring is in an amount of about 0.25%. In certain embodiments of the liquid egg formulation described herein, the flavoring is in an amount of about 0.46%. In certain embodiments of the liquid egg formulation described herein, the flavoring is in an amount of about 0.1% to about 1%.
- the liquid egg formulationhas one or more functional property of a natural egg.
- the liquid egg formulationhas at least 2 functional properties of a natural egg.
- the one or more functional property of a natural eggis selected from the group consisting of complete nutrition, protein digestibility-corrected amino acid score (PDCAAS), gelation, foaming, viscosity, emulsification, water binding capacity, texture, elasticity, springiness, solubility, flavor, coagulation, aeration, creaminess, film forming property, sheen addition, shine addition, freeze stability, thaw stability, color, and combinations thereof.
- PDCAASprotein digestibility-corrected amino acid score
- the dry egg replacement, egg replacement emulsion, liquid egg, or liquid egg formulation described hereinfurther comprise one or more maskers.
- the maskerscan be purchased from Firmenich, IFF, Givaudan, Symrise, Mane, Fona, Flavor producer, McCormick, edlong, T ⁇ Hasegawa. Sensient Flavors, Robertet SA, Prova, Wild/ADM, Takasago, Synergy, and others.
- the egg replacement formulation described hereinhas the consistency necessary to replace a natural egg in any food application.
- the liquid egg described hereinhas a property similar to a natural egg selected from the group consisting of emulsifying properties, viscosity, consistency, elasticity, springiness, solubility, coagulation, aeration, creaminess, film forming property, sheen addition, shine addition, and combinations thereof. Accordingly, the egg replacement formulation described herein cooks in about the same time as a natural egg.
- Embodiments described hereinare directed to an egg replacement formulation comprising about 1% to about 100% Euglena -derived material, about 0.05% to about 70% additional protein source, and one or more additional ingredient, wherein the egg replacement formulation comprises one or more functional property of a natural egg.
- the Euglena -derived materialis a dry material. In some embodiments of the egg replacement formulation described herein, the Euglena -derived material is a wet material.
- the Euglena -derived materialis selected from the group consisting of a fresh Euglena biomass, a Euglena biomass, a Euglena -derived protein, a protein-rich flour derived from Euglena , a protein concentrate derived from Euglena , a protein isolate derived from Euglena , a Euglena -derived beta-glucan isolate, a Euglena -derived oil, a Euglena -derived wet protein concentrate, a Euglena -derived protein isolate and combinations thereof.
- the Euglena -derived materialis in an amount of about 5% to about 90%, about 50% to about 85%, about 50% to about 75%, about 50% to about 65%, about 60% to about 85%, or about 70% to about 85% in the mixture. In certain embodiments, the Euglena -derived material is in an amount of about 55% in the mixture. In certain embodiments, the Euglena -derived material is in an amount of about 62% in the mixture. In certain embodiments, the Euglena -derived material is in an amount of about 7% in the mixture. In certain embodiments, the Euglena -derived material is in an amount of about 40% to about 87% in the mixture. In certain embodiments, the Euglena -derived material is in an amount of about 40% to about 90% in the mixture.
- the additional protein sourceis selected from the group consisting of pea protein, soy protein, corn protein, wheat protein, rice protein, beans protein, seed protein, nut protein, almond protein, peanut protein, instantan protein, lentil protein, chickpea protein, flaxseed protein, wild rice protein, quorn protein, chia seed protein, quinoa protein, oat protein, fava bean protein, buckwheat protein, bulgar protein, millet protein, microalgae protein, yellow pea protein, mung bean protein, hemp protein, sunflower protein, canola protein, lupin protein, legumes protein, potato protein, and combinations thereof.
- the additional protein sourceis in an amount of about 0.05% to about 70%, about 0.5% to about 70%, about 1% to about 70%, about 5% to about 70%, about 10% to about 70%, about 15% to about 70%, about 0.05% to about 60%, about 0.05% to about 50%, about 0.05% to about 40%, about 0.05% to about 30%, or about 0.05% to about 20%.
- the additional protein sourceis in an amount of about 0.05% to about 15%. In certain embodiments of the egg replacement formulation described herein, the additional protein source is in an amount of about 20% to about 60%.
- the one or more additional ingredientis selected from the group consisting of gellan gum, methylcellulose, yeast extract, flavoring, antioxidant blend, maskers, leavening agents, baking powder, baking soda, enzymes, transglutaminase, emulsifiers, lecithin, mono- and diglycerides, binders, carrot fiber, defatted linseed flour, and combinations thereof.
- each of the one or more additional ingredientis in an amount of about 0.05% to about 5%, about 0.05% to about 4%, or about 0.05% to about 3%, or about 0.05% to about 2%. In certain embodiments of the egg replacement formulation described herein, each of the one or more additional ingredient is in an amount of about 0.1% to about 1%.
- the egg replacement formulationfurther comprises an oil.
- the oilcan be selected from the group consisting of vegetable oil, soybean oil, coconut oil, olive oil, peanut oil, fish oil, avocado oil, palm oil, flax oil, corn oil, cottonseed oil, canola oil, rapeseed oil, sunflower oil, safflower oil, sesame oil, grapeseed oil, safflower oil, rice bran oil, propionate, palm kernel oil, cuphea oil, camelina sativa oil, mustard seed oil, cashew nut oil, oat oil, lupine oil, kenaf oil, calendula oil, hemp oil, coffee oil, linseed oil, hazelnut oil, euphorbia oil, pumpkin seed oil, coriander oil, camellia oil, rice oil, tung oil tree oil, cocoa oil, copra oil, opium poppy oil, castor bean oil, pecan oil, jojoba oil, jatropha oil
- the oilis in an amount of about 0.05% to about 20%, about 2.5% to about 7.5%, about 3.0% to about 7.5%, about 3.5% to about 7.5%, about 4.0% to about 7.5%, about 4.5% to about 7.5%, about 2.5% to about 7.0%, about 2.5% to about 6.5%, about 2.5% to about 6.0%, or about 2.5% to about 5.5%.
- the oilis in an amount of about 5%.
- the oilis in an amount of about 4.5%.
- the oilis in an amount of about 0.05% to about 10%.
- the egg replacement formulationfurther comprises one or more hydrocolloids.
- the one or more hydrocolloidsmay be selected from the group consisting of locust bean gum, a guar gum, a konjac gum, a gellan gum, a high methoxy pectin, a low methoxy pectin, an Agar, a kappa carrageenan, an iota carrageenan, a lambda carrageenan, an alginate, a curdlan, a methyl cellulose, a carboxymethyl cellulose (CMC), a xanthan gum, a gum Arabic, a Euglena derived beta-glucan and combinations thereof.
- CMCcarboxymethyl cellulose
- each of the one or more hydrocolloidsis in an amount of about 0.05% to about 8%, about 0.1% to about 8%, about 0.05% to about 7%, about 0.05% to about 6%, about 0.05% to about 5%, about 0.05% to about 4%, or about 0.05% to about 3%. In certain embodiments of the egg replacement formulation described herein, each of the one or more hydrocolloids is in an amount of about 0.1% to about 2%.
- the egg replacement formulationfurther comprises flavoring.
- the flavoringis selected from the group consisting of black salt, black pepper, Himalayan sea salt, salt, onion powder, minced onion, roasted garlic, mushroom powder, yeast extract, or a combination thereof.
- the egg replacement formulation described herein the flavoringis black salt and onion powder.
- the flavoringis in an amount of about 0.05% to about 0.5%, about 0.05% to about 0.4%, about 0.1% to about 0.5%, about 0.15% to about 0.5%, or about 0.2% to about 0.5%. In certain embodiments of the egg replacement formulation described herein, the flavoring is in an amount of about 0.25%. In certain embodiments of the egg replacement formulation described herein, the flavoring is in an amount of about 0.46%. In certain embodiments of the egg replacement formulation described herein, the flavoring is in an amount of about 0.1% to about 1%.
- the egg replacement formulationfurther comprises water.
- the wateris in an amount of about 10% to about 50%, about 15% to about 50%, about 20% to about 50%, about 25% to about 50%, about 30% to about 50%, about 35% to about 50%, about 10% to about 45%, about 10% to about 40%, about 0.05% to about 80%, about 60% to about 85%, about 65% to about 80%, or about 70% to about 75% of the egg replacement formulation.
- the wateris in an amount of about 37% of the egg replacement formulation of the egg replacement formulation.
- the wateris about 10% to about 50% of the egg replacement formulation.
- the wateris about 50% to about 80% of the egg replacement formulation.
- the wateris about 0.05% to about 80% of the egg replacement formulation.
- the dry egg replacement composition, egg replacement emulsion, liquid egg, liquid egg formulation, or egg replacement formulation described hereinhas improved product safety.
- the improved product safetyis from a reduction of microbial spoilage.
- the microbial spoilageis from bacteria, yeast, mold, or a combination thereof.
- the reduction of microbial spoilageis from pasteurization, storage pH, antimicrobial treatment, or a combination thereof.
- the pasteurizationis carried out at a temperature of about 40° C., about 45° C., about 50° C., about 55° C., about 60° C., about 65° C., about 70° C., about 75° C., about 80° C., about 85° C., about 90° C., about 95° C., about 100° C., or a range between any two of these values.
- the pasteurizationis carried out for about 10 min, about 15 min, about 20 min, about 25 min, about 30 min, about 35 min, about 40 min, about 45 min, about 50 min, about 55 min, about 60 min, or a range between any two of these values.
- the storage pHis about pH 2.5, about pH 3.0, about pH 3.5, about pH 4.0, about pH 4.5, about pH 5.0, about pH 5.5, about pH 6.0, about pH 6.5, about pH 7.0, about pH 7.5, about pH 8.0, or a range between any two of these values.
- the antimicrobial treatmentis carried out with an antimicrobial agent.
- the antimicrobial agentis selected from the group consisting of nisin, calcium propionate, sodium benzoate, potassium sorbate, Bio Vontage 2662, organic acids, or a combination thereof
- Embodiments described hereinare directed to methods of preparing a vegan-egg scramble comprising combining a dry egg replacement composition, an oil, and water.
- the dry egg replacement compositionis in an amount of about 5% to about 50%, about 10% to about 40%, about 15% to about 30%, or about 20% to about 25% in the vegan-egg scramble. In certain embodiments, the dry egg replacement composition is in an amount of about 9 g to about 15 g, about 10 g to about 14 g, about 11 g to about 13 g, or about 12 g to about 12.5 g in the vegan-egg scramble. In certain embodiments, the dry egg replacement composition is in an amount of about 12.5 g in the vegan-egg scramble.
- the oilis in an amount of about 5% to about 20%, about 8% to about 18%, about 10% to about 16%, or about 14% to about 14% of the oil is used in the vegan-egg scramble. In certain embodiments, the oil is in an amount of about 1 tablespoon to about 3 tablespoons in the vegan-egg scramble. In some embodiments, the oil is in an amount of about 1 tablespoon, about 2 tablespoons, or about 3 tablespoons in the vegan-egg scramble.
- the oilcan be selected from the group consisting of vegetable oil, soybean oil, coconut oil, olive oil, peanut oil, fish oil, avocado oil, palm oil, flax oil, corn oil, cottonseed oil, canola oil, rapeseed oil, sunflower oil, safflower oil, sesame oil, grapeseed oil, safflower oil, rice bran oil, propionate, palm kernel oil, cuphea oil, camelina sativa oil, mustard seed oil, cashew nut oil, oat oil, lupine oil, kenaf oil, calendula oil, hemp oil, coffee oil, linseed oil, hazelnut oil, euphorbia oil, pumpkin seed oil, coriander oil, camellia oil, rice oil, tung oil tree oil, cocoa oil, copra oil, opium poppy oil, castor bean oil, pecan oil, jojoba oil, jatropha oil, macadamia oil, Brazil nut oil, Euglena derived oil and combinations
- the wateris in an amount of about 60% to about 85%, about 65% to about 80%, or about 70% to about 75% in the vegan-egg scramble. In certain embodiments, the water is in an amount of about 1 ⁇ 4 cup to about 1 cup in the vegan-egg scramble. In some embodiments, the water is in an amount of about 1 ⁇ 4 cup, about 1 ⁇ 4 cup, about 1 ⁇ 4 cup, 2 ⁇ 3 cup, 3 ⁇ 4 cup, or 1 cup in the vegan-egg scramble.
- the egg scrambleis prepared by mixing the dry egg replacement composition with about 1 tablespoon to about 3 tablespoons of oil and about 1 ⁇ 4 cup to about 1 cup of water. The solution is mixed thoroughly by shaking or stirring and poured into a preheated frying pan. The egg scramble is cooked for about 3 minutes to about 6 minutes while being broken up with a spatula. In some embodiments, the vegan-egg scramble is cooked for about 3 minutes, about 4 minutes, about 5 minutes, or about 6 minutes.
- Embodiments described hereinare directed to food products comprising the dry egg replacement composition, egg replacement emulsion, liquid egg, liquid egg formulation, or egg replacement formulation described herein in place of natural eggs.
- the food products disclosed hereinare illustrative examples of what can be done with the egg replacement disclosed herein and that Euglena egg is a functional egg substitute that can replace natural/whole eggs in all applications by incorporating an Euglena egg substitute.
- about 0.5 to about 1.5 dry egg replacement composition, egg replacement emulsion, liquid egg, or liquid egg formulation described hereincan replace 1 natural chicken egg.
- about 1 dry egg replacement composition, egg replacement emulsion, liquid egg, or liquid egg formulation described hereincan replace 1 natural chicken egg.
- an organoleptic propertyis attributed to the food product from the dry egg replacement composition, egg replacement emulsion, liquid egg, liquid egg formulation, or egg replacement formulation described herein, which is similar or equivalent to the organoleptic property provided by a natural egg.
- the dry egg replacement composition, egg replacement emulsion, liquid egg, liquid egg formulation, or egg replacement formulationprovides a flavor, an aroma, a sensory impression, or combinations thereof that is similar or equivalent to the flavor, aroma, or sensory impression of a reference food product.
- the dry egg replacement composition, egg replacement emulsion, liquid egg, liquid egg formulation, or egg replacement formulation described hereinmay be incorporated into an egg scramble, an egg patty, an omelet, a quiche, frittata, egg-free cake, such as a chocolate cake, a pound cake, a yellow cake, an angel food cake, a cream cheese analog, a pasta dough, a pasta, a milk, an ice cream, a custard, a frozen dessert (e.g., a frozen dessert comprising ice cream), or a confection.
- an egg scramblean egg patty, an omelet, a quiche, frittata, egg-free cake, such as a chocolate cake, a pound cake, a yellow cake, an angel food cake, a cream cheese analog, a pasta dough, a pasta, a milk, an ice cream, a custard, a frozen dessert (e.g., a frozen dessert comprising ice cream), or a confection.
- the dry egg replacement composition, egg replacement emulsion, liquid egg, liquid egg formulation, or egg replacement formulation described hereinmay be incorporated into meat as a meat binder/extender, i.e. it may be used to bind a grain like oats to extend ground beef in meatballs, structured meat pieces or meatloaf, or even commercial hamburgers.
- the dry egg replacement composition, egg replacement emulsion, liquid egg, liquid egg formulation, or egg replacement formulation described hereinmay be used as a retort stabilizer in canning process for pasta and structured meat pieces in soup/Chile. It can be used in dog food to prevent break down and loss of texture during the retort cooking/canning process. Retorting is the in-container sterilization of food to render it shelf stable under normal non-refrigerated conditions (commercially sterile).
- the dry egg replacement composition, egg replacement emulsion, liquid egg, liquid egg formulation, or egg replacement formulation described hereinmay be used to replace egg in vegan mayonnaise as well as mayonnaise based salad dressings, also in Hollandaise sauce.
- the dry egg replacement composition described hereinmay be used by Food service as a dry replacement for liquid egg in Omelet base, French toast coating, or any other food product utilizing dry egg.
- the dry egg replacement composition, egg replacement emulsion, liquid egg, liquid egg formulation, or egg replacement formulation described hereinmay be used as part of a consumer “complete” Pancake and Waffle mixes, as well as in frozen pancakes and waffles commercially produced to protect the texture and freeze/thaw stability.
- the dry egg replacement composition, egg replacement emulsion, liquid egg, liquid egg formulation, or egg replacement formulation described hereinmay be used in Yogurt and probiotic beverages.
- the dry egg replacement composition, egg replacement emulsion, liquid egg, liquid egg formulation, or egg replacement formulation described hereinmay be used to produce non-egg “Egg crumbles” for use on salads and/or on salad bars.
- the dry egg replacement composition, egg replacement emulsion, liquid egg, liquid egg formulation, or egg replacement formulation described hereinmay be used vegan Christmas egg nog.
- the dry egg replacement composition, egg replacement emulsion, liquid egg, liquid egg formulation, or egg replacement formulation described hereinhas provided one or more functional properties to the food product when incorporated therein.
- the functional properties when incorporated into a food applicationare selected from the group consisting of crumb density, structure/texture, elasticity, springiness, coagulation, binding, moisturizing, mouthfeel, leavening, aeration/foaming, creaminess, and emulsification of the food product such as an egg.
- Mouthfeelis a concept used in the testing and description of food products.
- Products made using the dry egg replacement composition, the egg replacement emulsion, liquid egg, or liquid egg formulation described hereincan be assessed for mouthfeel.
- products, e.g., baked goods, made using dry egg replacement composition, the egg replacement emulsion, liquid egg, or liquid egg formulation described hereinhave mouthfeel that is similar to products made with natural eggs.
- the mouthfeel of the products made using the dry egg replacement composition, the egg replacement emulsion, liquid egg, or liquid egg formulation described hereinis superior to the mouthfeel of previously known or attempted egg substitutes, e.g., bananas, modified whey proteins, or Egg BeatersTM. Examples of properties which may be included in a measure of mouthfeel include:
- the egg-free cake mixcomprises flour, sugar, and the dry egg replacement composition, the egg replacement emulsion, liquid egg, or liquid egg formulation described herein.
- the egg-free cake mixfurther comprises one or more additional components selected from: cream of tartar, disodium phosphate, baking soda, and a pH stabilizing agent.
- the flourcomprises cake flour.
- an egg-free cake battercomprising an egg-free cake mix described above, and water.
- the egg-free cake batteris an egg-free pound cake batter, an egg-free angel food cake batter, or an egg-free yellow cake batter.
- the egg-free cake batterhas a specific gravity of 0.95-0.99.
- a peak height of the egg-free cakeis at least 90% of a peak height of a pound cake containing eggs.
- one or more characteristics of the egg-free cakeis similar or equivalent to one or more corresponding characteristics of a cake containing eggs.
- the one or more characteristicscomprise resilience, cohesiveness, springiness, peak height, center doming, center crack, browning, mouthfeel, spring-back, or flavor.
- the one or more characteristicscomprise hardness, resilience, cohesiveness, springiness, or chewiness. In some embodiments, the one or more characteristics comprise a functional property or an organoleptic property. In some embodiments, the functional property comprises one or more of: emulsification, water binding capacity, foaming, gelation, crumb density, structure forming, texture building, cohesion, adhesion, elasticity, springiness, solubility, viscosity, fat absorption, flavor binding, coagulation, leavening, aeration, creaminess, film forming property, sheen addition, shine addition, freeze stability, thaw stability, or color.
- an egg-free pound cake mixcomprising flour, sugar, and the dry egg replacement composition, the egg replacement emulsion, liquid egg, or liquid egg formulation described herein.
- the flourcomprises cake flour.
- the egg-free pound cake mixfurther comprises oil or fat.
- the oil or fatcomprises butter or shortening.
- at least or about 25-31% of the egg-free pound cake batteris flour.
- at least or about 25-31% of the egg-free pound cake batteris oil or fat.
- at least or about 25-31% of the egg-free pound cake batteris sugar.
- At least or about 6-12% of the egg-free pound cake batteris the dry egg replacement composition, the egg replacement emulsion, liquid egg, or liquid egg formulation described herein.
- the batterfurther comprises disodium phosphate or baking soda.
- an egg-free pound cake battercomprising an egg-free pound cake mix described above, and further comprising water.
- the egg-free pound cake battercomprises about four parts of the egg-free pound cake mix; and about one part water.
- at least or about 20-25% of the egg-free pound cake batteris flour.
- at least or about 20-25% of the egg-free pound cake batteris oil or fat.
- at least or about 20-25% of the egg-free pound cake batteris sugar.
- at least or about 5-8% of the egg-free pound cake batteris the dry egg replacement composition, the egg replacement emulsion, liquid egg, or liquid egg formulation described herein.
- at least or about 18-20% of the egg-free pound cake batteris water.
- an egg-free angel food cake mixcomprising flour, sugar, and the dry egg replacement composition, the egg replacement emulsion, liquid egg, or liquid egg formulation described herein.
- at least or about 8-16% of the egg-free angel food cake mixis flour.
- at least or about 29-42% of the egg-free angel food cake mixis sugar.
- at least or about 7-10% of the egg-free angel food cake mixis the dry egg replacement composition, the egg replacement emulsion, liquid egg, or liquid egg formulation described herein.
- the egg-free angel food cake mixfurther comprises cream of tartar, disodium phosphate, baking soda, or a pH stabilizing agent.
- the flourcomprises cake flour.
- an egg-free angel food cake battercomprising an egg-free angel food cake mix described above, and water.
- an egg-free yellow cake mixcomprising flour, sugar, and the dry egg replacement composition, the egg replacement emulsion, liquid egg, or liquid egg formulation described herein.
- at least or about 20-33% of the egg-free yellow cake mixis flour.
- at least or about 19-39% of the egg-free yellow cake mixis sugar.
- at least or about 4-7% of the egg-free yellow cake mixis the dry egg replacement composition, the egg replacement emulsion, liquid egg, or liquid egg formulation described herein.
- the egg-free yellow cake mixfurther comprises one or more of baking powder, salt, dry milk, and shortening.
- an egg-free yellow cake battercomprising an egg-free yellow cake mix described above, and water.
- Some embodimentsprovide methods to produce an egg-free pound cake using a dry egg replacement composition, the egg replacement emulsion, liquid egg, or liquid egg formulation described herein.
- a batteris created by mixing liquid solution comprising the dry egg replacement composition, the egg replacement emulsion, liquid egg, or liquid egg formulation described herein with sugar, cake flour, and butter at 17° C. to 20° C. in 1:1:1:1 w/w ratio.
- the ingredientsare blended together using single stage mixing on mixer for 6 minutes at 22° C.
- the batteris baked in pound cake pan for 45 minutes in 150° C. and cooled in pan for 2 hours at 22° C.
- Sensory quality parameters of cakes made with the dry egg replacement composition, the egg replacement emulsion, liquid egg, or liquid egg formulation described hereinare characterized as fluffy, soft, airy texture. The peak height was measured to be 90-110% of pound cake containing eggs.
- an egg-free cream cheesecomprising the dry egg replacement composition, the egg replacement emulsion, liquid egg, or liquid egg formulation described herein.
- the egg-free cream cheesecomprises one or more additional components selected from water, oil or fat, and hydrocolloid.
- at least or about 75-85% of the egg-free cream cheeseis water.
- at least or about 10-15% of the egg-free cream cheeseis the dry egg replacement composition, the egg replacement emulsion, liquid egg, or liquid egg formulation described herein.
- at least or about 5-10% of the egg-free cream cheeseis oil or fat.
- at least or about 0.1-3% of the egg-free cream cheeseis hydrocolloid.
- the hydrocolloidcomprises xanthan gum or a low-methoxy pectin and calcium chloride system.
- the egg-free cream cheesefurther comprises a flavoring or salt.
- one or more characteristics of the egg-free cream cheeseis similar or equivalent to one or more corresponding characteristics of a cream cheese containing eggs.
- the characteristicis a taste, a viscosity, a creaminess, a consistency, a smell, a spreadability, a color, a thermal stability, or a melting property.
- the characteristiccomprises a functional property or an organoleptic property.
- the functional propertycomprises: emulsification, water binding capacity, foaming, gelation, crumb density, structure forming, texture building, cohesion, adhesion, elasticity, springiness, solubility, viscosity, fat absorption, flavor binding, coagulation, leavening, aeration, creaminess, film forming property, sheen addition, shine addition, freeze stability, thaw stability, or color.
- the organoleptic propertycomprises a flavor or an odor.
- Egg-free pasta doughin another aspect, provided herein is an egg-free pasta dough comprising the dry egg replacement composition, the egg replacement emulsion, liquid egg, or liquid egg formulation described herein.
- the egg-free pasta doughcomprises one or more additional components selected from flour, oil or fat, and water.
- the flourcomprises semolina flour.
- the oil or fatcomprises extra virgin oil.
- the egg-free pasta doughfurther comprises salt.
- the egg-free pastais fresh.
- the egg-free pastais dried.
- one or more characteristics of the egg-free pastais similar or equivalent to one or more corresponding characteristics of a pasta containing eggs.
- the one or more characteristicscomprise chewiness, density, taste, cooking time, shelf life, cohesiveness, or stickiness.
- the one or more characteristicscomprise a functional property or an organoleptic property.
- the functional propertycomprises: emulsification, water binding capacity, foaming, gelation, crumb density, structure forming, texture building, cohesion, adhesion, elasticity, springiness, solubility, viscosity, fat absorption, flavor binding, coagulation, leavening, aeration, creaminess, film forming property, sheen addition, shine addition, freeze stability, thaw stability, or color.
- the organoleptic propertycomprises a flavor or an odor.
- Egg-free custardin another aspect, provided herein is an egg-free custard comprising the dry egg replacement composition, the egg replacement emulsion, liquid egg, or liquid egg formulation described herein.
- the egg-free custardcomprises one or more additional components selected from cream and sugar.
- at least or about 5% of the egg-free custardis the dry egg replacement composition, the egg replacement emulsion, liquid egg, or liquid egg formulation described herein.
- at least or about 81% of the egg-free custardis cream.
- at least or about 13% of the egg-free custardis sugar.
- the egg-free custardfurther comprises one or more of: iota-carrageenan, kappa-carrageenan, vanilla, and salt.
- the creamis heavy cream.
- Egg-free ice creamin another aspect, provided herein is an egg-free ice cream comprising the dry egg replacement composition, the egg replacement emulsion, liquid egg, or liquid egg formulation described herein.
- the egg-free ice creamis a soft-serve ice cream or a regular ice cream.
- the egg-free ice creamcomprises one or more additional components selected from cream, milk, and sugar.
- at least or about 5% of the egg-free ice creamis the dry egg replacement composition, the egg replacement emulsion, liquid egg, or liquid egg formulation described herein.
- at least or about 41% of the egg-free ice creamis cream.
- the egg-free ice creamis milk. In some embodiments, at least or about 13% of the egg-free ice cream is sugar. In some embodiments, the egg-free ice cream further comprises one or more of iota carrageenan, kappa carrageenan, vanilla, and salt. In some embodiments, the cream is heavy cream. In some embodiments, the milk is whole milk. In particular embodiments, the egg-free ice cream is lactose-free. In other particular embodiments, the egg-free ice cream does not comprise gums or stabilizers. In other embodiments, the egg-free ice provides a traditional mouthfeel and texture of an egg-based ice cream but melts at a slower rate relative to an egg-based ice cream.
- Example 1Egg Replacer with Euglena Protein Flour, Beta-Glucan Isolate, and Ready-to-Gel Powder
- the main ingredientsare starches and gums (used as binders and texturizers) accompanied by leavening agents to make up for egg white's leavening functionality in baking applications, along with some protein.
- an egg replaceris a powder or liquid egg replacer that can scramble, for use as scrambled eggs, frittatas, or omelets.
- the main ingredientswill include a plant protein (for mimicking the nutrition of the real egg), and a mixture of different gums/hydrocolloids as binder and texture developers upon cooking.
- Beta-glucan ready to gel (RTG) powderwas used as the sole hydrocolloid source to act as a binder/texturizer.
- Beta-glucan RTG powderis solubilized beta-glucan in 1 M NaOH, that has been formed into a gel with 3.75% citric acid, and then freeze dried to form a powder. When the powder is put back into water, it readily forms a thickened solution or gel, depending on the concentration.
- beta-glucan isolate in combination with the Euglena protein flourgives the egg scramble the expected yellow colour of a scrambled egg, meaning that a coloring agent is not needed in these applications.
- the addition of the beta-glucan isolatealso showed a masking effect on the Euglena protein flour off-notes compared to control mixture without the beta-glucan isolate.
- the Euglena flouris yellow which also adds to the expected yellow colour of scrambled eggs.
- the formulation that was used in this study for an egg scrambleis written in Table 1 which included the Euglena protein flour at approximately 30% protein in the flour, beta-glucan isolate from Euglena , as well as ready to gel beta-glucan powder to act as the hydrocolloid source.
- the dry ingredientsare mixed together, then water is added and mixed.
- the mixtureis whisked for 1 minute.
- the whisked mixtureis poured into a frying pan that has been set to medium heat (approximately 170° C.) and with 1 tablespoon of warmed oil (i.e. vegetable, 1 tablespoon per 100 grams of liquid egg replacer).
- the whisked mixtureis fried for about 7 to 9 minutes with a scrambling action every minute to two minutes to obtain a scrambled egg consistency.
- the mixturewas analyzed by an internal taste panel.
- the Euglena based liquid scramble egg replacerhad a yellow colour ( FIG. 1 ).
- no flavouring agent or other known flavour maskerwas added in this formulation.
- the taste panelistcould detect an umami-like taste which is due to the protein sources of the Euglena protein flour and the pea protein.
- Onion powder or salt, garlic powder or salt, and/or nutritional yeast powdercould be a flavouring agent added to improve the taste of the Euglena liquid egg replacer.
- Table 2For an improvement in taste the formulation of Table 2 was developed, which includes onion powder as well as salt.
- Euglena liquid egg replaceris seen in Table 3.
- a flour with 37% protein and 48% proteinwas investigated to determine the effects of higher protein inclusion flour.
- no beta-glucan isolate as a masker/whitening agentwas used.
- no RTG beta-glucan powderwas used as a hydrocolloid. Instead, the hydrocolloid gellan gum was added.
- a flavouring agent of onion powderis also added to improve taste of the final product.
- the mixtureall dry ingredients were mixed, including the gellan gum followed by water addition and mixing.
- the mixturewas heated to 80° C. for 1 hour, up to 2 hours for the gellan gum to hydrate and gel.
- the mixtureis poured into a frying pan that has been set to medium heat (approximately 170° C.) with 1 tablespoon of warmed oil (i.e. vegetable, 1 tablespoon per 100 grams of liquid egg replacer).
- the mixtureis fried for about 7 to 9 minutes with a scrambling action every minute to two minutes to obtain a scrambled egg consistency.
- the mixturewas analyzed by an internal taste panel. The experiment was repeated again to confirm results.
- sea saltwas replaced with black salt according to Table 5, and a vegan egg scramble with black salt is show in FIG. 2 .
- the quantities of flour; both pea protein and protein-rich Euglena flourhave been adjusted.
- the current formulacontains a 60:40 ratio of pea to Euglena flour blend. Other ratios have been experimented with; 70:30, 65:35. Only to find that the undesirable notes of the pea protein start to show through; most notably a powdery mouthfeel and pea protein flavour notes. Over the last 5 months we had been using the protein rich flour and using it as the primary flour to formulate with. However, during the last round of sensory testing it was found to have gone rancid and new protein rich flour was used to replace it. The new flours are processed differently and have a different flavour profile, most notable it is lighter on the Euglena off notes making it an ideal candidate for the vegan egg.
- Methylcellulose gumIs widely used in vegetarian products to give form to plant based proteins. And gels at a high temperature to an egg like texture but the thermal reversibility causes it to revert back to a weak gel. It works well in conjunction with gellan gum in keeping the desired egg like texture. During the gum experiments it was found that the combination between Methylcellulose gum and gellan gum not only combated the reversibility of the methylcellulose gum as it began to cool but worked with it to add a springy egg like quality.
- the texture of the vegan egg/egg replacementplays one of the most important roles in creating the egg like texture. This texture is in large due to the combination of gums used. Methylcellulose gum is derived from cellulose and is therefore a renewable resource and has a long standing reputation of being safe to use. Gellan gum works synergistically with methylcellulose gum to prevent the melting of the gel when it begins to cool.
- Konjac gelis derived from the konjac root and forms one of the strongest gels from a naturally derived plant. And work towards reducing the percent inclusion of the gels added to the egg without compromising texture.
- the formulation of Table 6utilizes a blend of pea protein isolate (>75% protein), protein rich Euglena flour, in combination with methycellulose and gellan gum that are heat activated at cook temperature.
- the combination of hydrocolliods, i.e. methycellulose and gellan gum, along with optimized ratio of pea protein/ Euglena flourprovides a viscosity of rehydrated vegan egg batter that is comparable to liquid eggs.
- Heat activation of functional hydrocolloids with optimized moisture/lipid ratiofacilitates shortened cook time while delivery vegan egg texture similar to scrambled egg prepared from liquid chicken whole egg.
- Natural Yellow/orange color of Euglenaeliminates the need of any added color.
- This compositionalso uses black salt, onion, yeast extract to help deliver sulfur and umami notes associated with liquid scrambled egg while providing consumer an option to using their oil of choice when rehydrating the dry mixture.
- the ratio of Euglena protein and pea proteinresulted in greater than 6 g/50 g of an equivalent egg serving, this ratio also provided a natural yellow egg color.
- the combination of methylcellulose and gellan gumimproved the texture and reduced the cook time to about 4-5 minutes when used as an egg scramble.
- the final combination of ingredientsresulted in the optimal viscosity upon hydration of the dry egg substitute.
- the use of black salt, onion powder, yeast extractimproved the egg flavor. See FIG. 3 .
- the final compositionis provided in Table 6.
- the preparation of an egg scramble utilizing the describe egg replacementincludes mixing the dry ingredients described in Table 3 with 1 tablespoon of vegetable oil and % a cup of water. Shake well and pour into a preheated frying pan. Cook for 4 minutes, breaking up the mixture with a spatula.
- HEATa drizzle of oil in a small skillet over medium heat. Stir in onion, cook until softened, about 2-3 minutes. Add spinach to skillet and cook for 2-3 minutes, or until spinach has wilted and liquid has evaporated. Stir in garlic and sun-dried tomatoes, cook for 1 minute. Remove mixture to a paper towel lined plate and wipe pan clean.
- WHISK(or prepare in bottle) egg replacer (“The Egg”) with 140 ml of water and 1 tbsp of oil in a medium bowl until smooth. Increase skillet heat to medium-high, and drizzle in 1 tsp of oil.
- POUR egg replacer(“The Egg”) into preheated skillet and cook, without stirring, for 45 seconds. Continue to cook egg replacer (“The Egg”) for 4-5 minutes, using a rubber spatula to push egg around the pan. Add spinach mixture back to pan and cook for 1 minute or until heated through.
- the EggIngredients for Fluffy Oatmeal Cinnamon Pancakes with egg replacer (“The Egg”) Ingredient: Amount: Old fashioned rolled oats 1 cup All-purpose flour, or gluten free baking flour 3 ⁇ 4 cup Baking Powder 1 tbsp Ground Cinnamon 1 tsp Cold milk or non-dairy alternative 1 cup egg replacer (“The Egg”), unprepared 2 scoops/bottle Cider Vinegar 1 tsp Maple syrup, or favorite liquid sweetener 1 tbsp Melted butter, or oil 1 tbsp Vanilla Extract 1 tsp
- COMBINEoats, flour, baking powder and cinnamon in a large bowl and mix well.
- WHISKtogether milk, egg replacer (“The Egg”) and vinegar in a medium bowl, let stand for 5 minutes.
- WHISKwet ingredients into the bowl with the dry ingredients until batter is smooth and lump free.
- Example 7Caramelized Onion and Mushroom Strata
- the EggIngredients for Caramelized Onion and Mushroom Strata with egg replacer (“The Egg”) Ingredient: Amount: l inch, cubed, day old sourdough bread 10 cups Grated old cheddar cheese (optional) 1 cup Spanish onion, finely sliced 1 Sliced, mixed mushrooms (portabella, 4 cups cremini, shitaki) Rosemary, minced 1 tsp Thyme, minced 1 tsp Cloves of garlic, minced 2 Whole Milk (3.25% fat) 11 ⁇ 2 cup Dijon Mustard 2 tsp egg replacer (“The Egg”) (unprepared) 6 scoops/3 bottles
- DRIZZLEa small amount of oil into the pan with the onions and increase the skillet heat to medium-high.
- Stir in mushrooms, rosemary and thyme, season with salt and pepper.Cook for 8 to 10 minutes, stirring occasionally, until golden and tender.
- Example 8Food Chocolate Cake with Berry Filling and Chocolate Ganache
- Example 9Breakfast Burritos with Avocado Pico de Gallo
- HEATa drizzle of oil in a medium skillet over medium heat. Add the bell pepper and onion, cook for 2-3 minutes, or until tender. Stir in spinach and cook until wilted and any extra liquid has evaporated, about 2 minutes. Stir in spice mix and cook for 30 seconds. Wipe skillet clean and increase heat to medium-high.
- the EggWHISK (or prepare in bottles) egg replacer (“The Egg”) with 280 ml of water and 1 tbsp of oil until smooth. Pour into preheated pan and cook without stirring for 45 seconds. Continue to cook for 7 to 8 minutes using a rubber spatula to push egg around the pan. WHILE the egg cooks; in a small bowl mix together all pico de gallo ingredients, season with a little salt and pepper.
- DIVIDEthe cooked egg between 2 tortillas. Top with a sprinkle of shredded cheese and a spoonful of pico de gallo. FOLD up wrap and serve alongside any extra pico de gallo.
- HEATa drizzle of oil in a large skillet over medium heat, add chopped mushrooms and cook for 3-8 minutes or until tender and golden.
- Egg Variationswill include the universal egg replacement, an egg replacement specific for baking which would not contain savory flavours added, the seasoned egg replacement (i.e. Tex mex, Italian, Mediterranean, Cajun, Other unique and trendy seasoning if market research shows a market for it).
- the seasoned egg replacementi.e. Tex mex, Italian, Mediterranean, Cajun, Other unique and trendy seasoning if market research shows a market for it.
- Recipeswill include: Eggless Pasta Dough, Egg Fried Rice with Spiced Chickpeas, Cinnamon Buns with Maple Glaze, Vegetable Pad Thai, Indian Style Pancakes with Spicy Ginger Tomato Jam, Mini Chocolate Doughnuts, Okonomiyaki (Japanese Pancakes), Cardamom Spiced Sugar Cookies, Shakshuka, eggs poached in spiced tomato sauce, Savoury Egg and Cheese Crepes, Vegetable Carbonara, Breakfast Pizza with Pesto, vegetables and Scrambled Egg, Huevos Collinseros, Egg Drop Soup, Breakfast Tostadas, Belgian Waffles with Coconut Whip, Bhurji Egg, Asparagus and Chive Quiche, Sautéed Vegetable and Pesto Gnocchi, Mini Green Onion and Gruyere Souffle, and Mayonnaise.
- Example 12Liquid Egg Formulation Using Fresh Biomass and Pea Protein Isolate
- Euglena gracilishas emerged as an interesting candidate for application-driven research and commercialization, as it is an excellent source of high-quality dietary protein, pro(vitamins), lipids, and the ⁇ -1,3-glucan paramylon. It as well as its natural ability to tolerate a number of external stresses, including acidic growth conditions and ionising radiation, and has been shown to be capable of heavy metal sequestration. Controlled growth of Euglena in different media can be used to achieve high quality proteins, carbohydrates and lipids for value added food application.
- the main objective of this studywas to formulate liquid egg using Euglena fresh biomass grown in different media (protein rich or carbohydrate rich media) with different protein, carbohydrate and lipid content with more than 6 g protein per serving and less than 4.5 minute cooking time.
- Fresh biomass grown in protein rich and carbohydrate rich mediawere used for the egg formulation.
- the harvested biomassunderwent a kill step to deactivate further growth of Euglena and a wash step prior to use of egg production.
- the pourability of the mixturewas good and the cooking time was only 2.5 to 3.5 minute.
- the mixturedid not form a proper curd/gelation like the real egg while cooking although after cooking it looked almost like the real egg (as can be seen in FIG. 4 ).
- the protein content per servingdid not meet the required amount, it was only 3.5 grams per serving and the serving size was too large.
- the liquid egghad a less than 2.5 minute cooking time, good texture and about 7.2 g protein per serving. After cooking the amount of cooked product was able to give about 50 g cooked product (see FIG. 5 ).
- transglutaminasemay cause allergy and there may be regulatory issues associated with its use, so an alternative formulation without transglutaminase was finalized.
- Formula 1Formula 2 Amount Amount Amount Amount Amount Amount Amount Ingredient (g) (%) (g) (%) Biomass 250 54.93 250 62.20 Pea protein 25 5.49 25 6.22 Sunflower oil 20 4.39 20 4.98 Water 150 32.96 97 24.14 Gellan gum 2 0.44 2 0.50 Methyl Cellulose 3 0.66 3.1 0.77 Black salt 0.8 0.18 0.8 0.20 Yeast extract 1.5 0.33 1.5 0.37 onion powder 0.5 0.11 0.5 0.12 Baking powder 1 0.22 1 0.25 Sunflower 1.3 0.29 0 0 lecithin Transglutaminase 0 0 1 0.25 Total 455.1 100 401.9 100
- the eggswere formulated using formula 1 and 2 shown in Table 16 were able to form a good texture with 7.5 g protein per serving.
- the cooking timewas less than 2 minutes with a cooked product of about 53 g.
- biomasseswere grown in different media, the amount of protein ( ⁇ 35%) and carbohydrates ( ⁇ 40%) presented in the biomasses were not significantly different. Not much difference between the texture of the egg made using protein rich media and carbohydrate rich media grown biomasses. Biomass from the protein rich media was more viscous and gave slightly higher fluffy texture for the egg.
- Carbohydrate rich grown biomasshas better flavour than protein rich one, even without any maskers added, provided better flavour for the product, but it has less yellow color.
- the good flavourmight be due to the difference in washing step used for the carbohydrate rich media grown biomass, which was washed with 2.5 times water compared to the protein rich biomass which was just diluted with water and centrifuged.
- a liquid egg with less than 2 minutes cooking time and 7.5 g protein per serving with a serving content of 53 gcan be prepared using fresh biomass grown either using protein rich media or carbohydrate rich media in combination with pea protein.
- Flavour of the eggcan be improved by addition of yeast extract, black salt and onion powder.
- the texture of the eggwas achieved by using the right combination of methyl cellulose and gellan gum and pea protein and biomass. This egg is similar to a standard chicken egg which when cooked is 50-55 g, 6-6.5 g of protein per serving for less than a minute cook time.
- Fresh biomass with 10 w/w % solid content only consisting of 35% protein, which will only provide a maximum of 3.5 g proteinis used 100 g biomass in one serving of egg. If the protein content in the biomass can be enhanced, a higher amount of protein from Euglena can be achieved in the egg formulation.
- the beta glucan isolate (BGI)the carbohydrate present in the Euglena biomass, was removed from the biomass and the protein was concentrated using isoelectric precipitation method.
- the first formulation of liquid egg using wet protein concentratewas prepared using a protein concentrate with 4-5 w/w % solid content.
- the formulais shown in Table 17.
- the cooking time for this formulawas about 4 min, but it did not form a texture similar to the liquid egg prepared using fresh biomass and pea protein. There were no curd or gel formations occurred and obtained a product shown in FIG. 7 .
- the cooked productwas only 46 g with 5.6 g protein per serving. Although the amount of gellan gum and methyl cellulose shown in the formula was increased to 0.5% and 0.7%, respectively, no betterment in the egg texture was obtained. The issue was having not enough functional protein in the formulation. This can be achieved by increasing the wet protein concentrate in the formulation, but it will also increase the cooking time and increase in hydrocolloid addition might be also required. Therefore, it was necessary to increase the solid content of the initial wet protein concentrate to increase the protein content in the formula without increasing any cooking time or having to use a higher amount of hydrocolloid.
- Liquid egg with 6.25 g protein per serving with a serving size of 49 g (cooked product)was developed using wet protein concentrate with ⁇ 15 w/w % solid content as can be seen in FIG. 8 .
- Texture of this eggwas not as good as the liquid egg formulated using fresh biomass and pea protein, but very close to that.
- Flavour of the eggwas close to the liquid egg prepared using fresh biomass and pea protein, however the fresh biomass liquid egg was better
- a liquid egg with more than 6 g protein per serving and less than 2 minutes cooking time with a serving size of ⁇ 50 gwas formulated using wet protein concentrate in which Euglena protein is the only protein source. Texture of the egg formulated using only wet Euglena protein concentrate was very similar to the liquid egg formulated using fresh biomass and pea protein.
- Some of these maskers that could cover the off notesare commercially available from: Firmenich, IFF, Givaudan, Symrise, Mane, Fona, Flavor producer, McCormick, edlong, T ⁇ Hasegawa. Sensient Flavors, Robertet SA, Prova, Wild/ADM, Takasago, Synergy, and others.
- the biomass and the wet protein concentrateconsists of a significant amount of water, it facilitates the growth of microorganisms such as bacteria, yeast and mold, which leads to the spoilage of biomass/wet protein concentrate. It can also lead to spoilage of the liquid egg formulated using these materials during the storage. Therefore, it is essential to understand if there is any growth of microbes and the spoilage time and adopt any prevention method to protect the biomass/wet protein concentrate from spoilage.
- microbessuch as bacteria, yeast and mold were detected in fresh biomass and they continued their growth during storage.
- the wet protein concentrate with 17.6% solidwas diluted with 4 times water.
- the pHwas then adjusted to pH 4.5 and a sample was poured into a TSA plate.
- the platewas then stored at 30° C. to facilitate the growth of microbes if there is any.
- a negative controlwas also used as described above.
- the image of the TSA plate after two days of storage at 30° C.is shown in FIG. 10 .
- a small sample from the growthwas viewed under the microscope, presence of various kinds of bacteria as well as the presence of fungus were observed.
- Pasteurizationis a method in which the required product will be heated to a specific selected temperature for required time to kill the microorganisms presented in the food systems. Then the food material will be packed safely to prevent the entrance of any microbes and thus protect the food systems from spoilage.
- Microbial AnalysisA small portion of plate with microbial growth was dispersed in water and observed under a light microscope. The remaining portion is sent for a detailed identification test. The analysis showed the presence of Lysinbacillus and two fungal genera, aspergillus and Fusarium.
- Presence of microbeswere found at all storage conditions irrespective of the presence of nisin or storage time. Presence of bacteria and yeast were detected on the TSB plates (microscopic analysis) as can be seen in FIGS. 13 - 17 . Increased amount of growth was not correlated with presence of nisin or storage time (might be due to the inconsistency in the amount of sample used for plating).
- Pasteurization at lower temperature or treatment with 75 ppm of Nisinwill not be able to prevent the growth of microorganisms in the fresh biomass or wet protein concentrate. Therefore, alternative methods need to be obtained to prevent the spoilage of biomass, wet protein concentrate as well as liquid egg during storage.
- a biomass stored in the refrigerator at harvested pH (pH 2.75) for 2 days after harvestwas chosen for microbial analysis.
- Four different pH conditionswere used for non-heat treated biomass storage, pH 3, 4.5, 5 and 7.
- Three different antimicrobialswere added to biomass at each pH selected. Control without any antimicrobial agents were also stored at different selected pHs. All the biomass samples were stored in a 4° C. refrigerator for 5 days and a TSA plate assay was done to see the presence of any microbes at the 5 day mark.
- the same biomass used in the previous stepwas taken in a glass beaker and heated in a water bath at 95° C. The temperature of the biomass was reached at 75° C. and stayed constant. The biomass was then left at this temperature for 30 minutes and stirred using a sterilized spatula every 5 minutes. The biomass was then immediately cooled using an ice bath left in a biosafety cabinet to room temperature. The pH of this biomass was then adjusted to pH 3, 4.5 and 5 and added a mixture of Sodium benzoate and Bio Vontage 2662 (cultured dextrose) was added at each pH condition. A heat treated biomass without any antimicrobial agents was also stored at each pH as a control. The biomass was stored in a 4° C. refrigerator and TSA plate analysis was conducted to see any microbial growth.
- FIG. 18Images of TSA plates of heat treated and non-heat treated biomass on the first day of microbial analysis study is shown in FIG. 18 . As seen, there was no microbial growth in heat treated biomass but there was evidence of Fungal growth in non-heated biomass. The growth found in non-heated biomass was observed under microscope and it was found that the growing microbe was yeast (see FIG. 19 )
- FIG. 20Images of plates of non-heat treated biomass control and with antimicrobial agents is seen in FIG. 20 . Images of plates from heat treated (75° C. for 30 minutes) with and without antimicrobial agents is seen in FIG. 21 .
- the microbial growth in the biomasswas determined by the pH of the biomass, presence of antimicrobial agents and heat treatment.
- microbeswere present at pH 7.
- the microscopic analysisshowed that the microbes present at pH 7 were yeast and mold.
- SB+PShelped to prevent any microbial growth.
- these antimicrobial agentskilled all the microbes present in the biomass and none of the other antimicrobial agents tested were as effective.
- the heat treated biomassno microbial growth was observed in any pH even without any antimicrobials, except, there was microbial growth at pH 4.5 when Bio Vontage was present.
- Controlhas no antimicrobial agents pH Control SB + PS BV 3 no microbes no microbes no microbes 4.5 no microbes no microbes Fungus 5 no microbes no microbes no microbes no microbes
- the liquid eggwas prepared using protein concentrate powder using the formula shown in Table 23.
- the eggwas prepared in a sterilized container using sterilized equipment. The egg was then poured into sterilized 50 ml centrifuge tubes and stored in the refrigerator. A mixture of Cultured Dextrose Bio Vontage 2662 (BV, 0.25 w/w %) and 500 ppm of Nisin was added to the egg and also stored at the same condition. The antimicrobials were mixed with egg for 30 minutes, and the pH of the egg before and after addition of the antimicrobial mixture was taken. A TSA plate assay was done on the same day right after the egg was prepared and another plate after 3 days of storage. TSA plates were incubated at 30° C. for 3 days before analysis.
- the pH of the liquid egg prepared using protein concentrate powderwas 6.75, pH of the egg did not change much with the addition of antimicrobial agents although it was expected to have a shift of pH to lower pH side due to the addition of BV (cultured dextrose).
- FIG. 23The images of TSA plates of liquid egg done on the day of preparation and after 3 days of storage are shown in FIG. 23 (A-C) as well as microscopic images (D-F).
- the microbial growthwas observed in all the plates.
- the microscopic analysisshowed there were both circular and rod-like bacteria present in the egg, and within three days the egg's smell changed negatively.
- the number of rod shaped bacteriadid decrease compared to the control.
- the viscosity of the eggincreased almost to not flowing easily out of the tube with the changes to the recipe. Further optimization is needed in order to improve viscosity if this treatment is to be used.
- a combination of potassium sorbate and sodium benzoatecould kill microbes and keep it out of any microbial growth if the pH of the biomass is below pH 5 and above pH 3. Since the pH of protein concentrate is at pH 7, the microbial growth cannot be prevented without further measures to changing its pH. If the pH of the liquid egg is pH 4.5, it should be able to prevent any microbial growth.
- the pourability, viscosity, consistency of the liquid egg formulationwill be checked at different times during storage at the refrigerator. Also cooking will be done different days during storage to see how it performs.
Landscapes
- Life Sciences & Earth Sciences (AREA)
- Chemical & Material Sciences (AREA)
- Engineering & Computer Science (AREA)
- Food Science & Technology (AREA)
- Polymers & Plastics (AREA)
- Health & Medical Sciences (AREA)
- Nutrition Science (AREA)
- Biochemistry (AREA)
- Mycology (AREA)
- Microbiology (AREA)
- Biotechnology (AREA)
- Proteomics, Peptides & Aminoacids (AREA)
- Cell Biology (AREA)
- Genetics & Genomics (AREA)
- Organic Chemistry (AREA)
- Zoology (AREA)
- Wood Science & Technology (AREA)
- Bioinformatics & Cheminformatics (AREA)
- Virology (AREA)
- Biomedical Technology (AREA)
- Botany (AREA)
- Tropical Medicine & Parasitology (AREA)
- General Engineering & Computer Science (AREA)
- General Health & Medical Sciences (AREA)
- Medicinal Chemistry (AREA)
- Meat, Egg Or Seafood Products (AREA)
- Coloring Foods And Improving Nutritive Qualities (AREA)
Abstract
Description
This application is a U.S. National Stage filing under 35 U.S.C. § 371 of International PCT Application No. PCT/IB2020/061714, filed Dec. 9, 2020, which claims the benefit of U.S. Provisional Application No. 62/945,599 entitled “Egg Replacement ContainingEuglena-Derived Components,” filed Dec. 9, 2019, each of which is hereby incorporated by reference in its entirety.
Embodiments described herein are directed to a dry egg replacement composition comprising about 10% to about 98%Euglena-derived material, about 10% to about 85% pea protein, and one or more additional ingredient, wherein the dry egg replacement composition comprises one or more functional property of a natural egg.
Embodiments described herein are directed to an egg replacement emulsion comprising a dry egg replacement composition, an oil, and water.
Embodiments described herein are directed to a liquid egg comprising a dry egg replacement composition, an oil, and water.
Embodiments described herein are directed to methods of preparing an egg scramble comprising combining a dry egg replacement mix, an oil, and water.
Embodiments described herein are directed to a liquid egg formulation comprising about 50% to about 85% freshEuglena-derived material, about 5% to about 10% pea protein, and one or more additional ingredient, wherein the liquid egg formulation comprises one or more functional property of a natural egg.
Embodiments described herein are directed to a liquid egg formulation comprising about 12% to about 95%Euglena-derived wet protein concentrate, about 1% to about 20% solid content, and one or more additional ingredient, wherein the liquid egg formulation comprises one or more functional property of a natural egg.
Embodiments described herein are directed to various food applications wherein the dry egg replacement composition, the egg replacement emulsion, liquid egg, or liquid egg formulation has been incorporated into edible egg-free scrambled eggs, egg-free patty, egg-free frittata, egg-free chocolate cake, egg-free pound cake, egg-free angel food cake, egg-free yellow cake, egg- and dairy-free cream cheese, egg-free pasta dough, egg-free custard, egg-free ice cream, and dairy-free milk.
As a civilization we face significant challenges in the years ahead. The population growth predicted over the next few decades, about 9.7 billion global population by 2050, will cause severe food shortages. Malnutrition is a leading cause of death, accounting for about 3.5 million deaths per year. Global deforestation will cause the loss of a significant portion of the food we rely on currently, i.e. palm oil. The resources we utilize currently are unsustainable, two planets worth of resources will be needed to support the expected population by 2050. Accordingly, there is a significant need to identify sustainable alternatives. For example, food sources that can provide improved functionality, higher nutritional value, minimal waste stream, reduced water usages and reduced carbon dioxide emissions.
Microalgae are a rich source of protein, essential fatty acids, vitamins, and minerals. After lipid removal, the residual biomass contains even higher concentrations of protein and other nutrients. Microalgae are good sources of long chain polyunsaturated fatty acids (“PUFA”) and have been used to enrich diets with omega-3 PUFA. Described herein are, inter alia, novel techniques for extracting a variety of components from heterotrophically cultivated microalgae, e.g.,Euglena, without the use of harsh chemicals or solvents.
A specific species of algae namedEuglena gracilis(hereinafterEuglena) belongs to a group of single-celled microscopic algae, that is often used as a candidate species for laboratory studies and technological applications.Euglenapossess the representative features typical of eukaryotic cells such as a mitochondria, nucleus, and lysosome.Euglenacan further be characterized for its long flagellum and large red eyespot. They are distinctive as they can produce their own nourishment (autotrophic) similar to plants, as well as eat and digest external food sources (heterotrophic) like animals.Euglenais a demonstrated, multifaceted model organism for study. Through optimizing the natural ability to employ singly or both modes of nourishment,Euglenacan be directed to produce target compounds by adjusting key parameters in the production process. These critical adjustments can be used to enhance the natural mechanisms of the microorganism, to encourage rapid growth and the efficient conversion of valuable products with little waste production.
Eggs are a staple ingredient, found in most homes worldwide. As the population continues to lean towards a healthier and more sustainable lifestyle, this has led to a need in the marketplace for a sustainable, healthy egg alternative. The egg is a versatile affordable complete nutritive solution. Currently available vegan and plant based egg substitutes lack full nutritional benefits as well as essential amino acids, creating an incomplete protein product. Further, the commercially available egg substitute solutions lack the texture, flavor, and color of the commonly used chicken egg. Manufacturers of these products must add artificial colors or additional ingredients to mimic the natural yellow color of a chicken egg yolk. There has been widespread interest in a suitable replacement for the egg for quite some time, due to spoilage, concern for animal welfare, environmental damage from the industrial poultry, andsalmonellarisks in natural eggs.
The egg replacement described herein includes many advantages over previous egg replacement: 1) no risk of any avian-related disease contaminating the product, 2) can be used as scrambled egg analog providing a complete nutritive egg replacement, 3) can be used to replace eggs in the manufacture of various types of foods, such as bakery products, condiments, noodles, etc., and 4) can be used to replace eggs in the manufacture of specialty items such as shampoo, pet foods and adhesive products.
The egg replacement described herein is suitable for various food applications for example, edible egg-free emulsion, egg analog, egg-free scrambled eggs, egg-free patty, egg-free bakery items, egg-free cream cheese, egg-free pasta dough, egg-free custard, and egg-free ice cream.
For convenience, certain terms employed in the specification, examples and claims are collected here. Unless defined otherwise, all technical and scientific terms used in this disclosure have the same meanings as commonly understood by one of ordinary skill in the art to which this disclosure belongs.
Where a range of values is provided, it is intended that each intervening value between the upper and lower limit of that range and any other stated or intervening value in that stated range is encompassed within the disclosure. For example, if a range of 1 g to 8 g is stated, it is intended that 2 g, 3 g, 4 g, 5 g, 6 g, and 7 g are also explicitly disclosed, as well as the range of values greater than or equal to 1 g and the range of values less than or equal to 8 g.
The singular forms “a,” “an,” and “the” include plural referents unless the context clearly dictates otherwise. Thus, for example, reference to an “egg” includes a single egg as well as two or more of the same or different types of eggs.
The word “about” when immediately preceding a numerical value means a range of plus or minus 5% of that value, e.g, “about 50” means 45 to 55, “about 25,000” means 22,500 to 27,500, etc., unless the context of the disclosure indicates otherwise, or is inconsistent with such an interpretation. Furthermore, the phrases “less than about” a value or “greater than about” a value should be understood in view of the definition of the term “about” provided herein.
“Baked good” means a food item, typically found in a bakery, that is prepared by using an oven and usually contain a leavening agent. Baked goods include, but are not limited to breads, brownies, cookies, pies, cakes and pastries.
“Bread” means a food item that contains flour, liquid, and usually a leavening agent. Breads are usually prepared by baking in an oven, although other methods of cooking are also acceptable. The leavening agent can be chemical or organic/biological in nature. Typically, the organic leavening agent is yeast. In the case where the leavening agent is chemical in nature (such as baking powder and/or baking soda), these food products are referred to as “quick breads.” Crackers and other cracker-like products are examples of breads that do not contain a leavening agent.
The transitional term “comprising,” which is synonymous with “including,” “containing,” or “characterized by,” is inclusive or open-ended and does not exclude additional, un-recited elements or method steps. By contrast, the transitional phrase “consisting of” excludes any element, step, or ingredient not specified in the claim. The transitional phrase “consisting essentially of” limits the scope of a claim to the specified materials or steps “and those that do not materially affect the basic and novel characteristic(s)” of the claimed invention. In embodiments or claims where the term comprising is used as the transition phrase, such embodiments can also be envisioned with replacement of the term “comprising” with the terms “consisting of” or “consisting essentially of.”
“Dispersion” refers to a distribution of particles more or less evenly throughout a medium, including a liquid or gas. One common form of dispersion is an emulsion made up of a mixture of two or more immiscible liquids such as oil and water.
“Dry weight” means weight determined in the relative absence of water. For example, reference to a dry mixture refers to a specified percentage of a particular component(s) by dry weight as a percentage and is calculated based on the weight of the composition before any liquid has been added.
As used herein, the term “eggs” includes but is not limited to chicken eggs, other bird eggs (such as quail eggs, duck eggs, ostrich eggs, turkey eggs, bantam eggs, goose eggs), and fish eggs such as fish roe. Typical food application comparison is made with respect to chicken eggs.
As used in this disclosure, the terms “emulsifying,” “emulsion” or a derivative thereof refers to where a substance is present in a food composition or food product as a single-phase mixture where a two-phase system of oil and water would normally have existed. An emulsion thus refers to a kinetically stable mixture of two normally immiscible liquids, i.e. oil and water. In some other foods, the water is dispersed in oil.
“Edible ingredient” means any substance or composition which is fit to be eaten. “Edible ingredients” include, without limitation, grains, fruits, vegetables, proteins, herbs, spices, carbohydrates, and fats.
As used herein, the term “enriched” refers to an increase in a percent amount of a molecule, for example, a protein, in one sample relative to the percent amount of the molecule in a reference sample. In some embodiments, the enrichment is on a weight to weight basis. In some embodiments, the enrichment refers to an increase of about 5%, 10%, 15%, 20%, 25%, 30%, 35%, 40%, 45%, or 50% relative to the reference value or amount. In some embodiments, the enrichment refers to an increase of at least about 5%, 10%, 15%, 20%, 25%, 30%, 35%, 40%, 45%, or 50% relative to the reference value or amount.
“Finished food product” and “finished food ingredient” mean a food composition that is ready for packaging, use, or consumption. For example, a “finished food product” may have been cooked or the ingredients comprising the “finished food product” may have been mixed or otherwise integrated with one another. A “finished food ingredient” is typically used in combination with other ingredients to form a food product.
The term “functional food product” as used herein refers to a food product given an additional function by adding new ingredients or more of existing ingredients. For example, where protein is added to a food product to provide texture, water holding capacity or nutritional support to a food product.
“Food,” “food composition,” “food product,” and “foodstuff” mean any composition intended to be or expected to be ingested by humans or other animals as a source of nutrition and/or calories. Food compositions are composed primarily of carbohydrates, fats, water and/or proteins and make up substantially all of an individual's daily caloric intake.
The term “gelling,” “gelification” or a derivative thereof as used herein refers to a food composition or a food product in a gelatinous form. A gelatinous form is created by incorporating solids and liquids into a uniform three dimensional, semi-solid structure. A gelatinous food product is considered a soft gel when its tensile strength is in the range of 500-1000 g/cm2, as seen in, for example, jelly and jams, nut butters (e.g. just nuts versions), jelly-like products, and fondant. A gelatinous food product is considered a hard gel when its tensile strength is in the range of 1000-3000 g/cm2, as seen in, for example, gummy candy, confectionary gels (i.e. cookie filling), fruit gel bars, and fruit snacks.
“Foamability” as used herein, refers to the ability of a material to rapidly adsorb on the air-liquid interface during whipping or bubbling, and to form a cohesive viscoelastic film by way of intermolecular interactions.
The term “fresh biomass” or “freshEuglenabiomass” as used herein refers to biomass orEuglenabiomass that is not frozen or dried after harvesting and is kept at 4° C. until use.
“Good manufacturing practice” and “GMP” mean those conditions established by regulations set forth at 21 C.F.R. 110 (for human food) and 111 (for dietary supplements), or comparable regulatory schemes established in locales outside the United States. The U.S. regulations are promulgated by the U.S. Food and Drug Administration under the authority of the Federal Food, Drug, and Cosmetic Act to regulate manufacturers, processors, and packagers of food products and dietary supplements for human consumption. All of the processes described herein can be performed in accordance with GMP or equivalent regulations. In the United States, GMP regulations for manufacturing, packing, or holding human food are codified at 21 C.F.R. 110. These provisions, as well as ancillary provisions referenced therein, are hereby incorporated by reference in their entirety for all purposes. GMP conditions in the Unites States, and equivalent conditions in other jurisdictions, apply in determining whether a food is adulterated (the food has been manufactured under such conditions that it is unfit for food) or has been prepared, packed, or held under unsanitary conditions such that it may have become contaminated or otherwise may have been rendered injurious to health. GMP conditions can include adhering to regulations governing: disease control; cleanliness and training of personnel; maintenance and sanitary operation of buildings and facilities; provision of adequate sanitary facilities and accommodations; design, construction, maintenance, and cleanliness of equipment and utensils; provision of appropriate quality control procedures to ensure all reasonable precautions are taken in receiving, inspecting, transporting, segregating, preparing, manufacturing, packaging, and storing food products according to adequate sanitation principles to prevent contamination from any source; and storage and transportation of finished food under conditions that will protect food against physical, chemical, or undesirable microbial contamination, as well as against deterioration of the food and the container.
“Increased lipid yield” means an increase in the lipid/oil productivity of a microalgal culture that can achieved by, for example, increasing the dry weight of cells per liter of culture, increasing the percentage of cells that contain lipid, and/or increasing the overall amount of lipid per liter of culture volume per unit time.
The term “shaking” as used herein refers to the movement of a sample, in an up and down or side to side, rapid, forceful or jerky movement. This may be done manually, or mechanically.
The term “solution” as used herein refers to a homogeneous mixture of a substance (solute) dispersed through a liquid medium (solvent) that cannot be separated by the forces of gravity alone.
The term “solid content” as used herein refers to how much mass (i.e. biomass or protein concentrate) is in a liquid by weight of each.
The term “substantially free” as used herein refers to the complete or near complete lack of light or a component. For example, a composition that is “substantially free” of water would either completely lack water, or so nearly completely lack water that the effect would be the same as if it completely lacked water.
As used herein, the term “stability” and derivatives thereof refer to heat stability, freeze-thaw stability, light stability, emulsion stability, or storage stability. Heat stability is the ability of a product or material to retain the same properties after exposure to a high heat for a single set period of time or a cycling of exposure times. Freeze-thaw stability is the ability of a product or material to retain the same properties after being frozen and subsequently thawed, which can be cycled through a number of freeze thaw cycles. Light stability is the ability of a product or material to retain the same properties after exposure to a light, such as sunlight or indoor light for a single set period of time or a cycling of exposure times. Emulsion stability is the ability of a product or material to retain an emulsion and to prevent separating, over time. Further, the term “stabilizer” relates to a material that provides stability described herein when added to a product or another material. For example, a stabilizer may be an ingredient incorporated into a final food formulation which preserves the structure and sensory characteristics of a food product over time, which would not otherwise be maintained in the absence of the stabilizer.
The term “solubility” as used herein, refers to the maximum amount of a substance that is able to be completely dissolved in a solution, usually in a specific amount.
“Uncooked product” means a composition that has not been subjected to heating but may include one or more components previously subjected to heating.
As used herein, the term “viscosity” refers to the resistance of a fluid when attempting to flow, may also be thought of as a measure of fluid friction.
“W/W” or “w/w,” in reference to proportions by weight, means the ratio of the weight of one substance in a composition to the weight of the composition. For example, reference to a composition that comprises 5% w/w microalgal biomass means that 5% of the composition's weight is composed of microalgal biomass (e.g., such a composition having a weight of 100 mg would contain 5 mg of microalgal biomass) and the remainder of the weight of the composition (e.g., 95 mg in the example) is composed of other ingredients.
“W/V” or “w/v” means the ratio of the weight of one substance in a composition to total volume of the composition. For example, reference to a composition that comprises 5% w/v microalgal biomass means that 5 g of microalgal biomass is dissolved in a final volume of 100 mL aqueous solution.
The term “whipping” as used herein, refers to the action of using a whisk, or a mixer to beat a sample in order to rapidly incorporate air and produce expansion.
The term “water holding capacity” or WHC or a derivative thereof as used herein relating to food composition or product refers to the ability to hold the food's own and added water during the application of forces, pressing, centrifugation, or heating. WHC may also be described as a physical property, for example, the ability of a food structure to prevent water from being released from the three-dimensional structure of, for example, a gel.
Throughout this disclosure, theEuglenamay be selected from the group of species selected fromEuglena gracilis, Euglena sanguinea, Euglena deses, Euglena mutabilis, Euglena acus, Euglena virdis, Euglena anabaena, Euglena geniculata, Euglena oxyuris, Euglena proxima, Euglena tripteris, Euglena chlamydophora, Euglena splendens, Euglena texta, Euglena intermedia, Euglena polymorpha, Euglena ehrenbergii, Euglena adhaerens, Euglena clara, Euglena elongata, Euglena elastica, Euglena oblonga, Euglena pisciformis, Euglena cantabrica, Euglena granulata, Euglena obtusa, Euglena limnophila, Euglena hemichromata, Euglena variabilis, Euglena caudata, Euglena minima, Euglena communis, Euglena magnifica, Euglena terricola, Euglena velata, Euglena repulsans, Euglena clavata, Euglena lata, Euglena tuberculata, Euglena contabrica, Euglena ascusformis, Euglena ostendensis, Chlorella autotrophica, Chlorella colonials, Chlorella lewinii, Chlorella minutissima, Chlorella pituita, Chlorella pulchelloides, Chlorella pyrenoidosa, Chlorella rotunda, Chlorella singularis, Chlorella sorokiniana, Chlorella variabilis, Chlorella volutis, Chlorella vulgaris, Schizochytrium aggregatum, Schizochytrium limacinum, Schizochytrium minutum, and combinations thereof. In certain embodiments, the microalgae isEuglena gracilis.
Various aspects now will be described more fully hereinafter. Such aspects may, however, be embodied in many different forms and should not be construed as limited to the embodiments set forth herein; rather, these embodiments are provided so that this disclosure will be thorough and complete, and will fully convey its scope to those skilled in the art.
Dry Egg Replacement Composition
Embodiments described herein are directed to a dry egg replacement composition comprising about 10% to about 98%Euglena-derived material, about 10% to about 85% pea protein, and one or more additional ingredient, wherein the dry egg replacement composition comprises one or more functional property of a natural egg.
In embodiments described herein, the one or more additional ingredient is selected from the group consisting of gellan gum, methylcellulose, yeast extract, flavoring, antioxidant blend, and combinations thereof. In some embodiments, the flavoring is selected from the group consisting of black salt, sea salt, onion powder, and combinations thereof.
Embodiments described herein are directed to a dry egg replacement composition comprising about 1% to about 100%Euglena-derived material, about 0.05% to about 70% additional protein source, and one or more additional ingredient, wherein the dry egg replacement composition comprises one or more functional property of a natural egg.
In some embodiments of the dry egg replacement composition described herein, the additional protein source is selected from the group consisting of pea protein, soy protein, corn protein, wheat protein, rice protein, beans protein, seed protein, nut protein, almond protein, peanut protein, seitan protein, lentil protein, chickpea protein, flaxseed protein, wild rice protein, quorn protein, chia seed protein,quinoaprotein, oat protein, fava bean protein, buckwheat protein, bulgar protein, millet protein, microalgae protein, yellow pea protein, mung bean protein, hemp protein, sunflower protein, canola protein, lupin protein, legumes protein, potato protein, and combinations thereof.
In some embodiments of the dry egg replacement composition herein, the additional protein source is in an amount of about 0.05% to about 70%, about 0.5% to about 70%, about 1% to about 70%, about 5% to about 70%, about 10% to about 70%, about 15% to about 70%, about 0.05% to about 60%, about 0.05% to about 50%, about 0.05% to about 40%, about 0.05% to about 30%, or about 0.05% to about 20%. In certain embodiments of the dry egg replacement composition described herein, the additional protein source is in an amount of about 0.05% to about 15%. In certain embodiments of the dry egg replacement composition described herein, the additional protein source is in an amount of about 20% to about 60%.
In some embodiments of the dry egg replacement composition described herein, the one or more additional ingredient is selected from the group consisting of gellan gum, methylcellulose, yeast extract, flavoring, antioxidant blend, maskers, leavening agents, baking powder, baking soda, enzymes, transglutaminase, emulsifiers, lecithin, mono- and diglycerides, binders, carrot fiber, defatted linseed flour, and combinations thereof.
In some embodiments of the dry egg replacement composition described herein, each of the one or more additional ingredient is in an amount of about 0.05% to about 5%, about 0.05% to about 4%, or about 0.05% to about 3%, or about 0.05% to about 2%. In certain embodiments of the dry egg replacement composition described herein, each of the one or more additional ingredient is in an amount of about 0.1% to about 1%.
In some embodiments, the flavoring is selected from the group consisting of black salt, black pepper, Himalayan sea salt, salt, onion powder, minced onion, roasted garlic, mushroom powder, yeast extract, and combinations thereof.
In embodiments described herein, theEuglena-derived material is selected from the group consisting of aEuglenabiomass, aEuglena-derived protein, a protein-rich flour derived fromEuglena, a protein concentrate derived fromEuglena, a protein isolate derived fromEuglena, aEuglena-derived beta-glucan isolate, aEuglena-derived oil, and combinations thereof.
In some embodiments of the dry egg replacement composition described herein, the dry egg replacement composition further comprises one or more hydrocolloids. In some embodiments the one or more hydrocolloids may be selected from the group consisting of locust bean gum, a guar gum, a konjac gum, a gellan gum, a high methoxy pectin, a low methoxy pectin, an Agar, a kappa carrageenan, an iota carrageenan, a lambda carrageenan, an alginate, a curdlan, a methyl cellulose, a carboxymethyl cellulose (CMC), a xanthan gum, a gum Arabic, aEuglenaderived beta-glucan and combinations thereof.
In some embodiments of the dry egg replacement composition herein, each of the one or more hydrocolloids is in an amount of about 0.05% to about 8%, about 0.1% to about 8%, about 0.05% to about 7%, about 0.05% to about 6%, about 0.05% to about 5%, about 0.05% to about 4%, or about 0.05% to about 3%. In certain embodiments of the dry egg replacement composition described herein, each of the one or more hydrocolloids is in an amount of about 0.1% to about 2%.
Complete Nutrition
The dry egg replacement described herein has a similar nutritional content as a natural egg, which previous attempts to create an egg substitute have failed to attain.
To be equivalent to a natural egg, egg replacement composition must have a protein content of 6 g per serving. Previous attempts and commercially available egg substitutes are only able to achieve 5 g per serving. The dry egg replacement composition described herein contains the same amount of protein as a chicken egg. In embodiments described herein, the dry egg replacement composition contains at least 6 g of complete protein per serving size. In certain embodiments, the dry egg replacement composition contains about 6 g to about 10 g, about 6 g to about 9 g, about 6 g to about 8 g, about 6 g to about 7 g, or about 6 g to about 6.5 g of complete protein per serving size. In embodiments described herein, the serving size of the dry egg replacement composition is about 9 g to about 15 g, about 10 g to about 14 g, about 11 g to about 13 g, or about 12 g to about 12.5 g. In embodiments described herein, the serving size of the dry egg replacement composition is about 12.5 g. In certain embodiments, the dry egg replacement composition is mixed with an oil and water to create an emulsion wherein the liquid serving size is from about 50 g to about 100 g, about 60 g to about 90 g, about 70 g to about 80 g, or about 80 g to about 90 g. In certain embodiments, the dry egg replacement composition is mixed with an oil and water to create an emulsion wherein the liquid serving size is about 80 g to about 90 g.
The combination ofEuglena-derived material and pea protein established the nutritional profile similar to a natural egg, including at least 6 g of protein, about 5 g of fat, about 180 mg cholesterol, about 60 mg of sodium, about 60 mg potassium, about 0.6 g carbohydrates, and vitamins and minerals, including vitamin A, vitamin D, vitamin B-6, calcium, cobalamin, iron and magnesium. In certain embodiments, the egg replacement provides about 75 calories.
In certain embodiments, the dry egg replacement composition has a ratio ofEuglena-derived material to pea protein of about 20:80 to about 50:50. In certain embodiments, the dry egg replacement composition has a ratio ofEuglena-derived material to pea protein of about 25:75 to about 50:50. In certain embodiments, the dry egg replacement composition has a ratio ofEuglena-derived material to pea protein of about 40:60.
In certain embodiments, theEuglena-derived material is in an amount of about 10% to about 98%, about 10% to about 95%, about 10% to about 85%, about 15% to about 75%, about 20% to about 65%, or about 25% to about 55% in the dry mixture. In certain embodiments, theEuglena-derived material is in an amount of about 5% to about 90% in the dry mixture. In certain embodiments, theEuglena-derived material is in an amount of about 40% to about 87% in the dry mixture. In certain embodiments, theEuglena-derived material is in an amount of about 40% to about 90% in the dry mixture. In certain embodiments, theEuglena-derived material is in an amount of about 35% in the dry mixture. In certain embodiments, theEuglena-derived material is in an amount of about 7% in the dry mixture. In certain embodiments, theEuglena-derived material is in an amount of about 35 g to about 70 g, about 40 g to about 65 g, about 45 g to about 60 g, or about 50 g to about 55 g in the dry mixture. In certain embodiments, theEuglena-derived material is in an amount of about 56 g in the dry mixture.
In certain embodiments, the pea protein is in an amount of about 5% to about 10%, about 5% to about 20%, about 10% to about 85%, about 15% to about 75%, about 20% to about 65%, or about 25% to about 55% in the dry mixture. In certain embodiments, the pea protein is in an amount of about 52% in the dry mixture. In certain embodiments, the pea protein is in an amount of about 55 g to about 95 g, about 60 g to about 90 g, about 55 g to about 85 g, or about 60 g to about 80 g in the dry mixture. In certain embodiments, the pea protein is in an amount of about 84 g in the dry mixture.
In certain embodiments, the total amount of protein blend in the dry egg replacement composition is about 60% to about 90% of the dry mixture. In certain embodiments, the protein blend includes the combination ofEuglena-derived material and pea protein. In certain embodiments, the total amount of protein blend in the dry egg replacement composition is about 60%, about 65%, about 70%, about 75%, about 80%, about 85%, or about 90% of the dry mixture. In certain embodiments, the total amount of protein blend in the dry egg replacement composition is about 87% of the dry mixture.
In certain embodiments, the yeast extract is in an amount of about 0.2 g to about 5 g, about 0.5 g to about 4 g, about 1 g to about 3 g, or about 1.5 g to about 2 g in the dry mixture. In certain embodiments, the yeast extract is in an amount of about 1.4 g in the dry mixture. In certain embodiments, the amount of yeast extract in the dry egg replacement composition is from about 0.1% to about 5%, about 0.5% to about 4.5%, about 1% to about 4%, about 1.5% to about 3.5%, or about 2% to about 3% of the dry mixture. In certain embodiments, the amount of yeast extract in the dry egg replacement composition is about 0.1%, about 0.5%, about 1%, about 1.5%, about 2%, about 2.5%, about 3% about 3.5%, about 4%, about 4.5%, or about 5%, of the dry mixture. In certain embodiments, the amount of yeast extract in the dry egg replacement composition is about 1% of the dry composition. The yeast extract contributes to the overall nutritional content of the dry egg replacement composition necessary to match a natural egg. The yeast extract also provides an umami flavor to the final product.
In certain embodiments, the dry egg replacement composition is rich in beta-1,3-glucan. Beta-1,3-glucan provides health benefits including, but not limited to, immunity, antidiabetic properties, antihypoglycemic properties, and hepatoprotective properties.
In certain embodiments, the dry egg replacement composition contains essential nutrients. In certain embodiments, the essential nutrients are selected from the group consisting of amino acids, fatty acids, vitamins, minerals, and combinations thereof. In certain embodiments, the amino acids are selected from the group consisting of phenylalanine, valine, threonine, tryptophan, methionine, leucine, isoleucine, lysine, histidine, and combinations thereof. In certain embodiments, the fatty acids are selected from the group consisting of omega-3 fatty acids, omega-6 fatty acids, omega-9 fatty acids, or combinations thereof. In certain embodiments, the vitamins are selected from the group consisting of vitamin E, tocopherol, tocotrienols, vitamin A, vitamin C, vitamin D, vitamin K, thiamine (vitamin B1), riboflavin (vitamin B2), niacin (vitamin B3), pantothenic acid (vitamin B5), pyridoxine (vitamin B6), biotin (vitamin B7), folate (vitamin B9), cyanocobalamin (vitamin B12), vitamin D, and combinations thereof. In certain embodiments, the minerals are selected from the group consisting of potassium, chloride, sodium, calcium, phosphorus, sulfur, fluoride, magnesium, iron, zinc, manganese, copper, iodine, chromium, molybdenum, selenium, cobalt, and combinations thereof. In certain embodiments, the dry egg replacement composition contains vitamin A, riboflavin, pantothenic acid, vitamin B12, choline, phosphorus, zinc, and vitamin D.
In certain embodiments, the dry egg replacement composition contains medium-chain triglycerides (MCT), i.e. triglycerides with two or three fatty acids having an aliphatic tail of 6-12 carbon atoms. In certain embodiments, the MCTs are selected from the group consisting of caproic acid, caprylic, acid, capric acid, lauric acid, and combinations thereof
Functional Properties
The dry egg replacement composition described herein has been developed to provide the same functional benefits as a natural egg. The functional properties are measured and evaluated using the dry egg replacement composition, the egg replacement emulsion, liquid egg, or liquid egg formulation described herein.
In embodiments described herein, the dry egg replacement composition has one or more functional property of a natural egg. In some embodiments, the dry egg replacement composition has at least 2 functional properties of a natural egg. In some embodiments, the one or more functional property of a natural egg is selected from the group consisting of complete nutrition, protein digestibility-corrected amino acid score (PDCAAS), gelation, foaming, viscosity, emulsification, water binding capacity, texture, elasticity, springiness, solubility, flavor, coagulation, aeration, creaminess, film forming property, sheen addition, shine addition, freeze stability, thaw stability, color, and combinations thereof.
In certain embodiments, the gellan gum is in an amount of about 1 g to about 10 g, about 1.5 g to about 9 g, about 2 g to about 8 g, or about 4 g to about 6 g in the dry mixture. In certain embodiments, the gellan gum is in an amount of about 5.6 g in the dry mixture. In certain embodiments, the amount of gellan gum in the dry egg replacement composition is from about 0.5% to about 5%, about 1% to about 4%, or about 2% to about 3% of the dry mixture. In certain embodiments, the amount of gellan gum in the dry egg replacement composition is about 0.5%, about 1%, about 2%, about 3%, about 4%, or about 5% of the dry mixture. In certain embodiments, the amount of gellan gum in the dry egg replacement composition is about 3.5% of the dry mixture. Gellan gum is heat-activated and helps to retain the texture of the final egg product despite cooling after being cooked.
In certain embodiments, the methylcellulose is in an amount of about 1 g to about 12 g, about 2 g to about 10 g, about 3 g to about 9 g, or about 4 g to about 8 g in the dry mixture. In certain embodiments, the methylcellulose is in an amount of about 8.75 g in the dry mixture. In certain embodiments, the amount of methylcellulose in the dry egg replacement composition is from about 1% to about 10%, about 1% to about 9%, about 2% to about 8%, about 2% to about 7%, about 2% to about 6%, about 2% to about 9%, about 3% to about 8%, about 4% to about 7%, or about 5% to about 6% of the dry mixture. In certain embodiments, the amount of methylcellulose in the dry egg replacement composition is about 1%, about 1.5%, about 2%, about 2.5%, about 3%, about 3.5%, about 4%, about 4.5%, about 5%, about 5.5%, or about 6% of the dry mixture. In certain embodiments, the amount of methylcellulose in the dry egg replacement composition is about 5.5% of the dry mixture. Methylcellulose supports the structure of the food product at high temperatures and helps retain the texture and moisture of the food product.
In some embodiments, the protein digestibility-corrected amino acid score (PDCAAS) is a method of evaluating the quality of a protein based on both the amino acid requirements of humans and their ability to digest it. Using the PDCAAS method, the protein quality rankings are determined by comparing the amino acid profile of the specific food protein against a standard amino acid profile with the highest possible score being a 1.0. In some embodiments, the protein digestibility-corrected amino acid score (PDCAAS) of the dry egg replacement composition and/or the egg replacement emulsion and/or liquid egg and/or liquid egg formulation and/or egg replacement formulation described herein is 1.0.
In some embodiments, the functional property of gelation is measured by the temperature at which gelling occurs. In some embodiments, the dry egg replacement composition and/or the egg replacement emulsion and/or liquid egg and/or liquid egg formulation and/or egg replacement formulation described herein has a gelation onset below 90° C. Further, gel strength can be tested using a torsion test. An appropriately sized, and shaped gel is twisted in a rheometer until the gel either breaks, or it is ruptured. The amount of the force that caused the cross-section to rupture is then calculated and can be measured against other sensory results. The strength of a gel is affected by temperature, pH, and the amount of the protein derivative in the food product. The gel strength of the food product comprising protein flour, protein concentrate and/or protein isolate can be measured by a tensiometer. The gel strength can also be measured by a texture analyzer, such as TA.XT Express or TA.XTPlus (Texture Technologies), FTC Texture Analyzer (Food Technology Corporation), and LFRA texture analyzer (Brookfield Engineering), which through compression and tensile data, can measure a number of physical properties, including tensile strength, i.e. a measurement of the force required to pull the gelatinous or “gelled” food product to the point where it breaks. Texture analyzers also test the crunchiness, gumminess, adhesiveness, chewiness, and general texture of many smaller things from crackers to candy. Texture analyzers measure tensile strength (i.e. in lb/in2or psi) and compressive strength (i.e. psi or MPa) of materials. The principle of a texture measurement system is to physically deform a test sample in a controlled manner and measure its response. The characteristics of the force response are as a result of the sample's mechanical properties, which correlate to specific sensory texture attributes. A texture analyzer applies this principle by performing the procedure automatically and indicating the results visually on a digital numerical display, or screen.
In some embodiments, the functional property of foaming is measured by the ability of the composition to retain air in suspension. In some embodiments, the dry egg replacement composition and/or the egg replacement emulsion and/or liquid egg and/or liquid egg formulation and/or egg replacement formulation described herein can be sufficiently foamed. Foaming Capacity can be measured using the following formula:
FC=volume after whipping (mL)−volume before whipping (mL)×100
FC=volume after whipping (mL)−volume before whipping (mL)×100
Volume before whipping (mL)
Foaming Stability can be measured using the following formula:
FS=Foam volume at timet(s)×100
FS=Foam volume at timet(s)×100
Initial foam volume (mL)
In some embodiments, the dry egg replacement composition and/or the egg replacement emulsion described herein can be used as an emulsifier. Emulsification Activity can be measured using the following formula:
EA=Height of the emulsified layer (mm)×100
EA=Height of the emulsified layer (mm)×100
Height of the total contents in the tube (mm)
Emulsion Stability can be measured using the following formula:
ES=Height of emulsified layer after heating (mm)×100
ES=Height of emulsified layer after heating (mm)×100
Height of total contents in the tube (mm)
In some embodiments, the dry egg replacement composition and/or the egg replacement emulsion and/or liquid egg and/or liquid egg formulation and/or egg replacement formulation described herein has water binding capacity. Water binding capacity can be measured using water absorption or water holding capacity. Water Absorption is tested by adding 10 mLs of water to 0.5 g of mixture in a 13-ml graduated plastic test tube. The mixture is sonicated for 30 s at an output setting of 5 to disperse the sample. The mixture is held at 24° C. for 30 min, and then centrifuged at 2000 rpm for 25 min. The volume of free water is measured and the retained water is computed and reported as ml of water (+/−0.1 ml) absorbed per g of mixture. Testing Water Holding Capacity can be measured using the following methods: 1) Centrifuge: rapidly rotating device applies centrifugal force to the components in order to force separation. As such, fluids of different densities become separated, as do liquids from solids. 2) Press Method: the water holding capacity of the composition is calculated based off of the weight of the substance after it has been pressed.
In some embodiments, the dry egg replacement composition and/or the egg replacement emulsion and/or liquid egg and/or liquid egg formulation and/or egg replacement formulation described herein has the texture or consistency of a natural egg. In some embodiments, the dry egg replacement composition and/or the egg replacement emulsion and/or liquid egg and/or liquid egg formulation and/or egg replacement formulation described herein has the viscosity of a natural egg. Consistency is the relative ability of a sample to flow. Viscosity is the measure of how hard it is to force a substance into motion, or flow. The texture or consistency can be measured using a texture or consistency analyzer.
Taste
In some embodiments, the dry egg replacement composition and/or the egg replacement emulsion and/or liquid egg and/or liquid egg formulation and/or egg replacement formulation described herein has the flavor of a natural egg. The development of the dry egg replacement composition has overcome the fishy, algae taste typically found when utilizing algal protein in egg substitutes or other food products. The dry egg replacement composition and/or the egg replacement emulsion and/or liquid egg and/or liquid egg formulation and/or egg replacement formulation described herein has a neutral, slight sulfury taste which corresponds to a natural egg unlike previous versions or commercially available products and/or a reduction of undesirable characteristics typically found with algal compositions, for example fishy smell, unpleasant smell, fishy taste, or unpleasant taste. The taste can be measured using chromatographic analysis and consumer testing.
The dry egg replacement composition and/or the egg replacement emulsion and/or liquid egg and/or liquid egg formulation and/or egg replacement formulation described herein has a unique combination of black salt and onion powder. In certain embodiments, the ratio of black salt to onion powder is about 30:70 to about 50:50.
In certain embodiments, the flavoring is in an amount of about 0.5 g to about 10 g, about 1 g to about 8 g, about 2 g to about 6 g, or about 3 g to about 5 g in the dry mixture. In certain embodiments, the flavoring is in an amount of about 4 g in the dry mixture. In certain embodiments, the amount of flavoring in the dry egg replacement composition is from about 0.05% to about 5%, about 0.1% to about 5%, about 0.5% to about 4.5%, about 1% to about 4%, about 1.5% to about 3.5%, or about 2% to about 3% of the dry mixture. In certain embodiments, the amount of flavoring in the dry egg replacement composition is about 0.05%, about 0.1%, about 0.5%, about 1%, about 1.5%, about 2%, about 2.5%, about 3% about 3.5%, about 4%, about 4.5%, or about 5%, of the dry mixture. In certain embodiments, the amount of flavoring in the dry egg replacement composition is about 4% of the dry mixture. In certain embodiments, the amount of flavoring in the egg replacement composition is about 1% of the dry mixture. In certain embodiments, the amount of flavoring in the dry egg replacement composition is about 0.1% to about 1% of the dry mixture.
In certain embodiments, the flavoring is selected from the group consisting of black salt, black pepper, Himalayan sea salt, salt, onion powder, minced onion, roasted garlic, mushroom powder, yeast extract, and combinations thereof.
In certain embodiments, the black salt is in an amount of about 0.5 g to about 10 g, about 1 g to about 8 g, about 2 g to about 6 g, or about 3 g to about 5 g in the dry mixture. In certain embodiments, the black salt is in an amount of about 2.45 g in the dry mixture. In certain embodiments, the amount of black salt in the dry egg replacement composition is about 1.5% of the dry mixture.
In certain embodiments, the onion powder is in an amount of about 0.5 g to about 10 g, about 1 g to about 8 g, about 2 g to about 6 g, or about 3 g to about 5 g in the dry mixture. In certain embodiments, the onion powder is in an amount of about 1.40 g in the dry mixture. In certain embodiments, the amount of onion powder in the dry egg replacement composition is about 1% of the dry mixture.
Color
The dry egg replacement composition and/or the egg replacement emulsion and/or liquid egg and/or liquid egg formulation and/or egg replacement formulation described herein is a similar color to the yolk of a natural egg. Accordingly, the dry egg replacement composition and/or the egg replacement emulsion and/or liquid egg and/or liquid egg formulation and/or egg replacement formulation described herein contains no added colors. The dry egg replacement composition and/or the egg replacement emulsion and/or liquid egg and/or liquid egg formulation and/or egg replacement formulation described herein has reduction or absence of undesirable characteristics typically found with algal compositions, for example green-color. Previous versions or commercially available products must utilize artificial coloring to achieve the natural yellow color. Color can be measured using colorimetric analyzer.
Stability
The dry egg replacement composition described herein has a shelf life which is longer than a natural egg at either room temperature, refrigerator temperature (about 2° C.), or freezer temperature (about −4° C.). In certain embodiments, the dry egg replacement composition contains no added preservatives. The dry egg replacement composition described herein has an enhanced shelf life at room temperature. In some embodiments, the shelf life at room temperature is greater than 3 months, greater than 4 months, greater than 5 months, greater than 6 months, greater than 7 months, greater than 8 months, greater than 9 months, greater than 10 months, greater than 11 months, or greater than 12 months. In some embodiments, the shelf life at room temperature is at least 6 months. The dry egg replacement composition described herein has an enhanced shelf life when stored in a refrigerator or freezer. In some embodiments, the shelf life when stored in a refrigerator or freezer is greater than 3 months, greater than 4 months, greater than 5 months, greater than 6 months, greater than 7 months, greater than 8 months, greater than 9 months, greater than 10 months, greater than 11 months, or greater than 12 months. In some embodiments, the shelf life when stored in a refrigerator or freezer is at least 6 months. In some embodiments, the dry egg replacement composition and/or the egg replacement emulsion and/or liquid egg and/or liquid egg formulation and/or egg replacement formulation described herein has the freeze stability and thaw stability of a natural egg.
Egg Replacement Emulsion
The egg replacement emulsion described herein has the consistency necessary to replace a natural egg in any food application. The egg replacement emulsion described herein has a property similar to a natural egg selected from the group consisting of emulsifying properties, viscosity, consistency, elasticity, springiness, solubility, coagulation, aeration, creaminess, film forming property, sheen addition, shine addition, and combinations thereof. Accordingly, the egg replacement emulsion described herein cooks in about the same time as a natural egg.
Embodiments described herein are directed to an egg replacement emulsion comprising a dry egg replacement composition, an oil, and water.
In certain embodiments, the dry egg replacement composition is about 5% to about 50%, about 10% to about 40%, about 15% to about 30%, or about 20% to about 25% of the egg replacement emulsion.
In embodiments described herein, theEuglena-derived material of the dry egg replacement composition can be selected from the group consisting of aEuglenabiomass, a protein-rich flour derived fromEuglena, a protein concentrate derived fromEuglena, or a protein isolate derived fromEuglena.
In certain embodiments, the dry egg replacement composition is in an amount of about 9 g to about 15 g, about 10 g to about 14 g, about 11 g to about 13 g, or about 12 g to about 12.5 g per serving size of the egg replacement emulsion. In certain embodiments, the dry egg replacement composition is in an amount of about 12.5 g per serving size of the egg replacement emulsion. In certain embodiments, the serving size of the egg replacement emulsion is from about 50 g to about 100 g, about 60 g to about 90 g, about 70 g to about 80 g, or about 80 g to about 90 g. In certain embodiments, the serving size of the egg replacement emulsion is from about 80 g to about 90 g.
In certain embodiments, the oil is about 5% to about 20%, about 8% to about 18%, about 10% to about 16%, or about 14% to about 14% of the egg replacement emulsion.
In certain embodiments, the amount of oil in the egg replacement emulsion is about 1 tablespoon to about 3 tablespoons. In some embodiments, the amount of oil used is about 1 tablespoon, about 2 tablespoons, or about 3 tablespoons. In some embodiments, the oil can be selected from the group consisting of vegetable oil, soybean oil, coconut oil, olive oil, peanut oil, fish oil, avocado oil, palm oil, flax oil, corn oil, cottonseed oil, canola oil, rapeseed oil, sunflower oil, safflower oil, sesame oil, grapeseed oil, safflower oil, rice bran oil, propionate, palm kernel oil,cupheaoil, camelinasativaoil, mustard seed oil, cashew nut oil, oat oil, lupine oil, kenaf oil, calendula oil, hemp oil, coffee oil, linseed oil, hazelnut oil,euphorbiaoil, pumpkin seed oil, coriander oil,camelliaoil, rice oil, tung oil tree oil, cocoa oil, copra oil, opium poppy oil, castor bean oil, pecan oil, jojoba oil, jatropha oil, macadamia oil, Brazil nut oil,Euglenaderived oil and combinations thereof.
In certain embodiments, the water is about 0.05% to about 80%, about 60% to about 85%, about 65% to about 80%, or about 70% to about 75% of the egg replacement emulsion. In certain embodiments, the water is about 10% to about 50% of the egg replacement emulsion. In certain embodiments, the water is about 50% to about 80% of the egg replacement emulsion.
In certain embodiments, the amount of water in the egg replacement emulsion is about ¼ cup to about 1 cup of water. In some embodiments, the amount of water used is about ¼ cup, about ¼ cup, about ¼ cup, ⅔ cup, ¾ cup, or 1 cup.
In some embodiments, the egg replacement emulsion described herein has the emulsifying properties of a natural egg.
In some embodiments, the egg replacement emulsion described herein has the viscosity of a natural egg. Apparent Viscosity is measured using a digital viscometer, which would effectively deliver results related to mouth feel, how a product will react to temperature changes, as well as the spread ability of the product.
In some embodiments, the egg replacement emulsion described herein has the consistency of a natural egg.
In some embodiments, the egg replacement emulsion described herein has the elasticity of a natural egg. In some embodiments, the egg replacement emulsion described herein exhibits an elasticity of greater than 300 Pa.
In some embodiments, the egg replacement emulsion described herein has the springiness of a natural egg.
In some embodiments, the egg replacement emulsion described herein has the solubility of a natural egg. Solubility can be measured by protein analysis (using colorimetric or Kjeldahl) of the supernatant after the emulsion is centrifuged to remove insoluble components.
In some embodiments, the egg replacement emulsion described herein has the coagulation of a natural egg.
In some embodiments, the egg replacement emulsion described herein has the aeration of a natural egg.
In some embodiments, the egg replacement emulsion described herein has the creaminess of a natural egg.
In some embodiments, the egg replacement emulsion described herein has the film forming property of a natural egg.
In some embodiments, the egg replacement emulsion described herein has the sheen addition and shine addition of a natural egg.
Liquid Egg
The liquid egg described herein has the consistency necessary to replace a natural egg in any food application. The liquid egg described herein has a property similar to a natural egg selected from the group consisting of emulsifying properties, viscosity, consistency, elasticity, springiness, solubility, coagulation, aeration, creaminess, film forming property, sheen addition, shine addition, and combinations thereof. Accordingly, the liquid egg described herein cooks in about the same time as a natural egg.
Embodiments described herein are directed to a liquid egg comprising a dry egg replacement composition, an oil, and water.
In certain embodiments, the dry egg replacement composition is about 5% to about 50%, about 10% to about 40%, about 15% to about 30%, or about 20% to about 25% of the liquid egg.
In embodiments described herein, theEuglena-derived material is selected from the group consisting of aEuglenabiomass, aEuglena-derived protein, a protein-rich flour derived fromEuglena, a protein concentrate derived fromEuglena, a protein isolate derived fromEuglena, aEuglena-derived beta-glucan isolate, aEuglena-derived oil, and combinations thereof.
In certain embodiments, the dry egg replacement composition is in an amount of about 9 g to about 15 g, about 10 g to about 14 g, about 11 g to about 13 g, or about 12 g to about 12.5 g per serving size of the liquid egg. In certain embodiments, the dry egg replacement composition is in an amount of about 12.5 g per serving size of the liquid egg. In certain embodiments, the serving size of the liquid egg is from about 50 g to about 100 g, about 60 g to about 90 g, about 70 g to about 80 g, or about 80 g to about 90 g. In certain embodiments, the serving size of the liquid egg is from about 80 g to about 90 g.
In certain embodiments, the oil is about 5% to about 20%, about 8% to about 18%, about 10% to about 16%, or about 14% to about 14% of the liquid egg.
In certain embodiments, the amount of oil in the liquid egg is about 1 tablespoon to about 3 tablespoons. In some embodiments, the amount of oil used is about 1 tablespoon, about 2 tablespoons, or about 3 tablespoons. In some embodiments, the oil can be selected from the group consisting of vegetable oil, soybean oil, coconut oil, olive oil, peanut oil, fish oil, avocado oil, palm oil, flax oil, corn oil, cottonseed oil, canola oil, rapeseed oil, sunflower oil, safflower oil, sesame oil, grapeseed oil, safflower oil, rice bran oil, propionate, palm kernel oil,cupheaoil, camelinasativaoil, mustard seed oil, cashew nut oil, oat oil, lupine oil, kenaf oil, calendula oil, hemp oil, coffee oil, linseed oil, hazelnut oil,euphorbiaoil, pumpkin seed oil, coriander oil,camelliaoil, rice oil, tung oil tree oil, cocoa oil, copra oil, opium poppy oil, castor bean oil, pecan oil, jojoba oil, jatropha oil, macadamia oil, Brazil nut oil,Euglenaderived oil and combinations thereof.
In certain embodiments, the water is about 0.05% to about 80%, about 60% to about 85%, about 65% to about 80%, or about 70% to about 75% of the liquid egg. In certain embodiments, the water is about 10% to about 50% of the liquid egg. In certain embodiments, the water is about 50% to about 80% of the liquid egg.
In certain embodiments, the amount of water in the liquid egg is about ¼ cup to about 1 cup of water. In some embodiments, the amount of water used is about ¼ cup, about ¼ cup, about ½ cup, ⅔ cup, ¾ cup, or 1 cup.
In some embodiments, the liquid egg described herein has the emulsifying properties of a natural egg.
In some embodiments, the liquid egg described herein has the viscosity of a natural egg. Apparent Viscosity is measured using a digital viscometer, which would effectively deliver results related to mouth feel, how a product will react to temperature changes, as well as the spread ability of the product.
In some embodiments, the liquid egg described herein has the consistency of a natural egg.
In some embodiments, the liquid egg described herein has the elasticity of a natural egg. In some embodiments, the liquid egg herein exhibits an elasticity of greater than 300 Pa.
In some embodiments, the liquid egg described herein has the springiness of a natural egg.
In some embodiments, the liquid egg described herein has the solubility of a natural egg. Solubility can be measured by protein analysis (using colorimetric or Kjeldahl) of the supernatant after the emulsion is centrifuged to remove insoluble components.
In some embodiments, the liquid egg described herein has the coagulation of a natural egg.
In some embodiments, the liquid egg described herein has the aeration of a natural egg.
In some embodiments, the liquid egg described herein has the creaminess of a natural egg.
In some embodiments, the liquid egg described herein has the film forming property of a natural egg.
In some embodiments, the liquid egg described herein has the sheen addition and shine addition of a natural egg.
Liquid Egg Using FreshEuglena-Derived Material
The liquid egg described herein has the consistency necessary to replace a natural egg in any food application. The liquid egg described herein has a property similar to a natural egg selected from the group consisting of emulsifying properties, viscosity, consistency, elasticity, springiness, solubility, coagulation, aeration, creaminess, film forming property, sheen addition, shine addition, and combinations thereof. Accordingly, the liquid egg described herein cooks in about the same time as a natural egg.
Embodiments described herein are directed to a liquid egg formulation comprising about 50% to about 85% freshEuglena-derived material, about 5% to about 10% pea protein, water, and one or more additional ingredient, wherein the liquid egg formulation comprises one or more functional property of a natural egg.
Embodiments described herein are directed to a liquid egg formulation comprising about 1% to about 100% freshEuglena-derived material, about 0.05% to about 70% additional protein source, water, and one or more additional ingredient, wherein the liquid egg formulation comprises one or more functional property of a natural egg.
In some embodiments of the liquid egg formulation described herein, the additional protein source is selected from the group consisting of pea protein, soy protein, corn protein, wheat protein, rice protein, beans protein, seed protein, nut protein, almond protein, peanut protein, seitan protein, lentil protein, chickpea protein, flaxseed protein, wild rice protein, quorn protein, chia seed protein,quinoaprotein, oat protein, fava bean protein, buckwheat protein, bulgar protein, millet protein, microalgae protein, yellow pea protein, mung bean protein, hemp protein, sunflower protein, canola protein, lupin protein, legumes protein, potato protein, and combinations thereof.
In some embodiments of the liquid egg formulation described herein, the additional protein source is in an amount of about 0.05% to about 70%, about 0.5% to about 70%, about 1% to about 70%, about 5% to about 70%, about 10% to about 70%, about 15% to about 70%, about 0.05% to about 60%, about 0.05% to about 50%, about 0.05% to about 40%, about 0.05% to about 30%, or about 0.05% to about 20%. In certain embodiments of the liquid egg formulation described herein, the additional protein source is in an amount of about 0.05% to about 15%. In certain embodiments of the liquid egg formulation described herein, the additional protein source is in an amount of about 20% to about 60%.
In some embodiments, the freshEuglena-derived material is in an amount of about 5% to about 90%, about 50% to about 85%, about 50% to about 75%, about 50% to about 65%, about 60% to about 85%, or about 70% to about 85% in the liquid mixture. In certain embodiments, the freshEuglena-derived material is in an amount of about 55% in the liquid mixture. In certain embodiments, the freshEuglena-derived material is in an amount of about 62% in the liquid mixture. In certain embodiments, the freshEuglena-derived material is in an amount of about 7% in the liquid mixture. In certain embodiments, the freshEuglena-derived material is in an amount of about 40% to about 87% in the liquid mixture. In certain embodiments, the freshEuglena-derived material is in an amount of about 40% to about 90% in the liquid mixture.
In some embodiments, the pea protein is in an amount of about 5% to about 10%, about 5% to about 15%, about 5% to about 20%, about 5% to about 25%, or about 7.5% to about 10% in the liquid mixture. In certain embodiments, the pea protein is in an amount of about 5.5% in the dry mixture. In certain embodiments, the pea protein is in an amount of about 6% in the dry mixture.
In some embodiments of the liquid egg formulation described herein, the freshEuglena-derived material is selected from the group consisting of a freshEuglenabiomass,Euglena-derived protein, a protein-rich flour derived fromEuglena, a protein concentrate derived fromEuglena, a protein isolate derived fromEuglena, Euglena-derived beta-glucan isolate,Euglena-derived oils, and combinations thereof.
In some embodiments of the liquid egg formulation described herein, the one or more additional ingredient is selected from the group consisting of gellan gum, methylcellulose, yeast extract, baking powder, sunflower lecithin, tranglutaminase, flavoring, and combinations thereof.
In some embodiments of the liquid egg formulation described herein, the one or more additional ingredient is selected from the group consisting of water, gellan gum, methylcellulose, yeast extract, flavoring, antioxidant blend, maskers, leavening agents, baking powder, baking soda, enzymes, transglutaminase, emulsifiers, lecithin, mono- and diglycerides, binders, carrot fiber, defatted linseed flour, and combinations thereof.
In some embodiments of the liquid egg formulation described herein, each of the one or more additional ingredient is in an amount of about 0.05% to about 5%, about 0.05% to about 4%, or about 0.05% to about 3%, or about 0.05% to about 2%. In certain embodiments of the liquid egg formulation described herein, each of the one or more additional ingredient is in an amount of about 0.1% to about 1%.
In some embodiments of the liquid egg formulation described herein, the liquid egg formulation further comprises an oil. In some embodiments, the oil can be selected from the group consisting of vegetable oil, soybean oil, coconut oil, olive oil, peanut oil, fish oil, avocado oil, palm oil, flax oil, corn oil, cottonseed oil, canola oil, rapeseed oil, sunflower oil, safflower oil, sesame oil, grapeseed oil, safflower oil, rice bran oil, propionate, palm kernel oil,cupheaoil, camelinasativaoil, mustard seed oil, cashew nut oil, oat oil, lupine oil, kenaf oil, calendula oil, hemp oil, coffee oil, linseed oil, hazelnut oil,euphorbiaoil, pumpkin seed oil, coriander oil,camelliaoil, rice oil, tung oil tree oil, cocoa oil, copra oil, opium poppy oil, castor bean oil, pecan oil, jojoba oil, jatropha oil, macadamia oil, Brazil nut oil,Euglenaderived oil and combinations thereof.
In some embodiments of the liquid egg formulation described herein, the flavoring is selected from the group consisting of black salt, black pepper, Himalayan sea salt, salt, onion powder, minced onion, roasted garlic, mushroom powder, yeast extract, or a combination thereof. In some embodiments, the liquid egg formulation described herein the flavoring is black salt and onion powder.
In some embodiments of the liquid egg formulation described herein, the liquid egg formulation further comprises one or more hydrocolloids. In some embodiments each of the one or more hydrocolloids may be selected from the group consisting of locust bean gum, a guar gum, a konjac gum, a gellan gum, a high methoxy pectin, a low methoxy pectin, an Agar, a kappa carrageenan, an iota carrageenan, a lambda carrageenan, an alginate, a curdlan, a methyl cellulose, a carboxymethyl cellulose (CMC), a xanthan gum, a gum Arabic, aEuglenaderived beta-glucan and combinations thereof.
In some embodiments of the liquid egg formulation described herein, each of the one or more hydrocolloids is in an amount of about 0.05% to about 8%, about 0.1% to about 8%, about 0.05% to about 7%, about 0.05% to about 6%, about 0.05% to about 5%, about 0.05% to about 4%, or about 0.05% to about 3%. In certain embodiments of the liquid egg formulation described herein, each of the one or more hydrocolloids is in an amount of about 0.1% to about 2%.
In some embodiments of the liquid egg formulation described herein, the liquid egg formulation contains at least 3.0 g of protein, at least 3.5 g of protein, at least 4.0 g of protein, at least 4.5 g of protein, at least 5.0 g of protein, at least 5.5 g of protein, at least 6.0 g of protein, at least 6.5 g of protein, at least 7.0 g of protein, at least 7.5 g of protein, at least 8.0 g of protein, at least 8.5 g of protein, or at least 9.0 g of protein. In certain embodiments of the liquid egg formulation described herein, the liquid egg formulation contains at least 5 g of protein. In certain embodiments of the liquid egg formulation described herein, the liquid egg formulation contains at least 7.5 g of protein.
In some embodiments, the liquid egg formulation has a ratio of freshEuglena-derived material to pea protein of about 15:1 to about 5:1. In some embodiments, the liquid egg formulation has a ratio of freshEuglena-derived material to pea protein of about 7.5:1 to about 5:1. In some embodiments the liquid egg formulation has a ratio of freshEuglena-derived material to pea protein of about 15:1 to about 7.5:1. In certain embodiments the liquid egg formulation has a ratio of freshEuglena-derived material to pea protein of about 10:1.
In some embodiments of the liquid egg formulation described herein, the water is in an amount of about 10% to about 35%, about 15% to about 35%, about 20% to about 35%, about 25% to about 35%, about 10% to about 30%, about 10% to about 25%, about 0.05% to about 80%, about 60% to about 85%, about 65% to about 80%, or about 70% to about 75% of the liquid egg formulation. In certain embodiments of the liquid egg formulation described herein, the water is in an amount of about 33% of the liquid egg formulation. In certain embodiments of the liquid egg formulation described herein, the water is in an amount of about 24% of the liquid egg formulation. In certain embodiments, the water is about 10% to about 50% of the liquid egg formulation. In certain embodiments, the water is about 50% to about 80% of the liquid egg formulation.
In some embodiments of the liquid egg formulation described herein, the oil is in an amount of about 2.5% to about 7.5%, about 3.0% to about 7.5%, about 3.5% to about 7.5%, about 4.0% to about 7.5%, about 4.5% to about 7.5%, about 2.5% to about 7.0%, about 2.5% to about 6.5%, about 2.5% to about 6.0%, or about 2.5% to about 5.5%. In certain embodiments of the liquid egg formulation described herein, the oil is in an amount of about 4.5%. In certain embodiments of the liquid egg formulation described herein, the oil is in an amount of about 5%. In certain embodiments of the liquid egg formulation described herein, the oil is in an amount of about 0.05% to about 10%. In certain embodiments of the liquid egg formulation described herein, the oil is in an amount of about 0.05% to about 20%.
In some embodiments of the liquid egg formulation described herein, the gellan gum is in an amount of 0.2% to about 1%, amount of 0.3% to about 1%, amount of 0.4% to about 1%, amount of 0.2% to about 0.9%, amount of 0.2% to about 0.8%, amount of 0.2% to about 0.7%, or amount of 0.2% to about 0.6%. In certain embodiments of the liquid egg formulation described herein, the gellan gum is in an amount of about 0.44%. In certain embodiments of the liquid egg formulation described herein, the gellan gum is in an amount of about 0.50%.
In some embodiments of the liquid egg formulation described herein, the methylcellulose is in an amount of about 0.5% to about 1%, about 0.6% to about 1%, about 0.5% to about 0.9%, or about 0.5% to about 0.8%. In certain embodiments of the liquid egg formulation described herein, the methylcellulose is in an amount of about 0.66%. In certain embodiments of the liquid egg formulation described herein, the methylcellulose is in an amount of about 0.77%.
In some embodiments of the liquid egg formulation described herein, the ratio of gellan gum to methyl cellulose is about 1:5, about 2:5, about 1:4, or about 1:3. In certain embodiments of the liquid egg formulation described herein, the ratio of gellan gum to methyl cellulose is about 2:3.
In some embodiments of the liquid egg formulation described herein, the yeast extract is in an amount of about 0.2% to about 0.5%, about 0.3% to about 0.5%, or about 0.2% to about 0.4%. In certain embodiments of the liquid egg formulation described herein, the yeast extract is in an amount of about 0.33%. In certain embodiments of the liquid egg formulation described herein, the yeast extract is in an amount of about 0.37%.
In some embodiments of the liquid egg formulation described herein, the baking powder is in an amount of about 0.1% to about 0.5%, about 0.2% to about 0.5%, about 0.1% to about 0.4%, or about 0.1% to about 0.3%. In certain embodiments of the liquid egg formulation described herein, the baking powder is in an amount of about 0.22%. In certain embodiments of the liquid egg formulation described herein, the baking powder is in an amount of about 0.25%.
In some embodiments of the liquid egg formulation described herein, the sunflower lecithin is in an amount of about 0.1% to about 0.5%, about 0.2% to about 0.5%, about 0.1% to about 0.4%, or about 0.1% to about 0.3%. In certain embodiments of the liquid egg formulation described herein, the sunflower lecithin is in an amount of about 0.29%.
In some embodiments of the liquid egg formulation described herein, the transglutaminase is in an amount of about 0.1% to about 0.5%, about 0.2% to about 0.5%, about 0.1% to about 0.4%, or about 0.1% to about 0.3%. In certain embodiments of the liquid egg formulation described herein, the transglutaminase is in an amount of about 0.25%.
In some embodiments of the liquid egg formulation described herein, the flavoring is in an amount of about 0.05% to about 0.5%, about 0.1% to about 0.5%, about 0.1% to about 0.4%, or about 0.1% to about 0.3%. In certain embodiments of the liquid egg formulation described herein, the flavoring is in an amount of about 0.3%. In certain embodiments of the liquid egg formulation described herein, the flavoring is in an amount of about 0.1% to about 1%.
In embodiments described herein, the liquid egg formulation has one or more functional property of a natural egg. In some embodiments, the liquid egg formulation has at least 2 functional properties of a natural egg. In some embodiments, the one or more functional property of a natural egg is selected from the group consisting of complete nutrition, protein digestibility-corrected amino acid score (PDCAAS), gelation, foaming, viscosity, emulsification, water binding capacity, texture, elasticity, springiness, solubility, flavor, coagulation, aeration, creaminess, film forming property, sheen addition, shine addition, freeze stability, thaw stability, color, and combinations thereof
Liquid Egg UsingEuglena-Derived Wet Protein Concentrate
The liquid egg described herein has the consistency necessary to replace a natural egg in any food application. The liquid egg described herein has a property similar to a natural egg selected from the group consisting of emulsifying properties, viscosity, consistency, elasticity, springiness, solubility, coagulation, aeration, creaminess, film forming property, sheen addition, shine addition, and combinations thereof. Accordingly, the liquid egg described herein cooks in about the same time as a natural egg.
Embodiments described herein are directed to a liquid egg formulation comprising about 12% to about 95%Euglena-derived wet protein concentrate, about 1% to about 20% solid content, water, and one or more additional ingredient, wherein the liquid egg formulation comprises one or more functional property of a natural egg.
Embodiments described herein are directed to a liquid egg formulation comprising about 1% to about 100%Euglena-derived wet protein concentrate, about 1% to about 20% solid content, an additional protein source, water, and one or more additional ingredient, wherein the liquid egg formulation comprises one or more functional property of a natural egg.
In some embodiments of the liquid egg formulation described herein, the additional protein source is selected from the group consisting of pea protein, soy protein, corn protein, wheat protein, rice protein, beans protein, seed protein, nut protein, almond protein, peanut protein, seitan protein, lentil protein, chickpea protein, flaxseed protein, wild rice protein, quorn protein, chia seed protein,quinoaprotein, oat protein, fava bean protein, buckwheat protein, bulgar protein, millet protein, microalgae protein, yellow pea protein, mung bean protein, hemp protein, sunflower protein, canola protein, lupin protein, legumes protein, potato protein, and combinations thereof.
In some embodiments of the liquid egg formulation described herein, the additional protein source is in an amount of about 0.05% to about 70%, about 0.5% to about 70%, about 1% to about 70%, about 5% to about 70%, about 10% to about 70%, about 15% to about 70%, about 0.05% to about 60%, about 0.05% to about 50%, about 0.05% to about 40%, about 0.05% to about 30%, or about 0.05% to about 20%. In certain embodiments of the liquid egg formulation described herein, the additional protein source is in an amount of about 0.05% to about 15%. In certain embodiments of the liquid egg formulation described herein, the additional protein source is in an amount of about 20% to about 60%.
In some embodiments, theEuglena-derived wet protein concentrate is in an amount of about 5% to about 90%, about 15% to about 95%, about 20% to about 95%, about 25% to about 95%, about 30% to about 95%, about 30% to about 95%, about 35% to about 95%, about 40% to about 95%, about 45% to about 95%, about 50% to about 95%, about 55% to about 95%, in the liquid mixture. In certain embodiments, theEuglena-derived wet protein concentrate is in an amount of about 94% in the liquid mixture. In certain embodiments, theEuglena-derived wet protein concentrate is in an amount of about 56% in the liquid mixture. In certain embodiments, theEuglena-derived wet protein concentrate is in an amount of about 7% in the liquid mixture. In certain embodiments, theEuglena-derived wet protein concentrate is in an amount of about 40% to about 87% in the liquid mixture. In certain embodiments, theEuglena-derived wet protein concentrate is in an amount of about 40% to about 90% in the liquid mixture.
In some embodiments of the liquid egg formulation described herein, the solid content is in an amount of about 1% to about 20%, about 2% to about 20%, about 3% to about 20%, about 4% to about 20%, about 5% to about 20%, about 1% to about 19%, about 1% to about 18%, about 1% to about 17%, about 1% to about 16%, or about 1% to about 15%. In certain embodiments of the liquid egg formulation described herein, the solid content is in an amount of about 5%. In certain embodiments of the liquid egg formulation described herein, the solid content is in an amount of about 15%.
In some embodiments, theEuglena-derived wet protein concentrate is anEuglena-derived protein isolate.
In some embodiments, theEuglena-derived wet protein concentrate is about 25% to about 80% protein, about 30% to about 80% protein, about 35% to about 80% protein, about 40% to about 80% protein, about 45% to about 80% protein, about 50% to about 80% protein, about 55% to about 80% protein, about 60% to about 80% protein, about 65% to about 80% protein, or about 25% to about 75% protein. In certain embodiments, theEuglena-derived wet protein concentrate is about 70% protein.
In some embodiments of the liquid egg formulation described herein, the one or more additional ingredient is selected from the group consisting of an oil, water, gellan gum, methylcellulose, yeast extract, baking powder, sunflower lecithin, flavoring, and combinations thereof.
In some embodiments of the liquid egg formulation described herein, the one or more additional ingredient is selected from the group consisting of gellan gum, methylcellulose, yeast extract, flavoring, antioxidant blend, maskers, leavening agents, baking powder, baking soda, enzymes, transglutaminase, emulsifiers, lecithin, mono- and diglycerides, binders, carrot fiber, defatted linseed flour, and combinations thereof.
In some embodiments of the liquid egg formulation described herein, each of the one or more additional ingredient is in an amount of about 0.05% to about 5%, about 0.05% to about 4%, or about 0.05% to about 3%, or about 0.05% to about 2%. In certain embodiments of the liquid egg formulation described herein, each of the one or more additional ingredient is in an amount of about 0.1% to about 1%.
In some embodiments of the liquid egg formulation described herein, the liquid egg formulation further comprises an oil. In some embodiments, the oil can be selected from the group consisting of vegetable oil, soybean oil, coconut oil, olive oil, peanut oil, fish oil, avocado oil, palm oil, flax oil, corn oil, cottonseed oil, canola oil, rapeseed oil, sunflower oil, safflower oil, sesame oil, grapeseed oil, safflower oil, rice bran oil, propionate, palm kernel oil,cupheaoil, camelinasativaoil, mustard seed oil, cashew nut oil, oat oil, lupine oil, kenaf oil, calendula oil, hemp oil, coffee oil, linseed oil, hazelnut oil,euphorbiaoil, pumpkin seed oil, coriander oil,camelliaoil, rice oil, tung oil tree oil, cocoa oil, copra oil, opium poppy oil, castor bean oil, pecan oil, jojoba oil, jatropha oil, macadamia oil, Brazil nut oil,Euglenaderived oil and combinations thereof.
In some embodiments of the liquid egg formulation described herein, the flavoring is selected from the group consisting of black salt, black pepper, Himalayan sea salt, salt, onion powder, minced onion, roasted garlic, mushroom powder, yeast extract, or a combination thereof. In some embodiments, the liquid egg formulation described herein the flavoring is black salt and onion powder.
In some embodiments of the liquid egg formulation described herein, the liquid egg formulation further comprises one or more hydrocolloids. In some embodiments the one or more hydrocolloids may be selected from the group consisting of locust bean gum, a guar gum, a konjac gum, a gellan gum, a high methoxy pectin, a low methoxy pectin, an Agar, a kappa carrageenan, an iota carrageenan, a lambda carrageenan, an alginate, a curdlan, a methyl cellulose, a carboxymethyl cellulose (CMC), a xanthan gum, a gum Arabic, aEuglenaderived beta-glucan and combinations thereof.
In some embodiments of the liquid egg formulation described herein, each of the one or more hydrocolloids is in an amount of about 0.05% to about 8%, about 0.1% to about 8%, about 0.05% to about 7%, about 0.05% to about 6%, about 0.05% to about 5%, about 0.05% to about 4%, or about 0.05% to about 3%. In certain embodiments of the liquid egg formulation described herein, each of the one or more hydrocolloids is in an amount of about 0.1% to about 2%.
In some embodiments of the liquid egg formulation described herein, the liquid egg formulation contains at least 3.0 g of protein, at least 3.5 g of protein, at least 4.0 g of protein, at least 4.5 g of protein, at least 5.0 g of protein, at least 5.5 g of protein, at least 6.0 g of protein, at least 6.5 g of protein, at least 7.0 g of protein, at least 7.5 g of protein, at least 8.0 g of protein, at least 8.5 g of protein, or at least 9.0 g of protein. In certain embodiments of the liquid egg formulation described herein, the liquid egg formulation contains at least 5.6 g of protein. In certain embodiments of the liquid egg formulation described herein, the liquid egg formulation contains at least 5 g of protein.
In some embodiments of the liquid egg formulation described herein, the ratio ofEuglena-derived wet protein concentrate to solid content is about 95:1 to about 1.6:1, about 70:1 to about 1.6:1, about 45:1 to about 1.6:1, about 20:1 to about 1.6:1, about 10:1 to about 1.6:1, or about 5:1 to about 1.6:1. In certain embodiments of the liquid egg formulation described herein, the ratio ofEuglena-derived wet protein concentrate to solid content is about 3.7:1.
In some embodiments of the liquid egg formulation described herein, the oil is in an amount of about 0.05% to about 20%, about 2.5% to about 7.5%, about 3.0% to about 7.5%, about 3.5% to about 7.5%, about 4.0% to about 7.5%, about 4.5% to about 7.5%, about 2.5% to about 7.0%, about 2.5% to about 6.5%, about 2.5% to about 6.0%, or about 2.5% to about 5.5%. In certain embodiments of the liquid egg formulation described herein, the oil is in an amount of about 5%. In certain embodiments of the liquid egg formulation described herein, the oil is in an amount of about 4.5%. In certain embodiments of the liquid egg formulation described herein, the oil is in an amount of about 0.05% to about 10%.
In some embodiments of the liquid egg formulation described herein, the water is in an amount of about 10% to about 50%, about 15% to about 50%, about 20% to about 50%, about 25% to about 50%, about 30% to about 50%, about 35% to about 50%, about 10% to about 45%, about 10% to about 40%, about 0.05% to about 80%, about 60% to about 85%, about 65% to about 80%, or about 70% to about 75% of the liquid egg formulation. In certain embodiments of the liquid egg formulation described herein, the water is in an amount of about 37% of the liquid egg formulation of the liquid egg formulation. In certain embodiments, the water is about 10% to about 50% of the liquid egg formulation. In certain embodiments, the water is about 50% to about 80% of the liquid egg formulation. In certain embodiments, the water is about 0.05% to about 80% of the liquid egg formulation.
In some embodiments of the liquid egg formulation described herein, the gellan gum is in an amount of 0.1% to about 1%, amount of 0.2% to about 1%, amount of 0.1% to about 0.9%, amount of 1% to about 0.8%, amount of 0.1% to about 0.7%, amount of 0.1% to about 0.6%, or amount of 0.1% to about 0.5%. In certain embodiments of the liquid egg formulation described herein, the gellan gum is in an amount of about 0.23%. In certain embodiments of the liquid egg formulation described herein, the gellan gum is in an amount of about 0.46%.
In some embodiments of the liquid egg formulation described herein, the methylcellulose is in an amount of about 0.1% to about 1.25%, about 0.2% to about 1.25%, about 0.3% to about 1.25%, about 0.1% to about 1%, about 0.1% to about 0.8%, or about 0.1% to about 0.8%. In certain embodiments of the liquid egg formulation described herein, the methylcellulose is in an amount of about 0.35%. In certain embodiments of the liquid egg formulation described herein, the methylcellulose is in an amount of about 0.83%.
In some embodiments of the liquid egg formulation described herein, the ratio of gellan gum to methyl cellulose is about 1:10, about 2:10, about 1:9, or about 2:9. In certain embodiments of the liquid egg formulation described herein, the ratio of gellan gum to methyl cellulose is about 2:3. In certain embodiments of the liquid egg formulation described herein, the ratio of gellan gum to methyl cellulose is about 5:9.
In some embodiments of the liquid egg formulation described herein, the yeast extract is in an amount of about 0.1% to about 0.5%, about 0.2% to about 0.5%, about 0.1% to about 0.4%, or about 0.1% to about 0.3%. In certain embodiments of the liquid egg formulation described herein, the yeast extract is in an amount of about 0.23%. In certain embodiments of the liquid egg formulation described herein, the yeast extract is in an amount of about 0.28%.
In some embodiments of the liquid egg formulation described herein, the baking powder is in an amount of about 0.1% to about 0.75%, about 0.2% to about 0.75%, about 0.1% to about 0.7%, 0.1% to about 0.6%, 0.1% to about 0.5%, or about 0.1% to about 0.4%. In certain embodiments of the liquid egg formulation described herein, the baking powder is in an amount of about 0.23%. In certain embodiments of the liquid egg formulation described herein, the baking powder is in an amount of about 0.46%.
In some embodiments of the liquid egg formulation described herein, the sunflower lecithin is in an amount of about 0.1% to about 0.5%, about 0.2% to about 0.5%, about 0.1% to about 0.4%, or about 0.1% to about 0.3%. In certain embodiments of the liquid egg formulation described herein, the sunflower lecithin is in an amount of about 0.23%. In certain embodiments of the liquid egg formulation described herein, the sunflower lecithin is in an amount of about 0.28%.
In some embodiments of the liquid egg formulation described herein, the flavoring is in an amount of about 0.05% to about 0.5%, about 0.05% to about 0.4%, about 0.1% to about 0.5%, about 0.15% to about 0.5%, or about 0.2% to about 0.5%. In certain embodiments of the liquid egg formulation described herein, the flavoring is in an amount of about 0.25%. In certain embodiments of the liquid egg formulation described herein, the flavoring is in an amount of about 0.46%. In certain embodiments of the liquid egg formulation described herein, the flavoring is in an amount of about 0.1% to about 1%.
In embodiments described herein, the liquid egg formulation has one or more functional property of a natural egg. In some embodiments, the liquid egg formulation has at least 2 functional properties of a natural egg. In some embodiments, the one or more functional property of a natural egg is selected from the group consisting of complete nutrition, protein digestibility-corrected amino acid score (PDCAAS), gelation, foaming, viscosity, emulsification, water binding capacity, texture, elasticity, springiness, solubility, flavor, coagulation, aeration, creaminess, film forming property, sheen addition, shine addition, freeze stability, thaw stability, color, and combinations thereof.
For the liquid egg formulations using fresh biomass or wet or powderedEuglenaprotein concentrate maskers are required to mask the marine flavours ofEuglena. An ideal masker should completely mask the off notes (both aroma and flavour) coming fromEuglenaduring cooking and in cooked products without introducing any new flavours or aroma. Flavours can also be used to improve the flavour of cooked liquid egg. Ideal flavour should provide a flavour that is similar to cooked real egg. Since the amount ofEuglenais higher in protein concentrate a higher amount of masker/flavour will be required for protein concentrate based liquid egg formulations. In certain embodiments, the dry egg replacement, egg replacement emulsion, liquid egg, or liquid egg formulation described herein further comprise one or more maskers. In certain embodiments, the maskers can be purchased from Firmenich, IFF, Givaudan, Symrise, Mane, Fona, Flavor producer, McCormick, edlong, T⋅Hasegawa. Sensient Flavors, Robertet SA, Prova, Wild/ADM, Takasago, Synergy, and others.
Egg Replacement Formulation
The egg replacement formulation described herein has the consistency necessary to replace a natural egg in any food application. The liquid egg described herein has a property similar to a natural egg selected from the group consisting of emulsifying properties, viscosity, consistency, elasticity, springiness, solubility, coagulation, aeration, creaminess, film forming property, sheen addition, shine addition, and combinations thereof. Accordingly, the egg replacement formulation described herein cooks in about the same time as a natural egg.
Embodiments described herein are directed to an egg replacement formulation comprising about 1% to about 100%Euglena-derived material, about 0.05% to about 70% additional protein source, and one or more additional ingredient, wherein the egg replacement formulation comprises one or more functional property of a natural egg.
In some embodiments of the egg replacement formulation described herein, theEuglena-derived material is a dry material. In some embodiments of the egg replacement formulation described herein, theEuglena-derived material is a wet material.
In some embodiments of the egg replacement formulation described herein, theEuglena-derived material is selected from the group consisting of a freshEuglenabiomass, aEuglenabiomass, aEuglena-derived protein, a protein-rich flour derived fromEuglena, a protein concentrate derived fromEuglena, a protein isolate derived fromEuglena, aEuglena-derived beta-glucan isolate, aEuglena-derived oil, aEuglena-derived wet protein concentrate, aEuglena-derived protein isolate and combinations thereof.
In some embodiments of the egg replacement formulation described herein, theEuglena-derived material is in an amount of about 5% to about 90%, about 50% to about 85%, about 50% to about 75%, about 50% to about 65%, about 60% to about 85%, or about 70% to about 85% in the mixture. In certain embodiments, theEuglena-derived material is in an amount of about 55% in the mixture. In certain embodiments, theEuglena-derived material is in an amount of about 62% in the mixture. In certain embodiments, theEuglena-derived material is in an amount of about 7% in the mixture. In certain embodiments, theEuglena-derived material is in an amount of about 40% to about 87% in the mixture. In certain embodiments, theEuglena-derived material is in an amount of about 40% to about 90% in the mixture.
In some embodiments of the egg replacement formulation described herein, the additional protein source is selected from the group consisting of pea protein, soy protein, corn protein, wheat protein, rice protein, beans protein, seed protein, nut protein, almond protein, peanut protein, seitan protein, lentil protein, chickpea protein, flaxseed protein, wild rice protein, quorn protein, chia seed protein,quinoaprotein, oat protein, fava bean protein, buckwheat protein, bulgar protein, millet protein, microalgae protein, yellow pea protein, mung bean protein, hemp protein, sunflower protein, canola protein, lupin protein, legumes protein, potato protein, and combinations thereof.
In some embodiments of the egg replacement formulation described herein, the additional protein source is in an amount of about 0.05% to about 70%, about 0.5% to about 70%, about 1% to about 70%, about 5% to about 70%, about 10% to about 70%, about 15% to about 70%, about 0.05% to about 60%, about 0.05% to about 50%, about 0.05% to about 40%, about 0.05% to about 30%, or about 0.05% to about 20%. In certain embodiments of the egg replacement formulation described herein, the additional protein source is in an amount of about 0.05% to about 15%. In certain embodiments of the egg replacement formulation described herein, the additional protein source is in an amount of about 20% to about 60%.
In some embodiments of the egg replacement formulation described herein, the one or more additional ingredient is selected from the group consisting of gellan gum, methylcellulose, yeast extract, flavoring, antioxidant blend, maskers, leavening agents, baking powder, baking soda, enzymes, transglutaminase, emulsifiers, lecithin, mono- and diglycerides, binders, carrot fiber, defatted linseed flour, and combinations thereof.
In some embodiments of the egg replacement formulation described herein, each of the one or more additional ingredient is in an amount of about 0.05% to about 5%, about 0.05% to about 4%, or about 0.05% to about 3%, or about 0.05% to about 2%. In certain embodiments of the egg replacement formulation described herein, each of the one or more additional ingredient is in an amount of about 0.1% to about 1%.
In some embodiments of the egg replacement formulation described herein, the egg replacement formulation further comprises an oil. In some embodiments, the oil can be selected from the group consisting of vegetable oil, soybean oil, coconut oil, olive oil, peanut oil, fish oil, avocado oil, palm oil, flax oil, corn oil, cottonseed oil, canola oil, rapeseed oil, sunflower oil, safflower oil, sesame oil, grapeseed oil, safflower oil, rice bran oil, propionate, palm kernel oil,cupheaoil, camelinasativaoil, mustard seed oil, cashew nut oil, oat oil, lupine oil, kenaf oil, calendula oil, hemp oil, coffee oil, linseed oil, hazelnut oil,euphorbiaoil, pumpkin seed oil, coriander oil,camelliaoil, rice oil, tung oil tree oil, cocoa oil, copra oil, opium poppy oil, castor bean oil, pecan oil, jojoba oil, jatropha oil, macadamia oil, Brazil nut oil,Euglenaderived oil and combinations thereof.
In some embodiments of the egg replacement formulation described herein, the oil is in an amount of about 0.05% to about 20%, about 2.5% to about 7.5%, about 3.0% to about 7.5%, about 3.5% to about 7.5%, about 4.0% to about 7.5%, about 4.5% to about 7.5%, about 2.5% to about 7.0%, about 2.5% to about 6.5%, about 2.5% to about 6.0%, or about 2.5% to about 5.5%. In certain embodiments of the egg replacement formulation described herein, the oil is in an amount of about 5%. In certain embodiments of the egg replacement formulation described herein, the oil is in an amount of about 4.5%. In certain embodiments of the egg replacement formulation described herein, the oil is in an amount of about 0.05% to about 10%.
In some embodiments of the egg replacement formulation described herein, the egg replacement formulation further comprises one or more hydrocolloids. In some embodiments the one or more hydrocolloids may be selected from the group consisting of locust bean gum, a guar gum, a konjac gum, a gellan gum, a high methoxy pectin, a low methoxy pectin, an Agar, a kappa carrageenan, an iota carrageenan, a lambda carrageenan, an alginate, a curdlan, a methyl cellulose, a carboxymethyl cellulose (CMC), a xanthan gum, a gum Arabic, aEuglenaderived beta-glucan and combinations thereof.
In some embodiments of the egg replacement formulation described herein, each of the one or more hydrocolloids is in an amount of about 0.05% to about 8%, about 0.1% to about 8%, about 0.05% to about 7%, about 0.05% to about 6%, about 0.05% to about 5%, about 0.05% to about 4%, or about 0.05% to about 3%. In certain embodiments of the egg replacement formulation described herein, each of the one or more hydrocolloids is in an amount of about 0.1% to about 2%.
In some embodiments of the egg replacement formulation described herein, the egg replacement formulation further comprises flavoring. In some embodiments the flavoring is selected from the group consisting of black salt, black pepper, Himalayan sea salt, salt, onion powder, minced onion, roasted garlic, mushroom powder, yeast extract, or a combination thereof. In some embodiments, the egg replacement formulation described herein the flavoring is black salt and onion powder.
In some embodiments of the egg replacement formulation described herein, the flavoring is in an amount of about 0.05% to about 0.5%, about 0.05% to about 0.4%, about 0.1% to about 0.5%, about 0.15% to about 0.5%, or about 0.2% to about 0.5%. In certain embodiments of the egg replacement formulation described herein, the flavoring is in an amount of about 0.25%. In certain embodiments of the egg replacement formulation described herein, the flavoring is in an amount of about 0.46%. In certain embodiments of the egg replacement formulation described herein, the flavoring is in an amount of about 0.1% to about 1%.
In some embodiments of the egg replacement formulation described herein, the egg replacement formulation further comprises water. In some embodiments of egg replacement formulation described herein, the water is in an amount of about 10% to about 50%, about 15% to about 50%, about 20% to about 50%, about 25% to about 50%, about 30% to about 50%, about 35% to about 50%, about 10% to about 45%, about 10% to about 40%, about 0.05% to about 80%, about 60% to about 85%, about 65% to about 80%, or about 70% to about 75% of the egg replacement formulation. In certain embodiments of the egg replacement formulation described herein, the water is in an amount of about 37% of the egg replacement formulation of the egg replacement formulation. In certain embodiments, the water is about 10% to about 50% of the egg replacement formulation. In certain embodiments, the water is about 50% to about 80% of the egg replacement formulation. In certain embodiments, the water is about 0.05% to about 80% of the egg replacement formulation.
Product Safety
In some embodiments, the dry egg replacement composition, egg replacement emulsion, liquid egg, liquid egg formulation, or egg replacement formulation described herein has improved product safety. In some embodiments, the improved product safety is from a reduction of microbial spoilage. In some embodiments the microbial spoilage is from bacteria, yeast, mold, or a combination thereof. In some embodiments the reduction of microbial spoilage is from pasteurization, storage pH, antimicrobial treatment, or a combination thereof.
In some embodiments, the pasteurization is carried out at a temperature of about 40° C., about 45° C., about 50° C., about 55° C., about 60° C., about 65° C., about 70° C., about 75° C., about 80° C., about 85° C., about 90° C., about 95° C., about 100° C., or a range between any two of these values.
In some embodiments, the pasteurization is carried out for about 10 min, about 15 min, about 20 min, about 25 min, about 30 min, about 35 min, about 40 min, about 45 min, about 50 min, about 55 min, about 60 min, or a range between any two of these values.
In some embodiments, the storage pH is about pH 2.5, about pH 3.0, about pH 3.5, about pH 4.0, about pH 4.5, about pH 5.0, about pH 5.5, about pH 6.0, about pH 6.5, about pH 7.0, about pH 7.5, about pH 8.0, or a range between any two of these values.
In some embodiments, the antimicrobial treatment is carried out with an antimicrobial agent.
In some embodiments, the antimicrobial agent is selected from the group consisting of nisin, calcium propionate, sodium benzoate, potassium sorbate, Bio Vontage 2662, organic acids, or a combination thereof
Vegan-Egg Scramble
Embodiments described herein are directed to methods of preparing a vegan-egg scramble comprising combining a dry egg replacement composition, an oil, and water.
In certain embodiments, the dry egg replacement composition is in an amount of about 5% to about 50%, about 10% to about 40%, about 15% to about 30%, or about 20% to about 25% in the vegan-egg scramble. In certain embodiments, the dry egg replacement composition is in an amount of about 9 g to about 15 g, about 10 g to about 14 g, about 11 g to about 13 g, or about 12 g to about 12.5 g in the vegan-egg scramble. In certain embodiments, the dry egg replacement composition is in an amount of about 12.5 g in the vegan-egg scramble.
In certain embodiments, the oil is in an amount of about 5% to about 20%, about 8% to about 18%, about 10% to about 16%, or about 14% to about 14% of the oil is used in the vegan-egg scramble. In certain embodiments, the oil is in an amount of about 1 tablespoon to about 3 tablespoons in the vegan-egg scramble. In some embodiments, the oil is in an amount of about 1 tablespoon, about 2 tablespoons, or about 3 tablespoons in the vegan-egg scramble. In some embodiments, the oil can be selected from the group consisting of vegetable oil, soybean oil, coconut oil, olive oil, peanut oil, fish oil, avocado oil, palm oil, flax oil, corn oil, cottonseed oil, canola oil, rapeseed oil, sunflower oil, safflower oil, sesame oil, grapeseed oil, safflower oil, rice bran oil, propionate, palm kernel oil,cupheaoil, camelinasativaoil, mustard seed oil, cashew nut oil, oat oil, lupine oil, kenaf oil, calendula oil, hemp oil, coffee oil, linseed oil, hazelnut oil,euphorbiaoil, pumpkin seed oil, coriander oil,camelliaoil, rice oil, tung oil tree oil, cocoa oil, copra oil, opium poppy oil, castor bean oil, pecan oil, jojoba oil, jatropha oil, macadamia oil, Brazil nut oil,Euglenaderived oil and combinations thereof.
In certain embodiments, the water is in an amount of about 60% to about 85%, about 65% to about 80%, or about 70% to about 75% in the vegan-egg scramble. In certain embodiments, the water is in an amount of about ¼ cup to about 1 cup in the vegan-egg scramble. In some embodiments, the water is in an amount of about ¼ cup, about ¼ cup, about ¼ cup, ⅔ cup, ¾ cup, or 1 cup in the vegan-egg scramble.
In certain embodiments, the egg scramble is prepared by mixing the dry egg replacement composition with about 1 tablespoon to about 3 tablespoons of oil and about ¼ cup to about 1 cup of water. The solution is mixed thoroughly by shaking or stirring and poured into a preheated frying pan. The egg scramble is cooked for about 3 minutes to about 6 minutes while being broken up with a spatula. In some embodiments, the vegan-egg scramble is cooked for about 3 minutes, about 4 minutes, about 5 minutes, or about 6 minutes.
Egg Replacement in Food Products
Embodiments described herein are directed to food products comprising the dry egg replacement composition, egg replacement emulsion, liquid egg, liquid egg formulation, or egg replacement formulation described herein in place of natural eggs.
The food products disclosed herein are illustrative examples of what can be done with the egg replacement disclosed herein and thatEuglenaegg is a functional egg substitute that can replace natural/whole eggs in all applications by incorporating anEuglenaegg substitute. In some embodiments, about 0.5 to about 1.5 dry egg replacement composition, egg replacement emulsion, liquid egg, or liquid egg formulation described herein can replace 1 natural chicken egg. In certain embodiments, about 1 dry egg replacement composition, egg replacement emulsion, liquid egg, or liquid egg formulation described herein can replace 1 natural chicken egg.
In some embodiments, an organoleptic property is attributed to the food product from the dry egg replacement composition, egg replacement emulsion, liquid egg, liquid egg formulation, or egg replacement formulation described herein, which is similar or equivalent to the organoleptic property provided by a natural egg. In some embodiments, the dry egg replacement composition, egg replacement emulsion, liquid egg, liquid egg formulation, or egg replacement formulation provides a flavor, an aroma, a sensory impression, or combinations thereof that is similar or equivalent to the flavor, aroma, or sensory impression of a reference food product.
The dry egg replacement composition, egg replacement emulsion, liquid egg, liquid egg formulation, or egg replacement formulation described herein may be incorporated into an egg scramble, an egg patty, an omelet, a quiche, frittata, egg-free cake, such as a chocolate cake, a pound cake, a yellow cake, an angel food cake, a cream cheese analog, a pasta dough, a pasta, a milk, an ice cream, a custard, a frozen dessert (e.g., a frozen dessert comprising ice cream), or a confection.
The dry egg replacement composition, egg replacement emulsion, liquid egg, liquid egg formulation, or egg replacement formulation described herein may be incorporated into meat as a meat binder/extender, i.e. it may be used to bind a grain like oats to extend ground beef in meatballs, structured meat pieces or meatloaf, or even commercial hamburgers.
The dry egg replacement composition, egg replacement emulsion, liquid egg, liquid egg formulation, or egg replacement formulation described herein may be used as a retort stabilizer in canning process for pasta and structured meat pieces in soup/Chile. It can be used in dog food to prevent break down and loss of texture during the retort cooking/canning process. Retorting is the in-container sterilization of food to render it shelf stable under normal non-refrigerated conditions (commercially sterile).
The dry egg replacement composition, egg replacement emulsion, liquid egg, liquid egg formulation, or egg replacement formulation described herein may be used to replace egg in Vegan mayonnaise as well as mayonnaise based salad dressings, also in Hollandaise sauce.
The dry egg replacement composition described herein may be used by Food service as a dry replacement for liquid egg in Omelet base, French toast coating, or any other food product utilizing dry egg.
The dry egg replacement composition, egg replacement emulsion, liquid egg, liquid egg formulation, or egg replacement formulation described herein may be used as part of a consumer “complete” Pancake and Waffle mixes, as well as in frozen pancakes and waffles commercially produced to protect the texture and freeze/thaw stability.
The dry egg replacement composition, egg replacement emulsion, liquid egg, liquid egg formulation, or egg replacement formulation described herein may be used in Yogurt and probiotic beverages.
The dry egg replacement composition, egg replacement emulsion, liquid egg, liquid egg formulation, or egg replacement formulation described herein may be used to produce non-egg “Egg crumbles” for use on salads and/or on salad bars.
The dry egg replacement composition, egg replacement emulsion, liquid egg, liquid egg formulation, or egg replacement formulation described herein may be used Vegan Christmas egg nog.
In embodiments described herein, the dry egg replacement composition, egg replacement emulsion, liquid egg, liquid egg formulation, or egg replacement formulation described herein has provided one or more functional properties to the food product when incorporated therein. The functional properties when incorporated into a food application are selected from the group consisting of crumb density, structure/texture, elasticity, springiness, coagulation, binding, moisturizing, mouthfeel, leavening, aeration/foaming, creaminess, and emulsification of the food product such as an egg.
Mouthfeel is a concept used in the testing and description of food products. Products made using the dry egg replacement composition, the egg replacement emulsion, liquid egg, or liquid egg formulation described herein can be assessed for mouthfeel. In some embodiments products, e.g., baked goods, made using dry egg replacement composition, the egg replacement emulsion, liquid egg, or liquid egg formulation described herein have mouthfeel that is similar to products made with natural eggs. In some embodiments the mouthfeel of the products made using the dry egg replacement composition, the egg replacement emulsion, liquid egg, or liquid egg formulation described herein is superior to the mouthfeel of previously known or attempted egg substitutes, e.g., bananas, modified whey proteins, or Egg Beaters™. Examples of properties which may be included in a measure of mouthfeel include:
- Cohesiveness: Degree to which the sample deforms before rupturing when biting with molars;
- Density: Compactness of cross section of the sample after biting completely through with the molars;
- Dryness: Degree to which the sample feels dry in the mouth;
- Fracturability: Force with which the sample crumbles, cracks or shatters.
- Fracturability encompasses crumbliness, crispiness, crunchiness and brittleness;
- Graininess: Degree to which a sample contains small grainy particles, may be seen as the opposite of smoothness;
- Gumminess: Energy required to disintegrate a semi-solid food to a state ready for swallowing;
- Hardness: Force required to deform the product to given distance, i.e., force to compress between molars, bite through with incisors, compress between tongue and palate;
- Heaviness: Weight of product perceived when first placed on tongue;
- Moisture absorption: Amount of saliva absorbed by product; Moisture release: Amount of wetness/juiciness released from sample;
- Mouthcoating: Type and degree of coating in the mouth after mastication (for example, fat/oil);
- Roughness: Degree of abrasiveness of product's surface perceived by the tongue;
- Slipperiness: Degree to which the product slides over the tongue;
- Smoothness: Absence of any particles, lumps, bumps, etc., in the product;
- Uniformity: Degree to which the sample is even throughout; homogeneity; Uniformity of
- Bite: Evenness of force through bite;
- Uniformity of Chew: Degree to which the chewing characteristics of the product are even throughout mastication;
- Viscosity: Force required to draw a liquid from a spoon over the tongue; and
- Wetness: Amount of moisture perceived on product's surface.
Baked Cakes: In another aspect, provided herein are one or more egg-free cake mixes, suitable for preparing one or more egg-free cake batters, from which one or more egg-free cakes can be made. In some embodiments, the egg-free cake mix comprises flour, sugar, and the dry egg replacement composition, the egg replacement emulsion, liquid egg, or liquid egg formulation described herein. In some embodiments, the egg-free cake mix further comprises one or more additional components selected from: cream of tartar, disodium phosphate, baking soda, and a pH stabilizing agent. In some embodiments, the flour comprises cake flour. Also provided herein is an egg-free cake batter comprising an egg-free cake mix described above, and water. In some embodiments, the egg-free cake batter is an egg-free pound cake batter, an egg-free angel food cake batter, or an egg-free yellow cake batter. In some embodiments, the egg-free cake batter has a specific gravity of 0.95-0.99. In some embodiments, a peak height of the egg-free cake is at least 90% of a peak height of a pound cake containing eggs. In some embodiments, one or more characteristics of the egg-free cake is similar or equivalent to one or more corresponding characteristics of a cake containing eggs. In some embodiments, the one or more characteristics comprise resilience, cohesiveness, springiness, peak height, center doming, center crack, browning, mouthfeel, spring-back, or flavor. In some embodiments, the one or more characteristics comprise hardness, resilience, cohesiveness, springiness, or chewiness. In some embodiments, the one or more characteristics comprise a functional property or an organoleptic property. In some embodiments, the functional property comprises one or more of: emulsification, water binding capacity, foaming, gelation, crumb density, structure forming, texture building, cohesion, adhesion, elasticity, springiness, solubility, viscosity, fat absorption, flavor binding, coagulation, leavening, aeration, creaminess, film forming property, sheen addition, shine addition, freeze stability, thaw stability, or color.
In a particular embodiment, provided herein is an egg-free pound cake mix, comprising flour, sugar, and the dry egg replacement composition, the egg replacement emulsion, liquid egg, or liquid egg formulation described herein. In some embodiments, the flour comprises cake flour. In some embodiments, the egg-free pound cake mix further comprises oil or fat. In some embodiments, the oil or fat comprises butter or shortening. In some embodiments, at least or about 25-31% of the egg-free pound cake batter is flour. In some embodiments, at least or about 25-31% of the egg-free pound cake batter is oil or fat. In some embodiments, at least or about 25-31% of the egg-free pound cake batter is sugar. In some embodiments, at least or about 6-12% of the egg-free pound cake batter is the dry egg replacement composition, the egg replacement emulsion, liquid egg, or liquid egg formulation described herein. In some embodiments, the batter further comprises disodium phosphate or baking soda.
Also provided herein is an egg-free pound cake batter comprising an egg-free pound cake mix described above, and further comprising water. In some embodiments, the egg-free pound cake batter comprises about four parts of the egg-free pound cake mix; and about one part water. In some embodiments, at least or about 20-25% of the egg-free pound cake batter is flour. In some embodiments, at least or about 20-25% of the egg-free pound cake batter is oil or fat. In some embodiments, at least or about 20-25% of the egg-free pound cake batter is sugar. In some embodiments, at least or about 5-8% of the egg-free pound cake batter is the dry egg replacement composition, the egg replacement emulsion, liquid egg, or liquid egg formulation described herein. In some embodiments, at least or about 18-20% of the egg-free pound cake batter is water.
In another particular embodiment, provided herein is an egg-free angel food cake mix comprising flour, sugar, and the dry egg replacement composition, the egg replacement emulsion, liquid egg, or liquid egg formulation described herein. In some embodiments, at least or about 8-16% of the egg-free angel food cake mix is flour. In some embodiments, at least or about 29-42% of the egg-free angel food cake mix is sugar. In some embodiments, at least or about 7-10% of the egg-free angel food cake mix is the dry egg replacement composition, the egg replacement emulsion, liquid egg, or liquid egg formulation described herein. In some embodiments, the egg-free angel food cake mix further comprises cream of tartar, disodium phosphate, baking soda, or a pH stabilizing agent. In some embodiments, the flour comprises cake flour. Also provided herein is an egg-free angel food cake batter comprising an egg-free angel food cake mix described above, and water.
In another particular embodiment, provided herein is an egg-free yellow cake mix, comprising flour, sugar, and the dry egg replacement composition, the egg replacement emulsion, liquid egg, or liquid egg formulation described herein. In some embodiments, at least or about 20-33% of the egg-free yellow cake mix is flour. In some embodiments, at least or about 19-39% of the egg-free yellow cake mix is sugar. In some embodiments, at least or about 4-7% of the egg-free yellow cake mix is the dry egg replacement composition, the egg replacement emulsion, liquid egg, or liquid egg formulation described herein. In some embodiments, the egg-free yellow cake mix further comprises one or more of baking powder, salt, dry milk, and shortening. Also provided herein is an egg-free yellow cake batter comprising an egg-free yellow cake mix described above, and water.
Some embodiments provide methods to produce an egg-free pound cake using a dry egg replacement composition, the egg replacement emulsion, liquid egg, or liquid egg formulation described herein. For instance, a batter is created by mixing liquid solution comprising the dry egg replacement composition, the egg replacement emulsion, liquid egg, or liquid egg formulation described herein with sugar, cake flour, and butter at 17° C. to 20° C. in 1:1:1:1 w/w ratio. The ingredients are blended together using single stage mixing on mixer for 6 minutes at 22° C. The batter is baked in pound cake pan for 45 minutes in 150° C. and cooled in pan for 2 hours at 22° C. Sensory quality parameters of cakes made with the dry egg replacement composition, the egg replacement emulsion, liquid egg, or liquid egg formulation described herein are characterized as fluffy, soft, airy texture. The peak height was measured to be 90-110% of pound cake containing eggs.
Cream Cheese Analog: In another aspect, provided herein is an egg-free cream cheese comprising the dry egg replacement composition, the egg replacement emulsion, liquid egg, or liquid egg formulation described herein. In some embodiments, the egg-free cream cheese comprises one or more additional components selected from water, oil or fat, and hydrocolloid. In some embodiments, at least or about 75-85% of the egg-free cream cheese is water. In some embodiments, at least or about 10-15% of the egg-free cream cheese is the dry egg replacement composition, the egg replacement emulsion, liquid egg, or liquid egg formulation described herein. In some embodiments, at least or about 5-10% of the egg-free cream cheese is oil or fat. In some embodiments, at least or about 0.1-3% of the egg-free cream cheese is hydrocolloid. In some embodiments, the hydrocolloid comprises xanthan gum or a low-methoxy pectin and calcium chloride system. In some embodiments, the egg-free cream cheese further comprises a flavoring or salt. In some embodiments, one or more characteristics of the egg-free cream cheese is similar or equivalent to one or more corresponding characteristics of a cream cheese containing eggs. In some embodiments, the characteristic is a taste, a viscosity, a creaminess, a consistency, a smell, a spreadability, a color, a thermal stability, or a melting property. In some embodiments, the characteristic comprises a functional property or an organoleptic property. In some embodiments, the functional property comprises: emulsification, water binding capacity, foaming, gelation, crumb density, structure forming, texture building, cohesion, adhesion, elasticity, springiness, solubility, viscosity, fat absorption, flavor binding, coagulation, leavening, aeration, creaminess, film forming property, sheen addition, shine addition, freeze stability, thaw stability, or color. In some embodiments, the organoleptic property comprises a flavor or an odor.
Egg-free pasta dough: In another aspect, provided herein is an egg-free pasta dough comprising the dry egg replacement composition, the egg replacement emulsion, liquid egg, or liquid egg formulation described herein. In some embodiments, the egg-free pasta dough comprises one or more additional components selected from flour, oil or fat, and water. In some embodiments, the flour comprises semolina flour. In some embodiments, the oil or fat comprises extra virgin oil. In some embodiments, the egg-free pasta dough further comprises salt. Also provided herein is an egg-free pasta made from an egg-free pasta dough described above. In some embodiments, the egg-free pasta is fresh. In some embodiments, the egg-free pasta is dried. In some embodiments, one or more characteristics of the egg-free pasta is similar or equivalent to one or more corresponding characteristics of a pasta containing eggs. In some embodiments, the one or more characteristics comprise chewiness, density, taste, cooking time, shelf life, cohesiveness, or stickiness. In some embodiments, the one or more characteristics comprise a functional property or an organoleptic property. In some embodiments, the functional property comprises: emulsification, water binding capacity, foaming, gelation, crumb density, structure forming, texture building, cohesion, adhesion, elasticity, springiness, solubility, viscosity, fat absorption, flavor binding, coagulation, leavening, aeration, creaminess, film forming property, sheen addition, shine addition, freeze stability, thaw stability, or color. In some embodiments, the organoleptic property comprises a flavor or an odor.
Egg-free custard: In another aspect, provided herein is an egg-free custard comprising the dry egg replacement composition, the egg replacement emulsion, liquid egg, or liquid egg formulation described herein. In some embodiments, the egg-free custard comprises one or more additional components selected from cream and sugar. In some embodiments, at least or about 5% of the egg-free custard is the dry egg replacement composition, the egg replacement emulsion, liquid egg, or liquid egg formulation described herein. In some embodiments, at least or about 81% of the egg-free custard is cream. In some embodiments, at least or about 13% of the egg-free custard is sugar. In some embodiments, the egg-free custard further comprises one or more of: iota-carrageenan, kappa-carrageenan, vanilla, and salt. In some embodiments, the cream is heavy cream.
Egg-free ice cream: In another aspect, provided herein is an egg-free ice cream comprising the dry egg replacement composition, the egg replacement emulsion, liquid egg, or liquid egg formulation described herein. In some embodiments, the egg-free ice cream is a soft-serve ice cream or a regular ice cream. In some embodiments, the egg-free ice cream comprises one or more additional components selected from cream, milk, and sugar. In some embodiments, at least or about 5% of the egg-free ice cream is the dry egg replacement composition, the egg replacement emulsion, liquid egg, or liquid egg formulation described herein. In some embodiments, at least or about 41% of the egg-free ice cream is cream. In some embodiments, at least or about 40% of the egg-free ice cream is milk. In some embodiments, at least or about 13% of the egg-free ice cream is sugar. In some embodiments, the egg-free ice cream further comprises one or more of iota carrageenan, kappa carrageenan, vanilla, and salt. In some embodiments, the cream is heavy cream. In some embodiments, the milk is whole milk. In particular embodiments, the egg-free ice cream is lactose-free. In other particular embodiments, the egg-free ice cream does not comprise gums or stabilizers. In other embodiments, the egg-free ice provides a traditional mouthfeel and texture of an egg-based ice cream but melts at a slower rate relative to an egg-based ice cream.
In the market, there are 2 different egg replacement products strategies one is targeted for bakery applications. In that application, the main ingredients are starches and gums (used as binders and texturizers) accompanied by leavening agents to make up for egg white's leavening functionality in baking applications, along with some protein.
The other application for an egg replacer is a powder or liquid egg replacer that can scramble, for use as scrambled eggs, frittatas, or omelets. For the scramble egg replacer, the main ingredients will include a plant protein (for mimicking the nutrition of the real egg), and a mixture of different gums/hydrocolloids as binder and texture developers upon cooking.
In this study, a combination of pea protein concentrate andEuglenaprotein flour was used as the main protein source. Beta-glucan ready to gel (RTG) powder was used as the sole hydrocolloid source to act as a binder/texturizer. Beta-glucan RTG powder is solubilized beta-glucan in 1 M NaOH, that has been formed into a gel with 3.75% citric acid, and then freeze dried to form a powder. When the powder is put back into water, it readily forms a thickened solution or gel, depending on the concentration. The addition of beta-glucan isolate in combination with theEuglenaprotein flour gives the egg scramble the expected yellow colour of a scrambled egg, meaning that a coloring agent is not needed in these applications. In addition, the addition of the beta-glucan isolate also showed a masking effect on theEuglenaprotein flour off-notes compared to control mixture without the beta-glucan isolate. TheEuglenaflour is yellow which also adds to the expected yellow colour of scrambled eggs.
No flavoring agent or flavor masker has been used in this formulation and still panelists could perceive an umami-like taste which would be attributed to the protein sources (combination ofEuglenaflour and pea protein).
Methods and Materials: The formulation that was used in this study for an egg scramble is written in Table 1 which included theEuglenaprotein flour at approximately 30% protein in the flour, beta-glucan isolate fromEuglena, as well as ready to gel beta-glucan powder to act as the hydrocolloid source. The dry ingredients are mixed together, then water is added and mixed. The mixture is whisked for 1 minute. To test the scramble like properties, the whisked mixture is poured into a frying pan that has been set to medium heat (approximately 170° C.) and with 1 tablespoon of warmed oil (i.e. vegetable, 1 tablespoon per 100 grams of liquid egg replacer). The whisked mixture is fried for about 7 to 9 minutes with a scrambling action every minute to two minutes to obtain a scrambled egg consistency. The mixture was analyzed by an internal taste panel.
| TABLE 1 |
| Formulation of egg (scramble) replacer |
| % (Wet | % (Dry | |||
| Egg Replacer Formulation | basis) | basis) | ||
| Water | 87.8 | 0.0 | ||
| Euglena Protein Flour* | 4.0 | 32.8 | ||
| Pea Protein Concentrate (80% | 3.0 | 24.6 | ||
| protein content) | ||||
| Beta-glucan isolate powder | 1.0 | 8.2 | ||
| Ready to gel beta-glucan powder | 4.0 | 32.8 | ||
| Salt | 0.2 | 1.6 | ||
| Total | 100.0 | |||
| % Total Solid | 12.2 | |||
| *Euglena protein Flour Spec: Protein: 35.63% Oil: 13.4% Carbs: 38.69% | ||||
Results and Discussion: TheEuglenabased liquid scramble egg replacer had a yellow colour (FIG.1 ). In this case, no flavouring agent or other known flavour masker was added in this formulation. As such in this formulation, the taste panelist could detect an umami-like taste which is due to the protein sources of theEuglenaprotein flour and the pea protein. Onion powder or salt, garlic powder or salt, and/or nutritional yeast powder could be a flavouring agent added to improve the taste of theEuglenaliquid egg replacer.
For an improvement in taste the formulation of Table 2 was developed, which includes onion powder as well as salt.
| TABLE 2 |
| Taste improvement Formulation |
| % (Wet | |||
| Ingredients | basis/As is) | ||
| Water | 83.00 | ||
| Euglena Flour * | 7.00 | ||
| Puris Pea Protein (P870-80% Protein) | 9.50 | ||
| Salt | 0.10 | ||
| Gellan Gum Powder | 0.10 | ||
| Onion powder | 0.30 | ||
| Total | 100.00 | ||
| Total Solid | 17.00 | ||
| *Euglena Flour Spec | |||
| Protein | 36.70 | ||
| Oil | 7.00 | ||
| Carb | 40.90 | ||
In this study, the effect of gellan gum as a hydrocolloid texturizer/binder, onion powder as a flavouring agent, and a higher protein enrichedEuglenaflour was investigated.
Materials and Methods:Euglenaliquid egg replacer is seen in Table 3. For theEuglenaprotein flour, a flour with 37% protein and 48% protein was investigated to determine the effects of higher protein inclusion flour. In this formulation, no beta-glucan isolate as a masker/whitening agent was used. As well, no RTG beta-glucan powder was used as a hydrocolloid. Instead, the hydrocolloid gellan gum was added. A flavouring agent of onion powder is also added to improve taste of the final product.
To form the mixture, all dry ingredients were mixed, including the gellan gum followed by water addition and mixing. The mixture was heated to 80° C. for 1 hour, up to 2 hours for the gellan gum to hydrate and gel. The mixture is poured into a frying pan that has been set to medium heat (approximately 170° C.) with 1 tablespoon of warmed oil (i.e. vegetable, 1 tablespoon per 100 grams of liquid egg replacer). The mixture is fried for about 7 to 9 minutes with a scrambling action every minute to two minutes to obtain a scrambled egg consistency. The mixture was analyzed by an internal taste panel. The experiment was repeated again to confirm results.
| TABLE 3 |
| Ingredient list ofEuglena liquid egg replacer. |
| Ingredients | % (Wet basis) | ||
| Water | 85.42 | ||
| Euglena Protein Flour (37% or 48%) | 8.00 | ||
| Pea Protein Concentrate (80%) | 6.00 | ||
| Salt | 0.10 | ||
| Gellan Gum Powder | 0.18 | ||
| Onion Powder | 0.30 | ||
| Total | 100.00 | ||
Results and discussion: While after 1 hour heat treatment of the lowerEuglenaprotein flour egg prototype (37% protein content), the presence of the gellan gum creates a thickened gel like consistency that resembles liquid egg and helps with the desired texture of scrambled egg upon cooking. In the prototype with higherEuglenaprotein content (47%) under the same heat treatment condition for 1 hour and even after about 2 hours, the expected gel-like thickened consistency was not obtained and the mixture was almost at the same consistency as before heat treatment or just subtly thicker, too thin and watery for cooking. This effect was observed in both replicates of the experiment.
Conclusion: Without wishing to be bound by theory, the result observed herein utilized a higher concentration of protein in the flour, accordingly the interaction between the protein and gellan gum prevented the gum from hydrating. This means the protein-gum interaction prevented the water-gum interaction from forming, preventing the hydration of the gum and its thickening/gelling effect in the matrix.
In an attempt to remedy the defects of the previous formulation, the ratio of pea protein toEuglena-derived protein was modified, see Table 4.
| TABLE 4 |
| Formulation containing greater ratio of pea toEuglena- |
| derived protein |
| Ingredient | ||||
| Ingredient Name | Grams | % | ||
| Pea Protein (Puris P870) | 12.00 | 48.98 | ||
| Euglena Protein Flour | 8.00 | 32.65 | ||
| Gellan Gum(Gellan HS) Lot: 35863 | 0.80 | 3.27 | ||
| Methylcellulose (HV Powder) | 1.25 | 5.10 | ||
| Sea Salt | 0.35 | 1.43 | ||
| Onion Powder (Organic) | 0.20 | 0.82 | ||
| Fona Egg Type Flavor, Nat 943.0135U | 1.00 | 4.08 | ||
| (Lot#S1124684) | ||||
| Fona Egg Type Flavor, Nat 943.0136U | 0.50 | 2.04 | ||
| (Lot#S1924685) | ||||
| Brewers nutritional yeast | 0.20 | 0.82 | ||
| Dadex LTR-DRY NGM | 0.20 | 0.82 | ||
| Total | 24.50 | 100.00 | ||
If achieve a more pleasant aroma, sea salt was replaced with black salt according to Table 5, and a vegan egg scramble with black salt is show inFIG.2 .
| TABLE 5 |
| Improved Aroma Formula |
| Ingredient | Target bottle | ||
| Ingredient Name | Grams | % | formula 25 gr. |
| Pea Protein (Puris P870) | 12.00 | 52.17 | 13.043 |
| Euglena Protein Flour | 8.00 | 34.78 | 8.696 |
| Ticagel Gellan HS: Gellan | 0.80 | 3.48 | 0.870 |
| Gum (Lot: 44186) | |||
| TICACEL HV Powder: | 1.25 | 5.43 | 1.359 |
| Methylcellulose | |||
| (Lot#38149) | |||
| Black salt | 0.35 | 1.52 | 0.380 |
| P512 yeast extract | 0.20 | 0.87 | 0.217 |
| Onion Powder (Organic) | 0.20 | 0.87 | 0.217 |
| Antioxidant | 0.20 | 0.87 | 0.217 |
| Dadex ® LTR Dry NGM | |||
| Total | 23.00 | 100.00 | 25.000 |
Studies were performed to develop an egg substitute which would provide greater than 6 g protein, a PDCAAS of 1, a natural yellow color, a consistency and texture that could be easily used by the consumer as an egg scramble or added to recipes to replace eggs. The hurdles to overcome through these studies included the amount of total protein in the composition, low viscosity upon addition of water, the flavor was not neutral, and the color was too dark.
During the process of finalizing the current recipe numerous ingredients have been adjusted; flour combination/ratios, gums used and quantities, flavour profiles, and different salt used.
The quantities of flour; both pea protein and protein-richEuglenaflour have been adjusted. The current formula contains a 60:40 ratio of pea toEuglenaflour blend. Other ratios have been experimented with; 70:30, 65:35. Only to find that the undesirable notes of the pea protein start to show through; most notably a powdery mouthfeel and pea protein flavour notes. Over the last 5 months we had been using the protein rich flour and using it as the primary flour to formulate with. However, during the last round of sensory testing it was found to have gone rancid and new protein rich flour was used to replace it. The new flours are processed differently and have a different flavour profile, most notable it is lighter on theEuglenaoff notes making it an ideal candidate for the vegan egg.
During the different trials for the vegan egg/egg replacement different gums were explored and tested to try and get the right egg like texture.
Gums used: 1) Konjac—derived from the konjac root. Which in nature forms one of the strongest gels. 2) Konjac+Xanthan gum: Known to work synergistically together. 3) Locus bean gum+Xanthan gum: works well together to produce good mouth feel. However, the strength of the gel in the vegan egg/egg replacement application did not work because of the thermal reversibility. 4) Xanthan gum: in order to utilize Xanthan gum it must be properly hydrated. Usage within the powdered vegan egg/egg replacement does not allow for such hydration. 5) Gellan gum HA: Forms soft elastic and non brittle gel that are thermal stable. 6) Methylcellulose gum: Is widely used in vegetarian products to give form to plant based proteins. And gels at a high temperature to an egg like texture but the thermal reversibility causes it to revert back to a weak gel. It works well in conjunction with gellan gum in keeping the desired egg like texture. During the gum experiments it was found that the combination between Methylcellulose gum and gellan gum not only combated the reversibility of the methylcellulose gum as it began to cool but worked with it to add a springy egg like quality.
Flavours: During the first trial run at the formula used (Table 4 above) egg type flavourings from Fona, sea salt and brewers yeast. The Brewers Yeast was a last minute substitution added in replace of the P512 yeast because of shipping issues. The brewers yeast substitution removed the umami flavour of the P512 changing the flavour profile. It was found that the combination of the egg type flavours in conjunction with the sea salt created very unpleasant odors during the cooking process. With testing and substitution it was decided to omit the Fona flavours and salt, and formulate to one of the original prototypes with black salt and yeast extract (Table 5 above). The removal of the Fona egg type flavours were substituted with Black salt because of the sulphuric quality reminiscent of egg. It is used in many vegan egg like recipes to mimic the aroma and flavor of egg.
Conclusion: After several different testing with the base formula it was ultimately decided to go with the current formula (Table 6 below) for a few reasons. Omitting the Fona egg type flavours reduced the off cooking aromas as well as reduced the ingredients within the formula creating a “cleaner” label. The addition of black salt mimics the egg like flavour. The decision to use the yeast extract P512 instead of the brewers nutritional yeast is mainly for the unique umami flavour. The brewers yeast did have a neutral flavour it did not lend itself to the unique flavouring of the vegan egg/egg replacement to help set it apart from the competitors.
The texture of the vegan egg/egg replacement plays one of the most important roles in creating the egg like texture. This texture is in large due to the combination of gums used. Methylcellulose gum is derived from cellulose and is therefore a renewable resource and has a long standing reputation of being safe to use. Gellan gum works synergistically with methylcellulose gum to prevent the melting of the gel when it begins to cool.
Future efforts will focus on masking any algae off notes and optimizing the egg like flavour. Possible masking applications would be spray drying maskers directly onto theEuglenabiomass flour. This may also help for future applications of the egg to be used in not only savoury applications but also sweet baking goods.
Will start with a deconstructed egg, reducing it to the bare basic ingredients of flours and gels then adding one flavour at a time to thoroughly explore the importance of each flavour and optimize the inclusion. This could also create a more neutral “egg” which could be used in a wide variety of applications. Or creating a savoury or sweet specific “egg” for the particular needs of each application.
Texture, current formulation is good, could be improved and perhaps incorporate more natural sounding and easy to pronounce gels to appease the consumers desire for clean label foods. For Instance Konjac gel is derived from the konjac root and forms one of the strongest gels from a naturally derived plant. And work towards reducing the percent inclusion of the gels added to the egg without compromising texture.
WhileEuglenaprotein provides strong gelation and functional properties, the formulation of Table 6 utilizes a blend of pea protein isolate (>75% protein), protein richEuglenaflour, in combination with methycellulose and gellan gum that are heat activated at cook temperature. The combination of hydrocolliods, i.e. methycellulose and gellan gum, along with optimized ratio of pea protein/Euglenaflour provides a viscosity of rehydrated vegan egg batter that is comparable to liquid eggs. Heat activation of functional hydrocolloids with optimized moisture/lipid ratio facilitates shortened cook time while delivery vegan egg texture similar to scrambled egg prepared from liquid chicken whole egg. Natural Yellow/orange color ofEuglenaeliminates the need of any added color. This composition also uses black salt, onion, yeast extract to help deliver sulfur and umami notes associated with liquid scrambled egg while providing consumer an option to using their oil of choice when rehydrating the dry mixture.
The ratio ofEuglenaprotein and pea protein resulted in greater than 6 g/50 g of an equivalent egg serving, this ratio also provided a natural yellow egg color. The combination of methylcellulose and gellan gum improved the texture and reduced the cook time to about 4-5 minutes when used as an egg scramble. The final combination of ingredients resulted in the optimal viscosity upon hydration of the dry egg substitute. The use of black salt, onion powder, yeast extract improved the egg flavor. SeeFIG.3 .
The final composition is provided in Table 6.
| TABLE 6 |
| Egg Replacement Composition |
| Ingredient | Grams | % wt | ||
| Pea Protein | 84.00 | 52.18% | ||
| Euglena Protein Flour | 56.00 | 34.78% | ||
| Gellan gum | 5.60 | 3.48% | ||
| Methylcellulose | 8.75 | 5.43% | ||
| Black salt | 2.45 | 1.52% | ||
| Onion powder | 1.40 | 0.87% | ||
| Yeast extract | 1.40 | 0.87% | ||
| Dadex ® LTR Dry NGM or | 1.40 | 0.87% | ||
| antioxidant blend | ||||
| Total | 161.00 | 100.00% | ||
The preparation of an egg scramble utilizing the describe egg replacement includes mixing the dry ingredients described in Table 3 with 1 tablespoon of vegetable oil and % a cup of water. Shake well and pour into a preheated frying pan. Cook for 4 minutes, breaking up the mixture with a spatula.
The following is an example of the egg replacer as a scramble. Table 7 below shows amounts and ingredients used in the Spinach and Sun-Dried Tomato Scramble:
| TABLE 7 |
| Ingredients for Spinach and Sun-Dried Tomato Scramble |
| with egg replacer (“The Egg”) |
| Ingredient: | Amount: | ||
| 1 cup | |||
| Garlic, | 1 clove | ||
| Onion, | 2 tbsp | ||
| Sun-dried tomatoes, minced | 1 tbsp | ||
| egg replacer (“The Egg”), unprepared | 2 scoops/1 bottle | ||
Directions: HEAT a drizzle of oil in a small skillet over medium heat. Stir in onion, cook until softened, about 2-3 minutes. Add spinach to skillet and cook for 2-3 minutes, or until spinach has wilted and liquid has evaporated. Stir in garlic and sun-dried tomatoes, cook for 1 minute. Remove mixture to a paper towel lined plate and wipe pan clean.
WHISK (or prepare in bottle) egg replacer (“The Egg”) with 140 ml of water and 1 tbsp of oil in a medium bowl until smooth. Increase skillet heat to medium-high, and drizzle in 1 tsp of oil.
POUR egg replacer (“The Egg”) into preheated skillet and cook, without stirring, for 45 seconds. Continue to cook egg replacer (“The Egg”) for 4-5 minutes, using a rubber spatula to push egg around the pan. Add spinach mixture back to pan and cook for 1 minute or until heated through.
ENJOY as is, or in a wrap or on a slice of your favorite toasted bread. For a Mediterranean twist add a little feta to the scramble. Just crumble in 2 tbsps of feta over egg replacer (“The Egg”) during the last minute of cooking. Placing the cooked spinach mixture on a paper towel lined plate will soak up any extra liquid from the spinach, keeping your scramble light and fluffy.
The following is an example of the egg replacer in a pancake. Table 8 below shows amounts and ingredients used in the Fluffy Oatmeal Cinnamon Pancakes:
| TABLE 8 |
| Ingredients for Fluffy Oatmeal Cinnamon Pancakes with egg |
| replacer (“The Egg”) |
| Ingredient: | Amount: | ||
| Old fashioned rolled | 1 | cup | ||
| All-purpose flour, or gluten free baking flour | ¾ | |||
| Baking Powder | ||||
| 1 | ||||
| Ground Cinnamon | ||||
| 1 | tsp | |||
| Cold milk or | 1 | cup | ||
| egg replacer (“The Egg”), unprepared | 2 | scoops/ | ||
| Cider Vinegar | ||||
| 1 | tsp | |||
| Maple syrup, or favorite | 1 | tbsp | ||
| Melted butter, or | 1 | |||
| Vanilla Extract | ||||
| 1 | tsp | |||
Directions: COMBINE oats, flour, baking powder and cinnamon in a large bowl and mix well. WHISK together milk, egg replacer (“The Egg”) and vinegar in a medium bowl, let stand for 5 minutes. Add melted butter, maple syrup, and vanilla to the bowl with the milk and whisk until smooth. WHISK wet ingredients into the bowl with the dry ingredients until batter is smooth and lump free.
HEAT and grease a large skillet over medium heat. Pour about ¼ cup of pancake batter into skillet, gently press batter into a 4 inch circle. Cook for 1 to 2 minutes or until slightly dry around the sides and little bubbles appear, flip and continue cooking until both sides are lightly golden. Repeat with remaining batter, adding additional butter or oil in between batches as needed. SERVE pancakes with extra maple syrup and fresh berries.
The following is an example of the egg replacer as used in a layered casserole dish. Table 9 below shows amounts and ingredients used in the Caramelized Onion and Mushroom Strata:
| TABLE 9 |
| Ingredients for Caramelized Onion and Mushroom Strata |
| with egg replacer (“The Egg”) |
| Ingredient: | Amount: |
| l inch, cubed, day old sourdough bread | 10 | cups |
| Grated old cheddar cheese (optional) | 1 | cup |
| Spanish onion, finely sliced | 1 |
| Sliced, mixed mushrooms (portabella, | 4 | cups |
| cremini, shitaki) |
| Rosemary, minced | 1 | tsp |
| Thyme, minced | 1 | tsp |
| Cloves of garlic, minced | 2 |
| Whole Milk (3.25% fat) | 1½ | |
| Dijon Mustard | ||
| 2 | tsp |
| egg replacer (“The Egg”) (unprepared) | 6 scoops/3 bottles |
Directions: PREHEAT your oven to 375° F. and grease a 9×13 baking dish. Place bread and cheese in a large bowl.HEAT 1 tbsp of oil in a large skillet over medium-low heat. Add onions to skillet and cook, stirring occasionally for 30 minutes, or until onions are tender and golden.
DRIZZLE a small amount of oil into the pan with the onions and increase the skillet heat to medium-high. Stir in mushrooms, rosemary and thyme, season with salt and pepper. Cook for 8 to 10 minutes, stirring occasionally, until golden and tender. Add garlic to skillet and cook for 1 minute. Transfer mixture to the bowl with the bread.
WHISK together milk. mustard, The Egg and ⅓ cup of cold water in a medium bowl until smooth. FOLD the wet ingredients into the bowl with the bread and mushroom mixture, mix until all the liquid is absorbed. Transfer to prepared baking dish and cover with aluminum foil.
PLACE strata in preheated oven and bake for 30 minutes. Remove foil and continue to bake for an additional 20 minutes, or until strata is firm and golden. REST strata for 10 minutes then serve with a side salad or fresh fruit. Make it vegan by using an unsweetened non dairy creamer and omitting the cheese.
The following is an example of the egg replacer as used in a baked cake. Table 10 below shows amounts and ingredients used in the Vegan Chocolate Cake with Berry Filling and Chocolate Ganache:
| TABLE 10 |
| Ingredients for Vegan Chocolate Cake with Berry Filling |
| and Chocolate Ganache with egg replacer (“The Egg”) |
| Ingredient: | Amount: | ||
| FOR THE CAKE: | |||
| 2 | cups | ||
| All purpose flour | 1¾ | cups | |
| 1 | |||
| Baking soda | |||
| 2 | |||
| Baking Powder | |||
| 1 | tsp | ||
| Salt | ½ | tsp | |
| Milk, | 1 | cup | |
| Vegetable Oil | ½ | cup |
| egg replacer (“The Egg”), unprepared | 2 scoops/1 bottle |
| 2 | tsp | |||
| Strong hot coffee, or | 1 | cup | ||
| FOR THE BERRY COMPOTE: | ||||
| Mixed berries, fresh or frozen | 2½ | cups | ||
| Sugar | ½ | |||
| Fresh Lemon | ||||
| 1 | ||||
| Lemon Zest | ||||
| 1 | tsp | |||
| FOR THE CHOCOLATE GANACHE | ||||
| Vegan dark chocolate, roughly chopped | 12 | oz | ||
| Coconut Cream | ½ | cup | ||
Directions for the Cake: PREHEAT your oven to 350° F. Grease and line two 8 inch round cake pans with parchment paper. PLACE sugar in a large bowl, sift in flour, cocoa powder, baking soda, baking powder and salt, whisk until combined. WHISK together the milk, oil, The Egg and vanilla in a medium bowl until smooth. ADD wet ingredients to dry ingredients. Beat with a hand mixer until combined. Slowly add the coffee to the batter and beat on low speed, scraping down sides of bowl, until smooth. The stronger the coffee, the stronger the chocolate flavour. Divide batter evenly between prepared cake pans. TRANSFER to the preheated oven. Bake for 30 to 35 minutes or until an inserted toothpick comes out with little crumbs on it. COOL cake for 10 minutes, then gently run a knife around cake edges and invert onto a cooling rack, cool completely.
Directions for the Berry Compote: BRING berries and sugar to a boil in a small pot over medium high heat. Once boiling reduce the heat to medium and simmer for 15 to 20 minutes or until thickened. Remove from heat and transfer to a bowl. Stir in the lemon juice and zest, cool completely
Directions for the Chocolate Ganache: MELT the chocolate in a double boiler or in a heatproof bowl set over a pot of barely simmering water, stirring occasionally. Once the chocolate is melted whisk in the coconut cream until combined. REMOVE from heat and allow to cool to an icing like consistency.
Directions to finish the cake: PLACE a cake round on a cake decorating wheel or serving plate. Mix together 1 cup of ganache with the cooled berry compote. Spread evenly over the top of the first cake round. Top with remaining cake round. DOLLOP ganache on top of the cake. Gently spread it evenly around the top and sides of the cake. Smooth with an offset spatula. GARNISH with fresh berries and mint.
The following is an example of the egg replacer as used in a breakfast burrito. Table 11 below shows amounts and ingredients used in the Breakfast Burritos with Avocado Pico de Gallo.
| TABLE 11 |
| Ingredients for Breakfast Burritos with Avocado Pico de |
| Gallo with egg replacer (“The Egg”) |
| Ingredient: | Amount: | ||
| BREAKFAST BURRITO: | |||
| Red bell pepper, chopped | ¼ | cup | |
| Red onion, chopped | 2 | ||
| Baby Spinach | |||
| 1 | cup | ||
| Tex- | 1 | tsp |
| egg replacer (“The Egg”), unprepared | 4 scoops/2 bottles |
| Black beans, drained and rinsed | ¼ | cup |
| 10 inch | 2 |
| Shredded cheddar cheese (Optional) | ¼ | cup | |
| AVACADO PICO de Gallo: |
| Plum Tomatoes, seeded and diced | 1 | |
| Avocado | ½ |
| Cilantro, chopped | 1 | tbsp | |
| Red onion, minced | 1 | tbsp |
| Clove of garlic, minced | 1 |
| 1 | tsp | |||
Directions: HEAT a drizzle of oil in a medium skillet over medium heat. Add the bell pepper and onion, cook for 2-3 minutes, or until tender. Stir in spinach and cook until wilted and any extra liquid has evaporated, about 2 minutes. Stir in spice mix and cook for 30 seconds. Wipe skillet clean and increase heat to medium-high.
WHISK (or prepare in bottles) egg replacer (“The Egg”) with 280 ml of water and 1 tbsp of oil until smooth. Pour into preheated pan and cook without stirring for 45 seconds. Continue to cook for 7 to 8 minutes using a rubber spatula to push egg around the pan. WHILE the egg cooks; in a small bowl mix together all pico de gallo ingredients, season with a little salt and pepper.
DIVIDE the cooked egg between 2 tortillas. Top with a sprinkle of shredded cheese and a spoonful of pico de gallo. FOLD up wrap and serve alongside any extra pico de gallo.
The following is an example of the egg replacer in a frittata. Table 12 below shows amounts and ingredients used in the Mini Frittatas, 3 different ways:
| TABLE 12 |
| Ingredients for Mini Frittatas, 3 different ways with egg |
| replacer (“The Egg”) |
| Ingredient: | Amount: | ||
| EGG BASE: |
| Milk or Dairy alternative | 1¼ | cup |
| egg replacer (“The Egg”), unprepared | 8 scoops/4 |
| Oil |
| 2 | |||
| Dijon Mustard | |||
| 1 | tbsp | ||
| MUSHROOM AND SPINACH | |||
| Spinach, chopped | 2 | cups | |
| Mushrooms, chopped | 1 | cup |
| Clove of garlic, minced | 1 |
| HERB AND SUN-DRIED TOMATO | ||||
| Sun-dried tomatoes, chopped | ½ | cup | ||
| Dried | 1 | tsp | ||
| BROCCOL AND CHEDDAR | ||||
| Broccoli Florets (½ inch pieces) | 1 | cup | ||
| Cheddar Cheese, shredded | ½ | cup | ||
Directions for the Mushroom and Spinach Filling: HEAT a drizzle of oil in a large skillet over medium heat, add chopped mushrooms and cook for 3-8 minutes or until tender and golden. Stir in spinach and cook for 1-2 minutes or until wilted and excess moisture has evaporated. Stir in garlic and season with salt and pepper, cook for 1 minute. Remove from heat and let cool slightly.
Directions for Assembling the Frittata: PREHEAT your oven to 400° F. and grease a 12 cup muffin tin. WHISK together milk, 1 cup of cold water, The Egg, oil, and mustard in a large bowl until smooth (if you are making the Herb and Sun-dried tomato Frittatas, whisk Italian spice blend into egg mixture). FILL eachmuffin tin 2□3rds full. Evenly divide your chosen filling among muffin cups, pressing filling in slightly.
BAKE for 14 to 16 minutes, or until set. Run a knife along the edges of each frittata and then gently scoop out and serve. They are best enjoyed while hot, but can be frozen for easy breakfast prep. Remove frozen frittatas from the freezer and microwave on power level 5 for 2-3 minutes or until heated through and fluffy.
Egg Variations will include the universal egg replacement, an egg replacement specific for baking which would not contain savory flavours added, the seasoned egg replacement (i.e. Tex mex, Italian, Mediterranean, Cajun, Other unique and trendy seasoning if market research shows a market for it).
May also include dehydrated vegetables for a “shake, pour and cook vegetable scramble egg.”
Commercial Uses will include replacement of chicken eggs in high volume bakeries, “non perishable eggs for camping,” offering a vegan egg alternative with a long shelf like for Restaurant use, use in Noodles.
Recipes will include: Eggless Pasta Dough, Egg Fried Rice with Spiced Chickpeas, Cinnamon Buns with Maple Glaze, Vegetable Pad Thai, Indian Style Pancakes with Spicy Ginger Tomato Jam, Mini Chocolate Doughnuts, Okonomiyaki (Japanese Pancakes), Cardamom Spiced Sugar Cookies, Shakshuka, eggs poached in spiced tomato sauce, Savoury Egg and Cheese Crepes, Vegetable Carbonara, Breakfast Pizza with Pesto, vegetables and Scrambled Egg, Huevos Rancheros, Egg Drop Soup, Breakfast Tostadas, Belgian Waffles with Coconut Whip, Bhurji Egg, Asparagus and Chive Quiche, Sautéed Vegetable and Pesto Gnocchi, Mini Green Onion and Gruyere Souffle, and Mayonnaise.
Introduction
Demand for high quality protein alternatives for animal protein gained significant attention lately for food, pharmaceutical, nutraceutical, cosmetic and other industrial applications. Proteins obtained from a wide variety of sources, including the proteins obtained from oil seeds, pulses, and other plant-based proteins have been used as an alternative for animal proteins. Lately, microorganisms such as micro algae, yeast, etc., have been considered as a potential source of second-generation plant proteins. Several prominent food industries are looking forward to leveraging microorganisms to deliver sustainable high-quality proteins. According to Business Wire, the total algae protein market will grow to a market size of US$0.838 by 2023, which was only US$0.596 in 2018.
Recently,Euglena gracilishas emerged as an interesting candidate for application-driven research and commercialization, as it is an excellent source of high-quality dietary protein, pro(vitamins), lipids, and the β-1,3-glucan paramylon. It as well as its natural ability to tolerate a number of external stresses, including acidic growth conditions and ionising radiation, and has been shown to be capable of heavy metal sequestration. Controlled growth ofEuglenain different media can be used to achieve high quality proteins, carbohydrates and lipids for value added food application.
Development of diary, meat and egg analogues using alternative protein are gaining more attention in the current society due to increasing global population and dietary restrictions. Eggs are the most commonly used ingredient worldwide and developing an alternative for eggs with the same nutritional value as the real egg is critical for future food security and malnutrition prevention. Currently available egg replacement in the market lacks nutritional value of the real egg. Furthermore, the quality of the protein present in the plant-based egg alternative is not as good as real egg protein as most of the plant proteins are incomplete since they lack some of the required essential amino acids. Therefore, egg alternative development usingEuglenabased protein, which is a complete protein, has huge potential.
An egg alternative formulation was already developed by Noblegen Inc. usingEuglenaprotein rich flour, which has similar nutritional and functional properties as that of real egg. However, the current cost associated with the dry egg production usingEuglenaprotein rich flour was high due to the involvement of spray drying ofEuglenabiomass to produceEuglenaprotein rich flour. Also, the existing formulation has used pea protein to meet the amount of required protein per serving (>6 g protein per serving). The objective of the present study was therefore to formulate liquid egg using freshEuglenabiomass with pea protein or wet freshEuglenaprotein concentrate without any pea protein with more than 6 g of protein per serving and a reasonable cooking time with high quality, safety and shelf life. Several attempts and experimentations were conducted to formulate a high quality, good tasting egg using freshEuglenabiomass and wetEuglenaprotein concentrate, which will be explained below in detail.
Objective
The main objective of this study was to formulate liquid egg usingEuglenafresh biomass grown in different media (protein rich or carbohydrate rich media) with different protein, carbohydrate and lipid content with more than 6 g protein per serving and less than 4.5 minute cooking time. Fresh biomass grown in protein rich and carbohydrate rich media were used for the egg formulation. The harvested biomass underwent a kill step to deactivate further growth ofEuglenaand a wash step prior to use of egg production.
To follow what was already learned from the dry egg formulation, the ingredients used in the initial formulation of liquid egg were kept the same as the final powder egg apart from using fresh biomass instead ofEuglenaprotein rich flour. Also, concentrations of gellan gum and methyl cellulose were varied to find the best combination to provide the right texture for the egg, at the same time to keep their amounts as minimal as possible to reduce the cost of the egg.
More studies were conducted with other hydrocolloids such as carrageenan, sodium alginate and pectin in order to see whether methyl cellulose or gellan gum can be partially or completely replaced with cheaper hydrocolloids with improved functionality. Several formulations were also tried to identify the best amount of biomass and pea protein incorporated, which facilitate highest incorporation ofEuglenabased ingredients at the same time allowing better pourability, cooking properties and functionalities. Table 13 shows the initial egg formulation developed using fresh biomass alone. Initial formulation was intended to formulate liquid eggs only using freshEuglenabiomass as the only protein source.
Results and Discussion
The pourability of the mixture was good and the cooking time was only 2.5 to 3.5 minute. However, the mixture did not form a proper curd/gelation like the real egg while cooking although after cooking it looked almost like the real egg (as can be seen inFIG.4 ). Furthermore, the protein content per serving did not meet the required amount, it was only 3.5 grams per serving and the serving size was too large.
| TABLE 13 |
| Initial liquid egg formulation developed using fresh biomass |
| alone as a protein source. Given below is formula for 1 egg. |
| Ingredient | Amount (g) | Amount (%) | ||
| Biomass * | 100 | 45.06 | ||
| Water | 100 | 45.06 | ||
| Oil (canola) | 20 | 9.01 | ||
| Gellan gum | 0.5 | 0.23 | ||
| Methyl cellulose | 0.625 | 0.28 | ||
| Yeast extract | 0.4 | 0.18 | ||
| Black salt | 0.4 | 0.18 | ||
| Total | 221.925 | 100 | ||
| * Biomass consists of 10% solid, and ~35% protein, ~40% carbohydrate and ~7% lipids | ||||
More studies were conducted by increasing gellan gum and methyl cellulose concentrations and biomass concentration in the formula 1 (Table 13), but no improvement in protein content per serving with a favourable texture for the product could not be achieved. Therefore, incorporation of various concentrations of pea protein (5 to 9.5%) with various concentrations of fresh biomass (60 to 85%) and water (0 to 35%) were tried in different formulations, and came up with a formulation which is given in Table 14.
| TABLE 14 |
| Liquid egg formulation using fresh biomass and pea protein |
| as protein sources. Given below is a formula for 4 eggs. |
| Ingredient | Amount(g) | Amount (%) | ||
| Biomass | 250 | 73.06 | ||
| Pea protein | 25 | 7.31 | ||
| Sunflower oil | 20 | 5.84 | ||
| Water | 42 | 12.27 | ||
| Gellan gum | 2.1 | 0.61 | ||
| Methyl | 2.25 | 0.66 | ||
| Cellulose | ||||
| Black salt | 0.45 | 0.13 | ||
| Yeast extract | 0.4 | 0.12 | ||
| Total | 342.2 | 100 | ||
Results and Discussion
The liquid egg had a less than 2.5 minute cooking time, good texture and about 7.2 g protein per serving. After cooking the amount of cooked product was able to give about 50 g cooked product (seeFIG.5 ).
Further studies were conducted by varying methyl cellulose concentrations from 0.6 to 0.8% and gellan gum concentrations from 0.4 to 0.7%. A formula shown in Table 15 was the best concentrations of methyl cellulose and gellan gum and shown inFIG.6 .
| TABLE 15 |
| Formula for liquid egg using fresh biomass and pea protein |
| with the right amount of methyl cellulose and gellan gum. |
| Formula given below is for four eggs. |
| Ingredient | Amount(g) | Amount (%) | ||
| Biomass | 250 | 62.36 | ||
| Pea protein | 25 | 6.24 | ||
| Sunflower oil | 20 | 4.99 | ||
| Water | 97 | 24.20 | ||
| 2 | 0.50 | |||
| Methyl | 3.1 | 0.77 | ||
| Cellulose | ||||
| Black salt | 0.8 | 0.20 | ||
| Yeast extract | 1.5 | 0.37 | ||
| onion powder | 0.5 | 0.12 | ||
| Transglutaminase | 1 | 0.25 | ||
| Total | 400.9 | 100 | ||
One observation during cooking was that the cooked egg was turning hard faster than the real egg. In order to prevent the hardening of the cooked egg, sunflower lecithin (an emulsifier), transglutaminase (an enzyme helps the gelling of protein) and baking powder was investigated to improve cooking texture. In total, about 30 formulations were tried.
It was found that the addition of sunflower lecithin, transglutaminase and baking powder improved the texture of the egg formulated using fresh biomass and pea protein. Two formulations shown in Table 16 were selected as two best formulations with and without transglutaminase in the formulation. Although it was better to have transglutaminase in the formula, the material was gelling in the refrigerator during storage and decreasing pourability of the egg. Moreover, transglutaminase may cause allergy and there may be regulatory issues associated with its use, so an alternative formulation without transglutaminase was finalized.
| TABLE 16 |
| Final liquid egg formulations using fresh biomass and |
| pea protein. |
| Amount | Amount | Amount | Amount | |||
| Ingredient | (g) | (%) | (g) | (%) | ||
| Biomass | 250 | 54.93 | 250 | 62.20 | ||
| Pea protein | 25 | 5.49 | 25 | 6.22 | ||
| Sunflower oil | 20 | 4.39 | 20 | 4.98 | ||
| Water | 150 | 32.96 | 97 | 24.14 | ||
| 2 | 0.44 | 2 | 0.50 | |||
| 3 | 0.66 | 3.1 | 0.77 | |||
| Black salt | 0.8 | 0.18 | 0.8 | 0.20 | ||
| Yeast extract | 1.5 | 0.33 | 1.5 | 0.37 | ||
| onion powder | 0.5 | 0.11 | 0.5 | 0.12 | ||
| 1 | 0.22 | 1 | 0.25 | |||
| Sunflower | 1.3 | 0.29 | 0 | 0 | ||
| lecithin | ||||||
| Transglutaminase | 0 | 0 | 1 | 0.25 | ||
| Total | 455.1 | 100 | 401.9 | 100 | ||
Results and Discussion
The eggs were formulated usingformula
More studies were conducted in order to find the best hydrocolloid for the liquid egg. In order to do that, either gellan gum or methyl cellulose was replaced in theformula 1 shown in Table 16 with carrageenan, sodium alginate, and pectin. However, none of these hydrocolloids worked as good as the combination of methyl cellulose and gellan gum. No egg like structure or gelling happened while using these hydrocolloids. Furthermore, the cooking time increased. Therefore, these hydrocolloids were excluded from any future studies. The best combination was still gellan gum with methyl cellulose (2:3 ratio)
Eggs were prepared using the same formulation shown in Table 16 (formula 1) using biomass grown in protein rich or carbohydrate rich media and in different fermentation tanks. The following were then found.
Although two biomasses were grown in different media, the amount of protein (˜35%) and carbohydrates (˜40%) presented in the biomasses were not significantly different. Not much difference between the texture of the egg made using protein rich media and carbohydrate rich media grown biomasses. Biomass from the protein rich media was more viscous and gave slightly higher fluffy texture for the egg.
Carbohydrate rich grown biomass has better flavour than protein rich one, even without any maskers added, provided better flavour for the product, but it has less yellow color. The good flavour might be due to the difference in washing step used for the carbohydrate rich media grown biomass, which was washed with 2.5 times water compared to the protein rich biomass which was just diluted with water and centrifuged.
Conclusions
A liquid egg with less than 2 minutes cooking time and 7.5 g protein per serving with a serving content of 53 g can be prepared using fresh biomass grown either using protein rich media or carbohydrate rich media in combination with pea protein. Flavour of the egg can be improved by addition of yeast extract, black salt and onion powder. The texture of the egg was achieved by using the right combination of methyl cellulose and gellan gum and pea protein and biomass. This egg is similar to a standard chicken egg which when cooked is 50-55 g, 6-6.5 g of protein per serving for less than a minute cook time.
Fresh biomass with 10 w/w % solid content only consisting of 35% protein, which will only provide a maximum of 3.5 g protein is used 100 g biomass in one serving of egg. If the protein content in the biomass can be enhanced, a higher amount of protein fromEuglenacan be achieved in the egg formulation. In order to do that, the beta glucan isolate (BGI), the carbohydrate present in theEuglenabiomass, was removed from the biomass and the protein was concentrated using isoelectric precipitation method.
Liquid Egg Objective:
Objective of the described study was to formulate liquid egg using wet protein concentrate alone as a protein source in the liquid egg with reasonable cooking time and similar texture as that of the liquid egg formulated using fresh biomass and pea protein.
The first formulation of liquid egg using wet protein concentrate was prepared using a protein concentrate with 4-5 w/w % solid content. The formula is shown in Table 17.
| TABLE 17 |
| The liquid egg formulation using wet protein |
| concentrate with 5 w/w % solid content. Given |
| below is the formula for 1 egg. |
| Ingredient | Amount(g) | Amount (%) | ||
| Protein | 200 | 93.79 | ||
| concentrate | ||||
| Pea protein | 0 | 0 | ||
| Sunflower oil | 10 | 4.69 | ||
| Water | 0 | 0 | ||
| Gellan gum | 0.5 | 0.23 | ||
| Methyl Cellulose | 0.75 | 0.35 | ||
| Black salt | 0.3 | 0.14 | ||
| Yeast extract | 0.5 | 0.23 | ||
| onion powder | 0.2 | 0.09 | ||
| Baking powder | 0.5 | 0.23 | ||
| Sunflower | 0.5 | 0.23 | ||
| lecithin | ||||
| Total | 213.25 | 100 | ||
Results and Discussion
The cooking time for this formula was about 4 min, but it did not form a texture similar to the liquid egg prepared using fresh biomass and pea protein. There were no curd or gel formations occurred and obtained a product shown inFIG.7 .
The cooked product was only 46 g with 5.6 g protein per serving. Although the amount of gellan gum and methyl cellulose shown in the formula was increased to 0.5% and 0.7%, respectively, no betterment in the egg texture was obtained. The issue was having not enough functional protein in the formulation. This can be achieved by increasing the wet protein concentrate in the formulation, but it will also increase the cooking time and increase in hydrocolloid addition might be also required. Therefore, it was necessary to increase the solid content of the initial wet protein concentrate to increase the protein content in the formula without increasing any cooking time or having to use a higher amount of hydrocolloid.
A new formulation of liquid egg was then obtained with a protein concentrate that has about 15% solids content. The final formula developed using this protein concentrate is shown in Table 18.
| TABLE 18 |
| Liquid egg formula using Euglena protein concentrate |
| with 15 w/w % solid content |
| Ingredient | Amount(g) | Amount (%) | ||
| Protein concentrate | 60 | 55.56 | ||
| Pea protein | 0 | 0 | ||
| Sunflower oil | 5 | 4.63 | ||
| Water | 40 | 37.04 | ||
| Gellan gum | 0.5 | 0.46 | ||
| Methyl Cellulose | 0.9 | 0.83 | ||
| Black salt | 0.3 | 0.28 | ||
| Yeast extract | 0.3 | 0.28 | ||
| onion powder | 0.2 | 0.18 | ||
| Baking powder | 0.5 | 0.46 | ||
| Sunflower lecithin | 0.3 | 0.28 | ||
| Transglutaminase | 0 | 0 | ||
| Total | 108 | 100 | ||
Results and Discussion
Liquid egg with 6.25 g protein per serving with a serving size of 49 g (cooked product) was developed using wet protein concentrate with ˜15 w/w % solid content as can be seen inFIG.8 . Texture of this egg was not as good as the liquid egg formulated using fresh biomass and pea protein, but very close to that. Flavour of the egg was close to the liquid egg prepared using fresh biomass and pea protein, however the fresh biomass liquid egg was better
Conclusions
A liquid egg with more than 6 g protein per serving and less than 2 minutes cooking time with a serving size of ˜50 g was formulated using wet protein concentrate in whichEuglenaprotein is the only protein source. Texture of the egg formulated using only wetEuglenaprotein concentrate was very similar to the liquid egg formulated using fresh biomass and pea protein.
Although the texture of the cooked eggs formulated using both fresh biomass and wet protein concentrate was very close to the real egg, the flavour of theEuglenabased egg was not anything close to the real egg. The unfavourable marine flavour of theEuglenapersisted in the final egg product even though yeast extract, black salt and onion powder was added.
For the liquid egg formulations using fresh biomass or wet or powderedEuglenaprotein concentrate maskers are required to mask the marine flavours ofEuglena. An ideal masker should completely mask the off notes (both aroma and flavour) coming fromEuglenaduring cooking and in cooked products without introducing any new flavours or aroma. Flavours can also be used to improve the flavour of cooked liquid egg. Ideal flavour should provide a flavour that is similar to cooked real egg. Since the amount ofEuglenais higher in protein concentrate a higher amount of masker/flavour will be required for protein concentrate based liquid egg formulations. Some of these maskers that could cover the off notes (marine flavour ofEuglena) are commercially available from: Firmenich, IFF, Givaudan, Symrise, Mane, Fona, Flavor producer, McCormick, edlong, T⋅Hasegawa. Sensient Flavors, Robertet SA, Prova, Wild/ADM, Takasago, Synergy, and others.
Since the biomass and the wet protein concentrate consists of a significant amount of water, it facilitates the growth of microorganisms such as bacteria, yeast and mold, which leads to the spoilage of biomass/wet protein concentrate. It can also lead to spoilage of the liquid egg formulated using these materials during the storage. Therefore, it is essential to understand if there is any growth of microbes and the spoilage time and adopt any prevention method to protect the biomass/wet protein concentrate from spoilage.
Identification of Microbes in the Fresh Biomass and Wet Protein Concentrate
Method Used for Microbial Analysis of Fresh Biomass:
Obtained fresh biomass and biomass was washed 1 time with 2.5 times with water. The biomass was diluted to 10% (solid content-10.36 w/w %), initial pH was pH 3.35 and the pH was adjusted to 7.2 using 2.5 M NaOH. A small amount of this biomass was then spread on a TSA plate in a biosafety cabinet with a sanitized environment and stored at 30° C. for 2 days to see any growth. A negative control was also used (a TSA plate left opened during sampling and stored with the sample plates). The biomass was stored in the 4° C. refrigerator for 3 days plating was done after 3 hours, 6 hours and 18 hours of storage. The images of plates after two days of storage are shown inFIG.9 .
Results and Discussions:
The presence of microbes such as bacteria, yeast and mold were detected in fresh biomass and they continued their growth during storage. The number of microbes found were not correlated with storage time, this might be due to the inconsistency of the amount of sample poured on to the plate.
Method Used for Microbial Analysis of Wet Protein Concentrate:
The wet protein concentrate with 17.6% solid was diluted with 4 times water. The pH was then adjusted to pH 4.5 and a sample was poured into a TSA plate. The plate was then stored at 30° C. to facilitate the growth of microbes if there is any. A negative control was also used as described above.
Results and Discussions:
The image of the TSA plate after two days of storage at 30° C. is shown inFIG.10 . When a small sample from the growth was viewed under the microscope, presence of various kinds of bacteria as well as the presence of fungus were observed.
Methods Tested to Prevent the Growth of Microorganism in Fresh Biomass and Wet Protein Concentrate
There are several approaches to prevent the growth of microorganisms in the wet food systems i.e. biomass, wet protein concentrate or liquid egg. Most common approaches are pasteurization and treatment of food products with food grade and safe antimicrobial agents such as Nisin, cultured dextrose, organic acids etc.
The first approach tried was the pasteurization of liquid eggs. Pasteurization is a method in which the required product will be heated to a specific selected temperature for required time to kill the microorganisms presented in the food systems. Then the food material will be packed safely to prevent the entrance of any microbes and thus protect the food systems from spoilage.
Four different temperatures were chosen to pasteurize liquid eggs, 70° C., 65° C., 60° C. and 55° C. The liquid egg was heated to this temperature for 30 minutes. Even heating of liquid egg at 55° C. leads to the gelation of gellan gum into the formula and the product cannot be used or cooked after words. Therefore, it was understood that the pasteurization of the final liquid egg formula is not possible. Hence, pasteurization of fresh biomass and treatment of fresh biomass with an antimicrobial agent, Nisin was investigated.
Pasteurization Method:
Collected fresh biomass and diluted to 10% solid and adjusted the pH to pH 7 and plated on a TSA plate. Biomass was heat treated to killEuglenaand 2.5 times washed. A fraction of biomass was heat treated at 75° C. for 15 minutes. This temperature was chosen to keep the protein protected from denaturation as much as possible (denaturation of protein might affect the functionality of protein and performance of liquid egg during cooking.) To do that 50 g of biomass with 10% solid and pH 7 was taken in a 250 ml glass beaker (washed with 70% ethanol and dried) and heated in a water bath set at 99° C. After heat treatment, the material was quickly immersed in an ice bath and brought back the temperature to 20° C. A small aliquot of non-treated (control—C) and heat-treated (pasteurized—P) samples were plated and incubated at 30° C. for 6 days to see any microbial growth.
Microbial Analysis: A small portion of plate with microbial growth was dispersed in water and observed under a light microscope. The remaining portion is sent for a detailed identification test. The analysis showed the presence of Lysinbacillus and two fungal genera,aspergillusandFusarium.
Results and Discussions:
Observation: Irrespective of heat treatment, all biomass displayed presence of microbes (FIG.11 ). Microscopic analysis showed the presence of bacteria in both heated and non-heated biomass, but presence of fungus was only observed in non-heated biomass (FIG.12). The study shows that the heat-treatment at 15 minutes was not enough to kill the bacteria but was enough to kill the fungus.
Treatment of Biomass with Nisin:
Method: Obtained fresh biomass and was washed 1 time with 2.5 times water. The biomass was diluted to 10% (solid content-10.36 w/w %, initial pH was pH 3.35 and the pH was adjusted to 7.2 using 2.5 M NaOH. Then 70 ppm of nisin was added to 500 g biomass, mixed well and split into 2 parts and one bottle was left in the 4° C. refrigerator and the other one at room temperature. Similarly, about the same amount of biomass without Nisin was also left at both conditions.
Results and Discussions:
Presence of microbes were found at all storage conditions irrespective of the presence of nisin or storage time. Presence of bacteria and yeast were detected on the TSB plates (microscopic analysis) as can be seen inFIGS.13-17 . Increased amount of growth was not correlated with presence of nisin or storage time (might be due to the inconsistency in the amount of sample used for plating).
Conclusions:
Pasteurization at lower temperature or treatment with 75 ppm of Nisin will not be able to prevent the growth of microorganisms in the fresh biomass or wet protein concentrate. Therefore, alternative methods need to be obtained to prevent the spoilage of biomass, wet protein concentrate as well as liquid egg during storage.
Effect of pH, Heat Treatment and Antimicrobial Treatment on the Microbial Growth and Spoilage of Biomass
Objective:
Objective of the study was to determine whether heat treatment, storage pH and addition of antimicrobial substances has any effect on the microbial growth and spoilage of biomass stored in the 4° C. refrigerator.
Procedure:
A biomass stored in the refrigerator at harvested pH (pH 2.75) for 2 days after harvest was chosen for microbial analysis. Four different pH conditions were used for non-heat treated biomass storage,pH 3, 4.5, 5 and 7. Three different antimicrobials (see Table 19 for the names and usage levels) were added to biomass at each pH selected. Control without any antimicrobial agents were also stored at different selected pHs. All the biomass samples were stored in a 4° C. refrigerator for 5 days and a TSA plate assay was done to see the presence of any microbes at the 5 day mark.
| TABLE 19 |
| Antimicrobials tested on freshly harvested biomass |
| Short form | ||||
| Antimicrobials selected | used | Usage level | ||
| Calcium propionate | CP | 1000 ppm | ||
| Sodium benzoate + potassium | SB + PB | 1000 ppm each | ||
| sorbate | ||||
| Cultured dextrose (Bio Vontage | BV | 0.25% (w/w) | ||
| 2662) | ||||
Heat Treatment of Biomass:
The same biomass used in the previous step was taken in a glass beaker and heated in a water bath at 95° C. The temperature of the biomass was reached at 75° C. and stayed constant. The biomass was then left at this temperature for 30 minutes and stirred using a sterilized spatula every 5 minutes. The biomass was then immediately cooled using an ice bath left in a biosafety cabinet to room temperature. The pH of this biomass was then adjusted topH 3, 4.5 and 5 and added a mixture of Sodium benzoate and Bio Vontage 2662 (cultured dextrose) was added at each pH condition. A heat treated biomass without any antimicrobial agents was also stored at each pH as a control. The biomass was stored in a 4° C. refrigerator and TSA plate analysis was conducted to see any microbial growth.
Results and Discussions:
Images of TSA plates of heat treated and non-heat treated biomass on the first day of microbial analysis study is shown inFIG.18 . As seen, there was no microbial growth in heat treated biomass but there was evidence of Fungal growth in non-heated biomass. The growth found in non-heated biomass was observed under microscope and it was found that the growing microbe was yeast (seeFIG.19 )
The images of plates of non-heat treated biomass control and with antimicrobial agents is seen inFIG.20 . Images of plates from heat treated (75° C. for 30 minutes) with and without antimicrobial agents is seen inFIG.21 .
As can be seen fromFIG.20 andFIG.21 , the microbial growth in the biomass was determined by the pH of the biomass, presence of antimicrobial agents and heat treatment. When the biomass was not heat treated, even with antimicrobial agents, microbes were present at pH 7. The microscopic analysis showed that the microbes present at pH 7 were yeast and mold. However at all the other pH, addition of the combination of SB+PS helped to prevent any microbial growth. In fact, these antimicrobial agents killed all the microbes present in the biomass and none of the other antimicrobial agents tested were as effective. In the case of the heat treated biomass, no microbial growth was observed in any pH even without any antimicrobials, except, there was microbial growth at pH 4.5 when Bio Vontage was present. A summary of the type of microorganisms presented in non-heat treated and heat treated biomass at different pH is shown in Table 20 and 21, respectively.
| TABLE 20 |
| Microbial growth observed in non-heat treated biomass with |
| antimicrobials at different pH after storage in the refrigerator |
| for 5 days. Control has no antimicrobial agents. |
| pH | Control | CP | SB + | BV | |
| 3 | yeast | yeast | no microbes | yeast (very low |
| in number) | ||||
| 4.5 | yeast and | yeast | no microbes | yeast |
| mold | ||||
| 5 | yeast and | yeast and | no microbes | yeast and mold |
| mold | mold | |||
| 7 | yeast and | yeast and | yeast and mold | yeast and mold |
| mold | mold | |||
| TABLE 21 |
| Microbial growth observed in heat treated biomass with |
| antimicrobials at different pH after storage in the refrigerator |
| for 5 days. Control has no antimicrobial agents |
| pH | Control | SB + | BV | |
| 3 | no microbes | no microbes | no microbes |
| 4.5 | no microbes | no microbes | Fungus |
| 5 | no microbes | no microbes | no microbes |
Samples without any microbial growth were considered for further storage study. After 16 days of storage, a TSA plating was done on all the heat treated biomass and non-heated biomass with SB+PS atpH 3, 4.5 and 5. The results are shown inFIG.22 and Table 22.
| TABLE 22 |
| Types of microbes found in different biomass after |
| 16 days of storage in the refrigerator at different |
| Sample | pH |
| 3 | pH 4.5 | pH 5 | ||
| non-heat treated biomass with | Bacteria | none | none | |
| SB + PS | ||||
| Heated biomass-control | none | none | none | |
| Heated biomass with BV | none | none | Fungus | |
| (yeast) | ||||
| Heated biomass with SB + PS | bacteria | none | none | |
Conclusions:
When there is only Fungi present in the biomass, they can be removed by heat treating the biomass to at least at 70° C. for 30 minutes. Addition of a mixture of 1000 ppm each potassium sorbate and sodium benzoate could also help prevent the microbial growth even if not heat treated and the pH of biomass is abovepH 3.
Microbial Analysis of Liquid Egg Formulated Using Spray DriedEuglenaProtein Concentrate Powder
Objective:
There were microbes such as bacteria, and fungi were present in wet biomass and wet protein concentrate. Therefore, the shelf life of liquid egg produced using this wet protein concentrate is short due to microbial spoilage. It is expected that the microbes are killed during the spray drying process and it will be safe to use spray dried protein concentrate for the liquid egg production. The objective of the current study was to see if there is any microbial growth in the liquid egg prepared using spray dried protein concentrate powder and its shelf life.
Procedure:
The liquid egg was prepared using protein concentrate powder using the formula shown in Table 23. The egg was prepared in a sterilized container using sterilized equipment. The egg was then poured into sterilized 50 ml centrifuge tubes and stored in the refrigerator. A mixture of Cultured Dextrose Bio Vontage 2662 (BV, 0.25 w/w %) and 500 ppm of Nisin was added to the egg and also stored at the same condition. The antimicrobials were mixed with egg for 30 minutes, and the pH of the egg before and after addition of the antimicrobial mixture was taken. A TSA plate assay was done on the same day right after the egg was prepared and another plate after 3 days of storage. TSA plates were incubated at 30° C. for 3 days before analysis.
| TABLE 23 |
| Formulas used for egg formulation using dried |
| protein concentrate powder |
| Ingredient | Amount(g) | Amount (%) | ||
| Protein concentrate (powder) | 9 | 7.69 | ||
| Sunflower oil | 5 | 4.27 | ||
| Water | 100 | 85.47 | ||
| Gellan gum | 0.5 | 0.43 | ||
| Methyl Cellulose | 0.9 | 0.77 | ||
| Black salt | 0.3 | 0.26 | ||
| Yeast extract | 0.3 | 0.26 | ||
| onion powder | 0.2 | 0.17 | ||
| Baking powder | 0.5 | 0.43 | ||
| Sunflower lecithin | 0.3 | 0.26 | ||
| Total | 117 | 100 | ||
Results and Discussions:
The pH of the liquid egg prepared using protein concentrate powder was 6.75, pH of the egg did not change much with the addition of antimicrobial agents although it was expected to have a shift of pH to lower pH side due to the addition of BV (cultured dextrose).
The images of TSA plates of liquid egg done on the day of preparation and after 3 days of storage are shown inFIG.23 (A-C) as well as microscopic images (D-F). The microbial growth was observed in all the plates. The microscopic analysis showed there were both circular and rod-like bacteria present in the egg, and within three days the egg's smell changed negatively. However, with Nisin and BV treatment, the number of rod shaped bacteria did decrease compared to the control. It was also noticed that the viscosity of the egg increased almost to not flowing easily out of the tube with the changes to the recipe. Further optimization is needed in order to improve viscosity if this treatment is to be used.
Conclusions:
Conclusions: Since the pH of the egg formulation was close to pH 7, it was not possible to prevent any microbial growth even if we use spray dried protein concentrate powder for egg formulation. Therefore, it is important to try formulate the egg at a lower pH, for example 4.5, for future formulations.
Summary of Microbial Analysis of Biomass and Liquid Egg Formulated Using Protein Concentrate Powder
While there was the presence of both bacteria and Fungi found in fresh biomass, it is likely that the microbial growth in biomass was determined by the pH of the biomass. pH 7 was found to be favourable for both bacteria and fungi while lower pH without heat treatment was still favourable for fungi (yeast). It was found that heat treatment of the biomass at 75° C. for 30 minutes can kill the fungi. After heat treatment, the biomass is fungal growth free for 16 days if refrigerated at a pH≤5. The activity of antimicrobial agents was affected by the pH, for example all of the tested antimicrobials were only functional if the pH of the biomass was pH≤5. A combination of potassium sorbate and sodium benzoate (1000 ppm each) could kill microbes and keep it out of any microbial growth if the pH of the biomass is below pH 5 and abovepH 3. Since the pH of protein concentrate is at pH 7, the microbial growth cannot be prevented without further measures to changing its pH. If the pH of the liquid egg is pH 4.5, it should be able to prevent any microbial growth.
It is essential to understand the changes occurring in liquid egg formulation during storage to see if there is any breakdown of components which affects the quality and safety of the product. Moreover, changes in viscosity of the liquid egg during storage also needs to be considered as it might affect the pourability and cooking quality of the liquid egg once it reaches the customer.
To understand the storage stability, the pourability, viscosity, consistency of the liquid egg formulation will be checked at different times during storage at the refrigerator. Also cooking will be done different days during storage to see how it performs.
The disclosures of each and every patent, patent application, publication, and accession number cited herein are hereby incorporated herein by reference in their entirety.
Preferences and options for a given aspect, feature, embodiment, or parameter of the invention should, unless the context indicates otherwise, be regarded as having been disclosed in combination with any and all preferences and options for all other aspects, features, embodiments, and parameters of the invention.
While present disclosure has been disclosed with reference to various embodiments, it is apparent that other embodiments and variations of these may be devised by others skilled in the art without departing from the true spirit and scope of the disclosure. The appended claims are intended to be construed to include all such embodiments and equivalent variations.
Claims (20)
1. A dry egg replacement composition comprising about 1% to about 100%Euglena-derived material, about 0.05% to about 70% additional protein source, and one or more additional ingredients, wherein the dry egg replacement composition comprises one or more functional property of a natural egg.
2. The dry egg replacement composition ofclaim 1 , wherein theEuglena-derived material is selected from the group consisting of aEuglenabiomass,Euglena-derived protein, a protein-rich flour derived fromEuglena, a protein concentrate derived fromEuglena, a protein isolate derived fromEuglena, Euglena-derived beta-glucan isolate,Euglena-derived oils, and combinations thereof.
3. The dry egg replacement composition ofclaim 1 , wherein the additional protein source is selected from the group consisting of pea protein, soy protein, corn protein, wheat protein, rice protein, beans protein, seed protein, nut protein, almond protein, peanut protein, seitan protein, lentil protein, chickpea protein, flaxseed protein, wild rice protein, quorn protein, chia seed protein,quinoaprotein, oat protein, fava bean protein, buckwheat protein, bulgar protein, millet protein, microalgae protein, yellow pea protein, mung bean protein, hemp protein, sunflower protein, canola protein, lupin protein, legumes protein, potato protein, and combinations thereof.
4. The dry egg replacement composition ofclaim 3 , wherein the ratio ofEuglena-derived material to pea protein is about 20:80 to about 50:50.
5. The dry egg replacement composition ofclaim 3 , wherein the ratio ofEuglena-derived material to pea protein is about 40:60.
6. The dry egg replacement composition ofclaim 1 , wherein the one or more additional ingredients are selected from the group consisting of gellan gum, methylcellulose, yeast extract, flavoring, antioxidant blend, maskers, leavening agents, baking powder, baking soda, enzymes, transglutaminase, emulsifiers, lecithin, mono- and diglycerides, binders, carrot fiber, defatted linseed flour, and combinations thereof.
7. The dry egg replacement composition ofclaim 6 , wherein the flavoring is selected from the group consisting of black salt, black pepper, Himalayan sea salt, salt, onion powder, minced onion, roasted garlic, mushroom powder, yeast extract, and a combination thereof.
8. The dry egg replacement composition ofclaim 6 , wherein the flavoring is in an amount of about 0.05% to about 0.5%.
9. The dry egg replacement composition ofclaim 1 , further comprising one or more hydrocolloids.
10. The dry egg replacement composition ofclaim 9 , wherein the one or more hydrocolloids is in an amount of about 0.05% to about 8%.
11. The dry egg replacement composition ofclaim 9 , wherein the one or more hydrocolloids is selected from the group consisting of locust bean gum, a guar gum, a konjac gum, a gellan gum, a high methoxy pectin, a low methoxy pectin, an Agar, a kappa carrageenan, an iota carrageenan, a lambda carrageenan, an alginate, a curdlan, a methyl cellulose, a carboxymethyl cellulose (CMC), a xanthan gum, a gum Arabic, aEuglenaderived beta-glucan, and combinations thereof.
12. The dry egg replacement composition ofclaim 1 , wherein the dry egg replacement composition contains at least 6 g of protein.
13. The dry egg replacement composition ofclaim 1 , wherein theEuglena-derived material is in an amount of about 40% to about 90% in the dry egg replacement composition.
14. The dry egg replacement composition ofclaim 1 , wherein the additional protein source is in an amount of about 20% to about 60%.
15. The dry egg replacement composition ofclaim 1 , wherein the one or more additional ingredients are in an amount of about 0.05% to about 5%.
16. The dry egg replacement composition ofclaim 1 , wherein the dry egg replacement has at least 2 functional properties of a natural egg.
17. The dry egg replacement composition ofclaim 1 , wherein the one or more functional properties is selected from the group consisting of complete nutrition, protein digestibility-corrected amino acid score (PDCAAS), gelation, foaming, viscosity, emulsification, water binding capacity, texture, elasticity, springiness, solubility, flavor, coagulation, aeration, creaminess, film forming property, sheen addition, shine addition, freeze stability, thaw stability, color, and combinations thereof.
18. A food product comprising the dry egg replacement composition ofclaim 1 .
19. The food product ofclaim 18 , wherein the dry egg replacement composition has provided one or more functional properties to the food product it has been incorporated into.
20. The food product ofclaim 19 , wherein the functional properties are selected from the group consisting of crumb density, structure/texture, elasticity, springiness, coagulation, binding, moisturizing, mouthfeel, leavening, aeration/foaming, creaminess, and emulsification.
Priority Applications (1)
| Application Number | Priority Date | Filing Date | Title |
|---|---|---|---|
| US17/783,990US11672265B2 (en) | 2019-12-09 | 2020-12-09 | Egg replacement containing euglena-derived components |
Applications Claiming Priority (3)
| Application Number | Priority Date | Filing Date | Title |
|---|---|---|---|
| US201962945599P | 2019-12-09 | 2019-12-09 | |
| PCT/IB2020/061714WO2021116949A1 (en) | 2019-12-09 | 2020-12-09 | Egg replacement containing euglena-derived components |
| US17/783,990US11672265B2 (en) | 2019-12-09 | 2020-12-09 | Egg replacement containing euglena-derived components |
Publications (2)
| Publication Number | Publication Date |
|---|---|
| US20230055716A1 US20230055716A1 (en) | 2023-02-23 |
| US11672265B2true US11672265B2 (en) | 2023-06-13 |
Family
ID=76329665
Family Applications (1)
| Application Number | Title | Priority Date | Filing Date |
|---|---|---|---|
| US17/783,990ActiveUS11672265B2 (en) | 2019-12-09 | 2020-12-09 | Egg replacement containing euglena-derived components |
Country Status (4)
| Country | Link |
|---|---|
| US (1) | US11672265B2 (en) |
| EP (1) | EP4072323A1 (en) |
| CA (1) | CA3164116A1 (en) |
| WO (1) | WO2021116949A1 (en) |
Families Citing this family (11)
| Publication number | Priority date | Publication date | Assignee | Title |
|---|---|---|---|---|
| WO2021116949A1 (en) | 2019-12-09 | 2021-06-17 | Noblegen Inc. | Egg replacement containing euglena-derived components |
| AU2021204817A1 (en)* | 2021-07-07 | 2023-02-02 | Nabati Foods Inc. | Egg substitute and method of manufacture |
| KR102677880B1 (en)* | 2021-10-06 | 2024-06-25 | 순천향대학교 산학협력단 | Egg yolk-free mayonnaise using rice protein and maunfacturing method thereof |
| JP2024546074A (en)* | 2021-11-25 | 2024-12-17 | ネッグスト フーズ ゲーエムベーハー | Use of biodegradable, bio-based thermoplastic materials having a brittle fracture mechanism as shells for eggs or egg substitute products, and vegan substitute products coated with such shells |
| WO2023148344A1 (en)* | 2022-02-03 | 2023-08-10 | Algama | Specialized plant-based egg substitute for the production of emulsified sauces |
| DE102022201547A1 (en) | 2022-02-15 | 2023-08-17 | DIL Deutsches Institut für Lebensmitteltechnik e.V. | Vegan composition |
| EP4238425A1 (en) | 2022-03-04 | 2023-09-06 | Silvan Leibacher | Egg substitute product, method for producing such an egg substitute product and use of such an egg substitute product |
| EP4501128A1 (en)* | 2022-03-31 | 2025-02-05 | Fuji Oil Holdings Inc. | Egg substitute and method for producing egg substitute |
| DE102022001337A1 (en)* | 2022-04-17 | 2023-10-19 | Fritz Briem | Process for producing a vegan liquid egg substitute product |
| EP4514149A1 (en)* | 2022-04-29 | 2025-03-05 | Société des Produits Nestlé S.A. | Egg analogue product based on soy and canola protein |
| EP4494477A1 (en)* | 2023-07-21 | 2025-01-22 | Lovely Day Foods GmbH | Egg substitute |
Citations (4)
| Publication number | Priority date | Publication date | Assignee | Title |
|---|---|---|---|---|
| CA2500125A1 (en) | 2004-03-15 | 2005-09-15 | Moark, Llc | Egg nuggets and method of preparing egg nuggets |
| CA2740415A1 (en) | 2008-10-14 | 2010-04-22 | Solazyme, Inc. | Food compositions of microalgal biomass |
| US20100303989A1 (en)* | 2008-10-14 | 2010-12-02 | Solazyme, Inc. | Microalgal Flour |
| WO2021116949A1 (en) | 2019-12-09 | 2021-06-17 | Noblegen Inc. | Egg replacement containing euglena-derived components |
- 2020
- 2020-12-09WOPCT/IB2020/061714patent/WO2021116949A1/ennot_activeCeased
- 2020-12-09CACA3164116Apatent/CA3164116A1/enactivePending
- 2020-12-09USUS17/783,990patent/US11672265B2/enactiveActive
- 2020-12-09EPEP20897823.9Apatent/EP4072323A1/ennot_activeWithdrawn
Patent Citations (4)
| Publication number | Priority date | Publication date | Assignee | Title |
|---|---|---|---|---|
| CA2500125A1 (en) | 2004-03-15 | 2005-09-15 | Moark, Llc | Egg nuggets and method of preparing egg nuggets |
| CA2740415A1 (en) | 2008-10-14 | 2010-04-22 | Solazyme, Inc. | Food compositions of microalgal biomass |
| US20100303989A1 (en)* | 2008-10-14 | 2010-12-02 | Solazyme, Inc. | Microalgal Flour |
| WO2021116949A1 (en) | 2019-12-09 | 2021-06-17 | Noblegen Inc. | Egg replacement containing euglena-derived components |
Non-Patent Citations (4)
| Title |
|---|
| "Noblegen Achieves Self-GRAS Affirmation for Protein-Rich Euglena Flour" Dec. 4, 2019, https://m.canadianinsider.com/noblegen-achieves-self-gras-affirmation-for-protein-rich-euglena-flour. |
| FR 3 110339-Machine Translation (Year: 2021).* |
| International Search Report and Written Opinion for PCT/IB2020/061714 dated Mar. 2, 2021. |
| US FDA GRAS Notice 697, GRAS Notice for Dried Euglena gracilis (ATCC-PTA 123017) Mar. 16, 2017, https://www.fda.gov/media/106482/download. |
Also Published As
| Publication number | Publication date |
|---|---|
| CA3164116A1 (en) | 2021-06-17 |
| US20230055716A1 (en) | 2023-02-23 |
| WO2021116949A1 (en) | 2021-06-17 |
| EP4072323A1 (en) | 2022-10-19 |
Similar Documents
| Publication | Publication Date | Title |
|---|---|---|
| US11672265B2 (en) | Egg replacement containing euglena-derived components | |
| CN104203000B (en) | Plant-based egg substitutes and methods of manufacture | |
| JP2021524738A (en) | Egg substitute mixture | |
| CA2897382C (en) | Multi-purpose ingredient for bakery and other products | |
| US11284637B2 (en) | Egg-free simulated egg food products | |
| US20120121758A1 (en) | Allergen-free compositions | |
| US20220312793A1 (en) | Methods of protein extraction and downstream processing of euglena | |
| US20240049755A1 (en) | Plant-based vegan simulated egg | |
| US20130040016A1 (en) | Allergen-free compositions | |
| WO2022195566A1 (en) | Dairy and meat analogues containing euglena-derived components | |
| CA2786392A1 (en) | Allergen-free compositions | |
| US20040156973A1 (en) | Food product | |
| US20070082110A1 (en) | Food product kit | |
| KR102258461B1 (en) | Ready-to-eat, gluten-free and ketogenic coconut meat-based cereal | |
| KR20240107998A (en) | A browning composition for food | |
| Ramey | x+ y= Dinner? | |
| HK1202230B (en) | Plant-based egg substitute and method of manufacture |
Legal Events
| Date | Code | Title | Description |
|---|---|---|---|
| FEPP | Fee payment procedure | Free format text:ENTITY STATUS SET TO UNDISCOUNTED (ORIGINAL EVENT CODE: BIG.); ENTITY STATUS OF PATENT OWNER: SMALL ENTITY | |
| FEPP | Fee payment procedure | Free format text:ENTITY STATUS SET TO SMALL (ORIGINAL EVENT CODE: SMAL); ENTITY STATUS OF PATENT OWNER: SMALL ENTITY | |
| STCF | Information on status: patent grant | Free format text:PATENTED CASE |